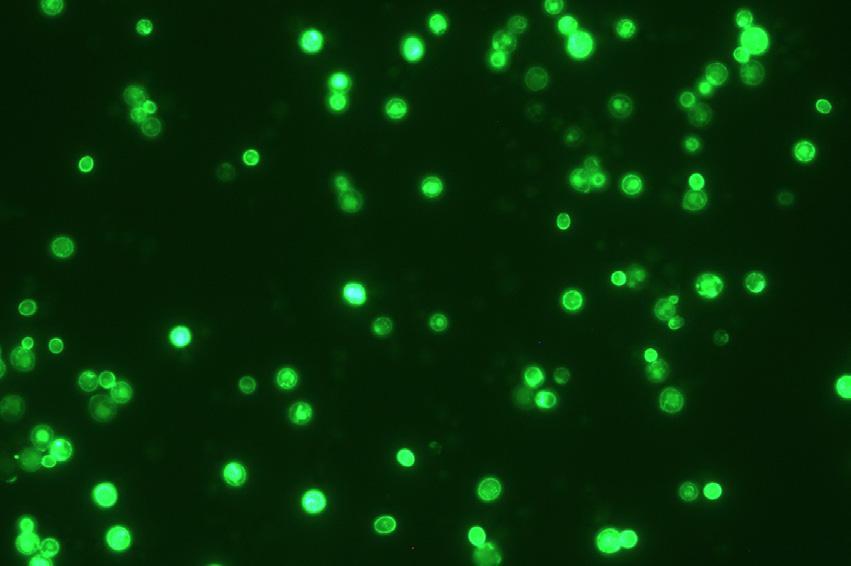

46 gruodis NR. 2024





![]()
46 gruodis NR. 2024






Žurnalo viršelyje matote cukraus gabalėlius. Nes šiame numeryje labai dažnai kalbame apie saldumą, desertus, cukrų, kekerą – šiais laikais nepopuliarius dalykus. Net siuntėme žurnalo autorę Agnę Dovydaitytę į Kėdainių „Dan Sukker - Nordic Sugar Kėdainiai“. Jos vizito išvados gerai atspindi redakcijos požiūrį: „Vyndariai į cukrų žiūri techniškai ir su juo susiduria kiekvieną dieną: derliaus neskins, kol vynuogės nesukaups pakankamo cukraus kiekio, nes iš cukraus mielės pagamins alkoholį, kuris vynuogių sultis paverčia vynu; papildomai pridedamas cukrus naudojamas putojančio vyno skonio balansui ir geriamumui pagerinti. Tokio šaltakraujiško mąstymo neretai pritrūksta mums, vartotojams, kai parduotuvių lentynose ieškome „Be cukraus“, „Be sulfitų“, „Veganams“, „Be gliuteno“ ir per mažai dėmesio skiriame tam, kas svarbiausia – skoniui, balansui, kokybei, istorijai.“ Tikiuosi, kad straipsniuose skaitydami, kaip kūrybingai, meistriškai cukrų naudoja vyndariai, konditeriai, išsklaidysite baimes ir išvengsite judėjimo „Cukrus = blogis“ pinklių.
Tuo labiau kad turime kuo džiaugtis – Lietuvoje galime oficialiai švęsti Nacionalinę vyno kultūros dieną. Ir turime kuo didžiuotis – kartu su Estija ir Latvija esame Europos vyno kultūros epicentre, nes čia šiandien dirba pasaulio ir Europos someljė čempionatų nugalėtojai ir prizininkai. Kaip visada, daug rašome apie viso pasaulio vynus. Tačiau ir Lietuvoje plečiasi vynuogynai. Todėl visai tikėtina, kad domėdamiesi tuo, kaip lietuviai tiek pasiekia someljė varžybose, kitų šalių vyno mėgėjai pasidomės ir kasmet gerėjančiais lietuviškais vynais.
Gero skaitymo!

Arūnas Starkus, Vyno žurnalo vyr. redaktorius

COPENHAGEN
SPARKLING TEA
LYSEGRØN
0% ABV



tik alkoholio verslo specialistams



2024 -ieji metai Lietuvos gastronomijai buvo kupini ne tik iššūkių, bet ir laimėjimų bei pasiekimų. Pirmą kartą šalies restoranus įvertino „Michelin“ gidas, po pertraukos atskleistas 30 geriausių restoranų reitingas, pirmą kartą Lietuvos restoranai buvo įvertinti „Falstaff“ gide, o metus vainikavo Lietuvai palankūs „Baltic Wine & Drinks Awards“ apdovanojimai. Visa tai padės gastronomijos mėgėjams ir svečiams rinktis, kur pietauti, vakarieniauti ir apsipirkti.


Gaspar’s 1 94/100
Nineteen18 2 95/100
DŽIAUGSMAS 3 91/100
VILA KOMODA 4 92/100
Fabrikėlis 5 Selected 89/100
Arrivee 7 Selected 90/100
Šturmų švyturys 8 84/100
Toda 9 89/100
Pas mus 10 90/100
Da Antonio 11 Selected 88/100
Pacai 12 Selected 88/100
Geriausias trumpojo vyno meniu
Geriausias vyno taurėmis meniu
Puikus šampano ir Portugalijos vyno asortimentas
Geriausias tauraus vyno meniu Lietuvoje
Geriausias prabangus restoranas vyno
mėgėjams Lietuvoje
Geriausias šampano meniu Lietuvoje
Geriausias austriško vyno meniu
Geriausias vidutinio ilgio vyno meniu
Geriausias putojančio vyno meniu
Geriausias naujoko prabangaus
restorano vyno meniu Lietuvoje
Specialus prizas už geros vertės vyno
meniu tarp prabangių restoranų Specialus prizas už vyno meniu dizainą
VIII VIETA Stilingiausias desertas Įtraukta į meniu
Baras
Geriausias taurių gėrimų ir kokteilių asortimentas Lietuvoje
Restoranas
Geriausias viešbučio restorano vyno meniu Vilniuje
II VIETA Įtraukta į meniu
V VIETA Lietuviškiausias desertas Įtrauktas į meniu
AMANDUS 13 Selected 89/100 VI VIETA Įtraukta į meniu
Geriausias vidutinio ilgio vyno meniu
Geriausias putojančio vyno meniu
HEJI 14 Selected 92/100
Geriausias vyno taurėmis meniu
Geriausias naujoko vyno meniu
Geriausias austriško vyno meniu

Elven 15 Selected 83/100 Įtraukta į meniu
Dine 16 Selected 90/100
Telegrafas 17 Selected 86/100
Saint Germain 18 85/100
Demo 19 91/100
DIA 20 Selected 81/100
Augustin 21 Selected 87/100
La Capital 22 81/100
Monai 23 Selected 88/100
Alba 24 88/100
Ertlio namas 25 Selected 84/100
Somm 26 Selected 84/100 Geriausias putojančio vyno meniu Geriausias austriško vyno meniu
PACHAMAMA DINNER CLUB 27 84/100
Momo grill 28 Selected 87/100
Numan 29 82/100
Protėviai 30 Selected 86/100
14 horses 86/100
Le Travi 80/100
Red Brick

Stikliai Selected 85/100
Farmer and the Ocean Selected 81/100
Monte Pacis Selected 82/100 Geriausias vidutinio ilgio vyno meniu
Arūno Oželio „O“ 93/100
Specialus prizas už gerą lietuviško vyno asortimentą
Geriausias naujokas tarp kasdienio maisto restoranų Baltijos šalyse
IV VIETA Publikos simpatija Įtraukta į meniu
Specialus prizas už konceptualiausią vyno meniu Baltijos šalyse Puikus vienuolynų ir lietuviško vaisių ir uogų vyno asortimentas Geriausias viešbučio restorano vyno meniu Baltijos šalyse
VII VIETA Desertas prie kavos Įtraukta į meniu
I VIETA Lengviausias derinys Įtraukta į meniu
III VIETA Geriausias vynas Įtraukta į meniu
Toli nuo klasikos 87/100
El Gato Negro 85/100
Monist 85/100
Narushi 85/100
Motif
Vištidė
Vyno vieta
Vyno klubas
The Hedonist
Gaston
Naked Noah
„Star Wine List“ auksinė žvaiždė
„Star Wine List“ sidabrinė žvaigždė
„Baltic Wine & Drinks Awards“ žvaigždė
„Michelin“ žvaigždė

Geriausias trumpasis vyno meniu
Geriausias naujoko vyno meniu
Geriausias trumpasis vyno meniu
Geriausias vyno taurėmis meniu
Michelin Bib Gourmand – geras kainos ir kokybės santykis
„Michelin Green star“ tvariems restoranams
„Selected“ – į „Michelin“ gidą atrinkti restoranai
Falstaff
Geriausias universalus vyno mažmenininkas Baltijos šalyse
Specialus prizas už tauraus vyno asortimentą dideliuose buteliuose
Specialus paminėjimas už gerą Šampanės ir kitų klasikinių regionų vyno asortimentą
Specialus prizas už natūralaus (neintervencinio) vyno įvairovę
Kiti „Falstaff 2024“ vertinimai: River Town (84/100), Brussels Mussels (83/100), Bizzare (82/100), Fisheria (82/100), Selfish Bistro (82/100), Sushi Masters (82/100), La Capital (81/100), Motif (81/100), Firenze (80/100), Ugruzina (80/100).
Kiti „Michelin selected“: Apvalaus stalo klubas, Stebuklai, Uoksas, Justa Pasta.
Sudarė Agnė Dovydaitytė


Martynas Pravilonis lapkričio 11-15 dienomis Belgrade
vykusiame ASI Geriausio Europos, Afrikos ir Artimųjų Rytų someljė čempionate iškovojo trečią vietą. Čempionu tapo estas Mikkas Parre, o vicečempionės titulas atiteko Prancūzijos atstovei Pascaline Lepeltier.

Tokio lygio varžybų finale Martynas Pravilonis varžėsi pirmą kartą. 2019 m. jis liko už finalo ribos, užėmęs ketvirtąją vietą pasaulio someljė čempionate Antverpene. Todėl trečia vieta yra puikus istorinis pasiekimas Lietuvos vyno bendruomenei. Martynas dirba „Heji“ restorane, dėsto Lietuvos someljė mokykloje ir rašo „Vyno žurnalui“. Jis baigęs WSET diplomo studijas ir ruošiasi someljė magistro egzaminui.
UŽDUOTYS NUO KETVIRTFINALIO IKI FINALO
Varžybose dalyvavo 41-os šalies atstovai. Po ketvirtfinalio varžytis liko tik 12. O finale savo gebėjimus ir žinias ant scenos liko demonstruoti vos 3 geriausi iš geriausių.
KETVIRTFINALIO UŽDUOTYS
Paragaukite ir atpažinkite 3 baltuosius vynus. Nurodykite kilmės šalį, regioną arba apeliaciją, vynuogių veislę bei derliaus metus. („Ried Renner Gruner Veltliner 2022“ iš „Schloss Gobelsburg“ vyninės, „Nanclares y Prieto Albarino 2022“ iš „Tempus Vivendi“, „Saint Peray Version Longue 2022“ iš „Francois Villard“ ūkio (‘Roussanne’, ‘Marsanne’))
Pateikite išsamų organoleptinį putojančio vyno aprašymą. (8 min.) („Recaredo Terrers Brut Nature Corpinat 2019“)
Teorinis testas: atsakykite į klausimus (28 psl. klausimų, 90 min.)
Praktinė užduotis: patiekite taurę „Cremant de Bourgogne“ svečiui, sėdinčiam vyno bare. (2 min.) Svarbu buvo pastebėti, jog šalia svečio gulėjo nedidelis meniu, kuriame buvo nurodyta, jog „dienos putojančio“ taurė yra 150 ml, tad ir teisėjai tikėjosi, kad bus patiektas būtent toks kiekis putojančio. Taip pat ant servanto buvo padėtas kamštis užkimšti buteliui po pilstymo svečiams. Juo reikėjo užkimšti butelį dedant atgal į kibirėlį.
PUSFINALIO UŽDUOTYS
Akloji degustacija
1.1. Pateikite išsamų organoleptinį 2 vynų apibūdinimą (žodžiu): „Canyon Road White Zinfandel 2022“ ir „Nicolas Renaud Clos des Grillons Tavel AOC 2020“. (8 min.)
1.2. Įvertinkite bei palyginkite šių vynų komercinį potencialą ir nurodykite jų tikslinę auditoriją. Teisėjai norėjo išgirsti kandidatų samprotavimus, kokiai vartotojų grupei kiekvienas vynas būtų labiau priimtinas, kokiame kontekste ir kur vienas ar kitas galėtų būti parduodamas bei patiekiamas. (3–4 min.)
1.3. Akloji alaus degustacija. Atpažinkite 4 alaus rūšis


(nurodykite tipą ir šalį) bei pateikite patiekimo rekomendacijas. Alus buvo juodose taurėse, taigi jo spalvos nesimatė. Teisėjai tikėjosi, jog kandidatai ne tik teisingai atpažins alų, bet ir pateiks tinkamų taurių, temperatūros bei patiekimo rekomendacijas. (Alus: pilsneris iš Serbijos, stautas iš Serbijos, rūgštusis alus su rūgščių vyšnių sultimis iš Belgijos, kvietinis iš Vokietijos.)
PRAKTINĖS UŽDUOTYS
Patiekite butelį oranžinio „Koshu“ vyno iš Japonijos 4 asmenims taip, kad jis būtų optimalios būklės vartojimui. (5 min.) Vienas butelis buvo smarkiai atšaldytas kibirėlyje ir pora butelių buvo šaldytuve 10 laipsnių temperatūros.
Teisėjai tikėjosi, jog kandidatai pasirinks mažiau atšaldytą vyną bei jį aeruos paaiškindami savo pasirinkimą.
Priimkite tiekėjo atvežtą vyno užsakymą bei sudėkite vyną į sandėlį (šaldytuvą). (3 min.) Buvo pristatyta dėžė „Blanc de Blancs“ šampano „Lallier“. Įteiktoje sąskaitoje buvo nurodytas „Brut“ šampanas bei neteisingai nurodyta pristatymo data. Teisėjai tikėjosi, jog kandidatai patikrins vynus bei dokumentą, pastebės klaidas ir jas pakomentuos. Tada pasirašys dokumentą bei atiduos jį kurjeriui. Šaldytuve jau buvo pridėta to paties šampano butelių. Reikėjo pastebėti, kad skyrėsi mielių pašalinimo (disgorgement) datos, tad dedant vynus į šaldytuvą reikėjo juos atskirti. Vyno ir maisto derinimo užduotis. Ji skambėjo taip: „Keičiasi viešbučio savininkų karta (tėvas perleidžia verslą savo dukrai) ir ta proga rengiamas pobūvis. Prašome pateikti vynų rekomendacijas degustaciniam meniu, prie kiekvieno patiekalo pasiūlant du vynus, nes dabartinis viešbučio savininkas yra tradicinių vynų mėgėjas, o dukra labiau mėgsta neįprastus, mažiau klasikinius vynus. Viso meniu (įskaitant vyną) kaina vienam asmeniui neturi viršyti 150 Eur.“ (7– 8 min.) Meniu sudarė tradiciniai regioninės virtuvės patiekalai, tad svarbu buvo ne tik parinkti tinkamą vyną, tačiau ir laikytis kainodaros apribojimo.
Meniu: krevetės puodelyje, galisijietiškas aštuonkojis, milanietiškas rizotas, kepti ėriuko šonkauliai su žolelėmis ir cukinijomis, saldus pyragas „Gibanica“.

FINALO UŽDUOTYS
Šis 3 svečių stalelis nori užsisakyti aperityvo: Austrijos „šampano“, šampano („Duval Leroy Fleur de Champagne Premier Cru“) ir „Junmai Daiginjo“ sakės. Buvo paprašyta paaiškinti, ar egzistuoja Kalifornijos „šampanas“. (8 min.)
Pateikite 2 raudonųjų vynų organoleptinį aprašymą, paaiškinkite, ką tie vynai turi bendro: „Masseto 2018“ ir „Massetino 2018“. (8 + 1 min.)
Atpažinkite 4 stipriuosius gėrimus. (3 min.) Paaiškėjus, kad tai 4 konjakai (visi 2020 m. gamybos „Cognac Hine“), reikėjo pasakyti, iš kurio subregiono yra kiekvienas.
Patiekite 8 svečiams Moldovos vyno. Aptarnaujant išaiškėjo, kad vienas svečias nori putojančios „Nigori“ sakės. (8 min.)
Ištaisykite klaidas vyno meniu. (4 min.)
Atpažinkite 5 gėrimus ir pakomentuokite jų gamybos būdą. Pasirodė, kad tai 5 vynai, pagaminti iš ‘Muscat’ vynuogių: prancūziškas „Domaine les Roumanis Muscat de Saint-Jean de Minervois Petit Grain“, itališkas „Planeta Passito di Noto“, „Klein Constantia Vin de Constance“ (PAR), „Vakakis Samos Vin de Liquer“ (Graikija), „Vinakoper Sladki Muskat“ (Slovėnija).
Atpažinkite nuotraukose 10 su vynu susijusių objektų. (20 sek. nuotraukai)
Agnė Dovydaitytė
Paskutinę 2020–2024 m. LR Seimo kadencijos dieną 76 parlamentarai balsavo už tai, kad Lietuvoje būtų minima Nacionalinė vyno kultūros diena. Niekas nebuvo prieš, susilaikė vienas. Kadencijos LR Seimo vicepirmininkas Vytautas Mitalas komentavo: „Tai mūsų paskutinis linkėjimas naujam LR Seimui ir priminimas, kad valstybėje gyvena skirtingos bendruomenės, kurias reikia gerbti, mylėti, o kartais tiesiog netrukdyti.“
SUMANYMAS KILO PARODOJE „VYNO DIENOS“
Lietuvos vyno mėgėjų, vyndarių, someljė, vyno ekspertų bendruomenė džiaugiasi ir sveikina buvusio LR Seimo vicepirmininko Vytauto Mitalo iniciatyvą į atmintinų dienų sąrašą įtraukti Nacionalinę vyno kultūros dieną, nors iki paskutinės minutės negalėjo patikėti, kad Seimas pritars šiai iniciatyvai.
Nacionalinės vyno kultūros dienos rinkimas prasidėjo tarptautinės vyno ir gėrimų parodos „Vyno dienos“ metu. Šių metų parodos šūkis „Balsuok už vyną“ buvo įgyvendintas kviečiant dalyvius išrinkti Nacionalinės vyno kultūros dienos datą. Dauguma balsavo už tai, kad Lietuvos vyno kultūrai svarbiausias pastarųjų metų įvykis buvo 2021 m. gruodžio 7 d. įvykęs Lietuvos pripažinimas Europos Sąjungos vynuogininkystės šalimi.
Parodos organizatariai Rasa ir Arūnas Starkai džiaugėsi, kad parodoje gimusi iniciatyva per tokį trumpą laiką pateko į oficialius kalendorius, ir tikisi, kad ją švęs visi vyndariai, mėgėjai, ekspertai, someljė, importuotojai. „Seimas vis dėlto turi klausytis žmonių ir atliepti jų poreikius. Vyno ekspertų, someljė ir vyndarių bendruomenė dažnai pasijusdavo kaip persona non grata valstybėje, kurioje galiojantys alkoholio įstatymai išsilavinusius ir kultūringus šių profesijų atstovus prilygindavo tiems, kurie veikia šešėlyje. Ši diena paskatins daugiau kalbėti apie tai, kuo skiriasi paprastas ir perteklinis alkoholio vartojimas nuo vyndarystės kaip amato ir vyno kultūros. „Kultūra“ yra esminis žodis, kurio dažnai nesupranta šią iniciaryvą kritikuojantys ir į kraštutinumus nueinantys komentatoriai,“ – kalbėjo visuomenės švietimu vyno srityje jau dvidešimtmetį užsiimantys Rasa ir Arūnas Starkai.
VYNUOGININKAI – GERBIAMI ŪKININKAI, O VYNUOGININKYSTĖ – OFICIALI ŽEMĖS ŪKIO SRITIS
Lietuvos vynuogininkų asociacijos prezidentas Ramūnas Pilvelis kartu su Žemės ūkio ministerija pusantrų metų dirbo, kad Lietuva būtų pripažinta vynuogininkystės šalimi ir galėtų gauti Europos Sąjungos paramą vynuogininkystei vystyti. Jam žinia, kad Nacionalinė vyno kultūros diena bus minima būtent gruodžio 7-ąją, buvo be galo maloni ir netikėta.
„Žemės ūkio ministerijos ir Europos Sąjungos parama skiriama nedidelei, bet augančiai Lietuvos vynuogininkų bendruomenei. Tačiau labiausiai ūkininkams reikia tikėjimo, kad vynuogės gali būti sėkmingai auginamos Lietuvoje (tai jau įrodo dešimtys sėkmingų vynuogininkų), ir pačių žmonių, valstybės tikėjimo, kad ši žemės ūkio sritis gali būti perspektyvi, padėti vystyti ne tik žemės ūkį, bet ir turizmą. Šios dienos paskelbimas būtent ir suteikė mums taip reikalingo tikėjimo ir pasitikėjimo. Dieną tikrai paminėsime ir jai artėjant skatinsime dar daugiau kalbėti apie vynuogininkams ir vyndariams svarbius klausimus, licencijas bei vyno kultūrą,“ – komentavo R. Pilvelis.
AUKŠTA VYNO KULTŪRA DIDINA VISOS LIETUVOS PATRAUKLUMĄ
Lietuvos someljė asociacijos prezidentas Arminas Darasevičius pastebi, kad vyno kultūra verta nacionalinės dienos statuso, nes ji susijusi su gastronomija, restoranais, taigi su visu svetingumo sektoriumi, kuris Lietuvoje yra privatus ir jame dirbantys žmonės nuoširdžiai stengiasi, kad Lietuva būtų patraukli tiek čia gyvenantiems, tiek užsienio svečiams. „Šaunu, kad iš LR Seimo pagaliau sulaukėme ne draudimų ir kritikos, o konstruktyvaus indėlio į šalies sėkmę. Tikimės, kad ir naujasis Seimas girdės šalies verslo ir gyventojų balsą.“





Šių metų Lietuvos someljė čempionate „Codorniu Zero Grand Prix“, vykusiame rugsėjo mėnesį, triumfavo „Vyno klube“ dirbantis ekspertas Janas Biazručka. Vicečempionu tapo Ignatijus Semionovas iš vyno baro „Somm“, o pirmą kartą varžybose dalyvavusi Oresta Jokūbauskaitė iš restorano „Pacai“ liko trečia.

NAUJAS VARŽYBŲ FORMATAS
Šiemet finalinė varžybų dalis vyko „Neringos“ restorane. Svečiai įsigijo bilietus ir vaišinosi vakariene stebėdami, kaip finalo dalyviai varžėsi net 11-oje rungčių: vakarienės dalyviams patiekė putojantį vyną, aeravo ir patiekė baltąjį vyną iš Portugalijos, o desertui dekantavo vintažinį portą. Be šių rungčių, finalininkai svečiams, besimėgaujantiems vakariene, turėjo pasiūlyti vynus, derančius prie vakarienės patiekalų, pataisyti klaidas vyno sąraše, atpažinti keturias skirtingas vyno ydas, demonstruoti savo pardavimo gebėjimus siūlant petnatą, aklai spėti keturis baltuosius vynus bei atsakyti į superklausimą.
Lietuvos someljė asociacijos prezidentas Arminas Darasevičius pabrėžia, kad pirmą kartą Lietuvos somėljė čempionatų istorijoje varžybų finalas vyko kartu su vakariene, o svečiai tiesiogiai įsitraukė į varžybas – juos aptarnavo finalo dalyviai. Toks finalas labai dinamiškas, varžybų dalyviai atlieka someljė pareigas – aptarnauja svečius. Visi keturi užduotis atlieka vienu metu. Tokios varžybos sukelia daug nuostabių emocijų ir atveria čempionatą platesniam žiūrovų ratui.
Someljė čempionatą nuo 2006 m. organizuoja Lietuvos someljė
Čempionato dalyviai
asociacija. Anot jos prezidento Armino Darasevičiaus, someljė darbas labai dinamiškas, todėl reikia nuolat mokytis: vyno pasaulis keičiasi, evoliucionuoja vartojimo įpročiai, į rinką ateina naujos vartotojų kartos. Varžybos – geriausias formatas gilinti žinias, tobulinti klasikinius aptarnavimo įgūdžius ir išmokti naujų. Šių metų finalo užduotis kūrė Lietuvos someljė čempionai Martynas Pravilonis, Narimantas Miežys, Arminas Darasevičius, Kamilė Bartusevičiūtė, vyno ekspertai Gintautas Jašinskas ir Arūnas Starkus. Vertinimo komisijoje buvo ir Estijos someljė asociacijos atstovė Ene Ojaveski, Latvijos someljė asociacijos atstovas Ivars Kaliniņš, taip pat vyno ekspertai iš Lietuvos: Rasa Starkus, Viktorija Pranevič, Tadas Abišala. Pusfinalyje varžybų dalyviai atliko teorinių žinių testą, dekantavo raudonąjį vyną, aklai degustavo bei aprašė du vynus ir bandė atspėti penkis gėrimus.
Be nugalėtojų trejeto, šiemet varžėsi Ernestas Sadauskas (restoranas „Pacai“), Miglė Zencevičiūtė (baras „Somm“), kuri, teisingiausiai atsakiusi į klausimus apie vandenį, gavo specialų vandens „Akvilė“ įsteigtą prizą, svečias iš Estijos Federicas Grassas bei finale besirungusi latvė Madara Greize-Kapzema, kuri pusfinalyje jau kelinti metai iš eilės geriausiai aklai degustuoja vyną.
PAGALIAU NEBE TREČIAS
Iš Baltarusijos kilęs Janas pirmąjį vyno butelį atkimšo dirbdamas restorane prieš šešerius metus. Lietuvoje gyvena jau treti metai, dirba prestižinėje vyno parduotuvėje, veda degustacijas ir gilina savo lietuvių kalbos žinias. Jo ankstesnių apdovanojimų sąraše – trečia vieta 2023 m. Lietuvos someljė čempionate, trečia vieta 2023 m. Baltijos someljė čempionate, trečia vieta 2020 m. Ukrainos someljė čempionate. Jis vienintelis Lietuvoje turi Tarptautinės someljė asociacijos (ASI) diplomą ir siekia magistro titulo. Paklausėme Jano, kaip jis ruošėsi varžyboms, kas lėmė sėkmę.
JANAS BIAZRUČKA
Kalbant apie Lietuvos someljė čempionatą, manau, kad verta pradėti nuo pasakojimo apie tai, kaip atrodė mano dienos ir savaitgalio dienotvarkė likus 3 mėnesiams iki čempionato. Kiekvieną rytą prieš pusryčius aklai degustuodavau stipriuosius gėrimus ir vyną. Pakeliui į darbą visada prisimindavau arba sužinodavau ką nors naujo. Pasidarau nedideles atmintines, kad geriau išsaugočiau informaciją. Visas mano butas apklijuotas ranka pieštais regionų, subzonų ir atskirų vynuogynų sklypų žemėlapiais. Galima sakyti, kad patekote į pamišusio žmogaus butą. Po darbo trumpai pailsėdavau ir vėl pasinerdavau į mokymąsi, kartojimą ir degustacijas. Savaitgalius leisdavau kavinėse skaitydamas istorijas apie gamintojus.
Esant tokiam tempui, labai svarbu išlaikyti psichologinį komfortą, todėl mintis išvalydavau plaukiodamas ir vaikščiodamas.
Visada sudėtinga nurodyti visus būtinus įgūdžius ir žinias, tačiau akivaizdu, kad labai svarbu gerai išmanyti vyną, viso pasaulio regionus, vynus ir gamintojus. Tiesą pasakius, vyno pasaulis yra begalinis, kartą į jį pasinėrus, neįmanoma išeiti. Ir tai yra žavu. Tą patį galima pasakyti apie stipriuosius gėrimus, alų ir sakę. Ir to negali ignoruoti, nes čempionato pirmame etape teko spėti alų.

Čempionato organizatoriai ir teisėjai
Kalbant apie aptarnavimą, neabejotinai svarbiausia yra svetingumas, draugiškumas, psichologija ir vaidyba. Techniniai įgūdžiai ir pasitikėjimas savimi taip pat labai svarbūs.
Didžiausias iššūkis čempionate man buvo išlaikyti ramybę pasirodant viešai. Ir man tai pavyko. Man labai patiko darbo restorane procesas. Finalas buvo fantastiškas ir kerintis, su tikrais svečiais, vakarienės aptarnavimu ir nuostabiomis užduotimis. Kadangi aš pasirodžiau pirmas, turėjau galimybę stebėti aukštą visų dalyvių lygį. Kiekvienas turėjo savitą stilių ir požiūrį į užduotis, ir kiekvienas buvo vertas pirmosios vietos.
Norėčiau padėkoti Lietuvos someljė asociacijai ir visiems organizatoriams bei partneriams už svarų indėlį į vyno kultūros plėtrą, someljė profesijos įvaizdžio ir standartų palaikymą šalyje ir tarp kaimyninių šalių. Baltijos šalyse dabar yra susibūrusi labai draugiška ir glaudi vyno profesionalų bendruomenė. To pasekmė – puikūs Estijos ir Lietuvos pasiekimai Europos ir pasaulio čempionatuose.
Pasiruošimas čempionatui padėjo lapkritį sėkmingai išlaikyti pažengusio (advanced) someljė egzaminą Someljė magistrų rūmuose. Tai neįtikėtinai sudėtingas egzaminas, trunkantis tris dienas ir apimantis išsamias teorines žinias, restoranų verslo išmanymą, „Michelin“ gido trijų žvaigždučių lygio aptarnavimą ir akląją degustaciją. Pastarasis elementas laikomas sunkiausiu, nes per 25 minutes reikia ne tik atlikti išsamią žodinę šešių vynų organoleptinę analizę, bet ir įvardyti, kas yra taurėje, nurodant derliaus metus, šalį, regioną, apeliaciją ir vynuogių veislę.
Tai vienas iš pagrindinių skirtumų nuo WSET diplomo studijų, kur per egzaminą nereikalaujama taip tiksliai nurodyti vyno kilmės. Kad išlaikytum, turi surinkti ne mažiau kaip 60 proc. taškų už kiekvieną elementą. Pasaulyje yra tik 480 pažengusių someljė, o Baltijos šalyse, kiek žinau, tik du.
Taip pat norėčiau padėkoti visiems draugams ir kolegoms, kurie mane palaikė šios sunkios kelionės metu.



Austrijos saldusis vynas


PArūnas Starkus
asaulyje vyninių, kurios darytų daugiau saldaus vyno nei sauso už Bordo ir Tokajaus ribų, liko vienetai. Todėl lankantis pas Gerhardą Kracherį neapleidžia nuostabos jausmas – jo ūkis Austrijos rytuose esančiame Illmitzo miestelyje yra saldaus vyno karalystė, kurioje kasmet į butelius išpilstoma per 20 skirtingų naujų saldžiųjų vynų, statinėse baigia bręsti dešimtys anksčiau pagamintų. Apie saldaus vyno rinkos traukimąsi čia nė nesusimąstai, nes po kiekvienos paragautos taurės norisi dėkoti didingajam kekeriniam puviniui ir žmogaus meistrystei.
Kracherių šeimoje saldų vyną daro dar tik trečia karta. Pokario metais šešiolikmetis Alois Kracheris Vyresnysis pradėjo nuo pusės hektaro vynuogyno – augino vynuoges ir jas parduodavo. Iš kaimynų supirkinėjo žemes, kuriose šie augino daržoves ir sodino vynmedžius.1959 metais padarė pirmąjį savo vyną. Senelis net nekalbėjo vokiškai. Tačiau sūnus Alois Jaunesnysis (Luis) mokėsi farmacijos, buvo išsilavinęs ir nuo 1991 metų kilstelėjo vyno kokybę, o drauge ir ūkio reputaciją iki garsiausių soternų, tokajų ar Mozelio saldžiųjų. Gerhardas paveldėjo ūkį 2007-aisiais po netikėtos tėvo mirties. Tuomet jis buvo vos 26-erių, baigęs ekonomikos mokyklą, o ne vyndarystę. Tačiau tai netrukdė jam šlovingai tęsti senelio ir tėvo pradėtą darbą. Pasidairykime po Illmitzo apylinkes ir vyninę, kartu paragaukime jo vynų.

Tamsaus smėlio dirvožemis dieną įkaista, tačiau naktį labai greitai atvėsta. Lyginant su žvirgždo dirvožemiu, vakare temperatūra čia žemesnė 4 °C.
„WEINLAUBENHOF KRACHER" VYNAS
White Spätlese 2022 Pinot Blanc, Chardonnay, Welschriesling
Rose Spätlese 2021 Zweigelt, Merlot
Rot Spätlese 2020
Auslese Cuvee 2022 Chardonnay, Welschriesling
Auslese Zweigelt 2022
DEGUSTACIJOS UŽRAŠAI


Noizydlio ežerui – per 10 tūkst. metų. Jis po truputį traukėsi. Ir daugelis vynuogynų auga buvusio ežero dugne. Todėl čia smėlingoje dirvoje daugybė mineralinių medžiagų ir druskų – labai gerai saldžiam vynui.
ĮVERTINIMAS
Gaivus, kvepiantis persikais ir kmynais. Iki 20 % kekerinių vynuogių. 101 g/l cukraus. 88
Kvepia braškių ledinukais, grieitinėlė, raugerškiais. Sukurti vyną kilo mintis JAV ragaujant „White Zinfandel“. 88
Kvepia aronijomis, trešnėmis, juntamas žemiškumas. Sukurtas Kinijos rinkai. Mėgstamas visur. 87
Kvepia citrinomis, persikais, šviežiais abrikosais, medingu melionu 30–50 % kekerinių vynuogių. 91
Kvepia aviečių ledinukais. Gaivus. 8–10 dienų laikytas su žievelėmis. 90
Auslese Traminer 2018 Rotter Traminer Kvepia apelsinais, mandarinais, džiovintais mangais. Mažiau rūgštus, labai kvapnus. 90
Auslese Muscat Ottonel 2021
Labai gėliškas, pusiau saldus, su pastebimu apelsinų žievelių karstelėjimu ir dūmų natomis. 90
DEGUSTACIJOS UŽRAŠAI
„WEINLAUBENHOF KRACHER" VYNAS
TBA Traminer no2 2020 Nouvelle Vague Kvepia džiovintais abrikosais, prieskoniais ir apelsinais. 180 g/l cukraus, 11 % alkoholio. 94
TBA Zweigelt 2020 Nouvelle Vague
Grande Cuvee 2020 Nouvelle Vague Chardonnay, Welschriesling
Kvepia braškių uogiene, raudonaisiais apelsinais, tabaku, sūrstelėjęs, vidutinio saldumo – 150 g/l cukraus. 93
Kvepia medumi ir džiovintų vaisių jūra. Itin harmoningas. Turintis sūrumo. „Chardonnay“ brandintas naujose ąžuolo statinėse, „Welschriesling“ – didelėse.
96
TBA Scheurebe no3 2020 Zwischen de Seen Kvepia tropiniais vaisiais, medumi. Kvapnus. Labai harmoningas. 96
TBA Rosen Muscateler no5 2020 Nouvelle Vague Penki šimtai rožinių niuansų nuo erškėtrožių iki Sudano rožių ir bulgariško rožių vandens. Dar kvepia braškių uogiėne su avietėmis. Labai saldus – 210 g/l cukraus. 95
TBA Welschriesling no6 2020 Zwischen de Seen Kvepia svarainiais. Saldus ir gaivus. Labai ilgai išliekančio poskonio. 300 g/l cukraus. 97
TBA Rosen Muskateler Nouvelle Vogue no2 L11A Kvepia šokoladu, kedrais, eukaliptais, čiobreliais. Turi šiek tiek taninų. Saldus, gaivus, harmoningas. 94
TBA Rosen Muskateler Zwischen den Seen no3 L11B Kvepia raudonomis uogomis, medumi, karamele, mėtomis, eukaliptais. Išraiškingas vynas. 95
TBA Muscat Ottonel no5 1998 Zwischen den Seen Kvepia apelsinų cukatais, juoda duona, karamele, kava, juodąja arbata. 200 g/l cukraus. 94
TBA Muscat Ottonel no5 2009 Zwischen den Seen Kvepia muskatais, ledinukais, bergamotėmis, rožėmis.
TBA Welschriesling 1981
TBA Chardonnay 2001
4,5% no12 2012

Senelio darytas. Rudas. Kvepia džiovintais abrikosais, slyviene, obuoliene su cinamonu, pienišku šokoladu, kava, raudonaisiais apelsinais. Subrendęs. Gaivus ir ilgai trunkančio skonio. 118 g/l cukraus. 12,7 % alkoholio. 99
Kvepia tabaku, citrusiniais vaisiais, kremiškas, sodraus skonio.
Dalinai fermentuota vynuogių misa. 390 g/l cukraus. Sūrus ir gaivus. Kvepia abrikosų džemu, citrinomis, apelsinais, riešutais, lydytu sviestu.

Tas pats vynas spontaninės fermentacijos ir su kultūrinėmis mielėmis.
Subrendęs, kvepiantis tabaku, atrodo saldesnis ir mažiau kompleksiškas. 4 mėn. fermentacija su kultūrinėmis mielėmis.
95+

Labiau oksiduotas, labiau kompleksiškas, poliruotas burnoje. 11 mėn. spontaninė fermentacija. Jei vynas brandinamas naujose ąžuolo statinaitėse, ant etiketės atsiranda užrašas „Nouvelle Vague“.

















Arūnas Starkus ir Paulius Kovas
Tęsiame straipsnių seriją apie Lietuvoje auginamas vynuogių veisles. Šį kartą eilė šalčiui ir ligoms atsparioms ‘Maréchal Foch’ ir ‘Léon Millot’. Vynuogės – panašios išvaizdos, vyne neretai maišomos, todėl su mūsų šalies vynuogininkais ragaujame jų padarytą vyną ir kalbame apie abi veisles kartu, norėdami išsiaiškinti, koks idealaus iš jų padaryto vyno skonis ir kokia vyndarystė joms labiausiai tinka.

KILMĖ IR AUGINIMO YPATUMAI
‘Léon Millot’ [leon mijo] – 1911 m. Kolmare (Elzasas) Eugene’o Kuhlmanno išvesta veislė, kurioje Vitis vinifera genai „praskiesti“ Vitis rupestris ir Vitis riparia genais. Tokio pat kryžminimo rezultatas yra ir ‘Maréchal Foch’ [marešal foš].
‘Léon Millot’ anksti išsprogsta ir anksti sunoksta. Atspari ligoms. Augi, todėl rekomenduojama formuoti ilgomis šakomis. Nuo 1921 m. Europoje jos augintos dėl spalvos, tačiau pastaruoju metu mėgstamos dėl atsparumo ligoms. Auginamos vėsiose Europos vietose, Šiaurės šalyse bei JAV Vidurio Rytuose: Ilinojaus, Ajovos, Nebraskos, Niujorko valstijose ir Naujojoje Škotijoje Kanadoje. Lietuvos vyndariai patvirtino, kad gali iššalti prie 28 °C šalčio.
‘Maréchal Foch’ atspari šalčiui (iki –33 °C), todėl auginama Kanadoje ir JAV Vidurio Rytuose ir Rytuose. Apie 12 ha auga Luaros slėnyje. Vynininkas Šarūnas Šalkauskas degustacijos metu papasakojo jam nutikusią istoriją, kai per derliaus skynimą Šampanėje jis buvo pavaišintas senu, dar vyndario senelio sodintų ‘Maréchal Foch‘ vynuogių vynu.
Šiemet (2024 m.) Lietuvoje šios vynuogės prinoko iki 24–26 °Brix saldumo, todėl kitąmet ragausime fiziologiškai sunokusių uogų vyną. O štai vėsesniais metais lieka daug rūgšties. Nors vynuogės prancūzams atrodo ankstyvos, Lietuvoje jos skinamos vėliausiai. Tačiau tuomet tenka jas saugoti nuo paukščių. Anot Dainiaus Noreikos, ‘Maréchal Foch‘ kekėje uogos noksta netolygiai, todėl naudinga jas ilgiau palaikyti ant krūmo.
Abi veislės atsparios grybelinėms ligoms, tačiau drėgnais metais būna šiek tiek paveiktos tikrosios miltligės. Bet ne tiek, kad reikėtų purkšti.
KOKS SKONIS
Vynuogės neturi Vitis lambrusca rūšiai būdingo vadinamojo foxy aromato. Prinokusio „Maréchal Foch“ tarp ragautų pavyzdžių buvo mažoka, nes 2020–2022 metais vynuogėms pritrūkdavo ilgesnio ir šiltesnio rudens. Todėl daugelyje vynų dominuoja raudonų uogų aromatas: vyšnių, aviečių, braškių uogienės, neretai ir daržovių natos. Vynai labai jautrūs ąžuolo panaudojimui. Ąžuolo taninai ima viršų prieš vynuogių taninus, dėl to kartais vynas karsteli. Įdomu, kad naudojant ilgesnio skrudinimo ąžuolo drožles formuojasi šokolado aromatas. Apskritai „Maréchal Foch“ vynas turi daugiau dūmo, žoliškų natų. O štai „Léon Millot“ dažniau skleidė gervuogių sirupo, vaivorų, našlaičių aromatą.
Neprinokus uogoms, abiejuose vynuose juntamas daržoviškas aromatas.
Sakoma, kad „Maréchal Foch“ vynas turi daugiau taninų. Tačiau ragaujant vynus to patvirtinti nepavyko – daugelis vynų turi nedaug švelnių taninų.
Bręsdamas vynas linkęs įgauti ruginės duonos aromato.
KAIP GAMINTI
Andrius Diliautas pabrėžė, kad šalčiui atsparios veislės turi penkiskart mažiau taninų. Jei vyndarys nusprendžia daryti natūraliai mažai taninų turintį vyną, galima ir karbomaceracija. Tokį vyną pateikė „Uždrausto sodo“ komanda. Sakoma, kad Ukrainoje naudojama termovinifikacija. Iš Lietuvoje gamintų geresnės struktūros buvo vynai, kurių maceracija truko bent 11–14 dienų. Mažoka praktinių duomenų, kas būtų, jei fermentacija vyktų raudonajam vynui palankesnėje 23–29 °C temperatūroje, nes dabar daugelis vyndarių fermentuoja neleisdami temperatūrai peržengti 20 °C ribos.
LÉON MILLOT
VYNAS DEGUSTACIJOS UŽRAŠAI
Ernesto Aušvico „Léon Millot 2023“, Kėdainių raj.
Evaldo Mikalajūno vynuogyno „Léon Millot 2023“, Klaipėdos raj.
Vytauto Greckio „Léon Millot 2023“, Vilniaus raj.
Artūro Kaminsko „Léon Millot 2020“
Mikalajūno vynuogyno „Léon Millot 2023“, Klaipėdos raj.
Ryškesnė nei vidutinė melsva rubino spalva. Puikus juodų uogų, mėlynių aromatas su ąžuolo prieskoniais. Primena vėsaus klimato „Pinot Noir“. Gerai subalansuotas, vos karsteli. 13 tūrio proc.
Gili melsva rubino spalva. Vidutinio intensyvumo gervuogių sirupo, juodų uogų aromatas. Mažiau nei vidutiniškai smulkios tekstūros taninų. Gausi, bet neįkyri rūgštis, kiek dominuojanti pabaigoje. Juntamas žematemperatūrės fermentacijos umamis. 13 tūrio proc.
Ryškesnė nei vidutinė melsva rubino spalva. Kvepia rašalu, našlaitėmis, bergamotėmis, lakiąja rūgštimi, mėsos prieskoniais. Burnoje nedaug taninų, lakiąją rūgštį atsveria truputis cukraus. Pabaigoje – kiek žaloki juodieji serbentai. 14 tūrio proc.
Vidutinio ryškumo granato spalva, pereinanti į ochros. Kvepia karamele, džiovintomis slyvomis. Karsteli, taninai vidutinio gausumo. Visiškai subrendęs, jau su daržoviškomis natomis. Bet dar visai geriamas. 13 tūrio proc.
Gili melsva rubino spalva. Žalumos, odos, fermos kvapas. Redukcija nemaloni, tačiau taninai šilkiniai. Mėtinis karstelėjimas. 13 tūrio proc. Butelis su yda.
VYNUOGYNE IR VYNINĖJE ĮVERTINIMAS BALAIS
Priesmėlyje augantys 4 m. vynmedžiai. Eilių kryptis –šiaurė–pietūs. Netręšiama, nelaistoma. Skinta spalio 17 d. (priešpilnis). 22 °Brix. Maceracija – 2 sav. Naudotos ąžuolo drožlės – 2 mėn. Likutinio cukraus – 5 g/l.
Molio dirvožemyje augantys 5 metų vynmedžiai. 24 °Brix, skinta rugsėjo 29 d. Maceracija – 11 d.
Priemolyje augantys 4 m. vynmedžiai. Skinta spalio 1 d. 23,5 °Brix. Maceracija – 5 d. Prancūziško ąžuolo drožlės. Nesulfituotas fermentacijos metu.
Smėlyje augantys 5 m. vynmedžiai. Skinta rugsėjo 29 d. 22 °Brix. Maceracija – 6 d.
Molio dirvožemyje augantys 5 m. vynmedžiai. 22 °Brix, skinta spalio 8 d. Maceracija – 14 d. Mielės „La Vin“. Vyndarys mano, kad nepavyko malolaktinė fermentacija.
87
86
84
83


MIŠINIAI: ROŽINIS IR RAUDONIEJI
VYNAS DEGUSTACIJOS UŽRAŠAI
Šarūno Šalkausko rožinis „Léon Millot ir Maréchal Foch 2023“
Dainiaus Noreikos „Léon Millot ir Maréchal Foch 2022“, Vilnius
Dainiaus Noreikos „Léon Millot ir Cabernet Cantor 2021“, Vilnius
Dariaus Valaičio „Maréchal Foch ir Léon Millot 2023“
Dainiaus Noreikos „Léon Millot ir Maréchal Foch 2023“, Vilnius
Blyški rubino spalva. Vidutinio intensyvumo žemuogių, braškių, aviečių, ledinukų aromatas. Kiek žemiškas burnoje, sausas, pabaiga vos mėtinė. 12,6 tūrio proc. 50 % MF, 50 % LM.
Vidutinio ryškumo rubino spalva, pereinanti į granato. Kvepia aviečių uogiene, erškėtrožėmis. Malonus, kitoniškas, rytietiškas aromatas. Sausas su vos saldumo, kuris gerai atsveria gaivią obuolinę rūgštį. Vidutinio svarumo. Dėl saldumo ir vaisių gana ilgai išliekantis skonis. Lengvas vynas. 13 tūrio proc. 50 % LM, 40 % MF, 10 % kitos.
Vidutinio ryškumo rubino spalva. Kvepia ąžuolo prieskoniais, raudonomis uogomis, vos oksiduotas. Burnoje natūralistiškai raugintakopūstasunkiškas, su pomidorais, alyvuogėmis. 12,5 tūrio proc. 70 % LM, 30 % CC.
Vidutinio ryškumo rubino spalva. Intensyvus raudonų uogų, vaivorų, gailių aromatas. Labai daug rūgšties, negausūs švelnūs taninai. Vaisiškas su žalumo pojūčiu. 11 tūrio proc. 80 % MF, 20 % LM.
Ryškesnė nei vidutinė rubino spalva. Saldus vytintų vyšnių aromatas, oksidacija su juodos duonos, odos natomis. Nedaug taninų. Yra sūrumo burnoje. 13 tūrio proc.
40 % LM, 60 % MF.
(Iš kairės) Domas Burnickis, Paulius Kovas, Deivydas Zaikovskis, Karolina Buivydaitė, Karolis Dvylys (sėdi aukščiau), Vytautas Greckis, Evaldas Mikalajūnas, Andrius Diliautas, Domas Vrubliauskas (sėdi aukščiau), Rasa Šoliūnė, Šarūnas Šalkauskas (sėdi aukščiau), Ernestas Aušvicas, Dainius Noreika, Sergejus Ignatjevas, Arūnas Starkus
VYNUOGYNE IR VYNINĖJE
ĮVERTINIMAS BALAIS
Priemolyje, molyje augantys 5 m. vynmedžiai. Skinta rugsėjo 24 d. 24 °Brix. Be maceracijos. 85
Juodžemyje augantys 7 m. vynmedžiai. Skinta spalio 19 d. 17 °Brix. Maceracija – 2 sav. Likutinio cukraus – 12 g/l.
88
Juodžemyje augantys 6 m. vynmedžiai. Skinta spalio 10–17 d. 19 °Brix. Šaptalizuotas. Maceracija – 2 sav. 86
Priesmėlyje augantys 4 m. vynmedžiai. Skinta spalio 1 d. 20 °Brix. Maceracija – 10 d. Likutinio cukraus – 4 g/l. 3 mėn. ąžuolo. Mielės „Lalvin71B“, mažinančios rūgštį.
Juodžemyje augančios 8 m. vynuogės. Skinta spalio 10 d. 16 °Brix. Šaptalizuotas. Maceracija – 2 sav. Likutinio cukraus – 5 g/l.
86
83
Nepanaudojus sulfitų vynai gana sparčiai oksiduojasi, atsiranda etilo acetato, acto aromatų.
Truputis likutinio cukraus netrukdo balansui. Dėl gausios rūgšties įdomiai atrodė spontaninės fermentacijos vynai. Keli vynai, kuriuose rūgšties mažinta pasitelkus specialias mieles arba malolaktinį virsmą, nepasižymėjo geru balansu, turėjo nepageidaujamų aromatų.
KAS GERIAU – LM AR MF?
Daryti reikšmingas išvadas iš pirmųjų vynų dar anksti. Tačiau jau dabar aišku, kad šaltį geriau atlaiko ‘Léon Millot’, jų vynai degustacijoje pelnė aukštesnius balus, kaip ir mišiniai su šiomis vynuogėmis. Geriausiai įvertintuose Ernesto Aušvico ir Evaldo Mikalajūno vynuose derėjo juodos uogos, gaivi rūgštis ir negausūs, bet smulkios tekstūros taninai.
2023 metų derliaus „Maréchal Foch“ tebuvo vienas – Domo Vrubliausko vynas su 14 tūrio proc. alkoholio ir gerokai sumažėjusia rūgštimi. O senesni vynai balus rinko dėl brandos, saldumo, ąžuolo pjuvenų ar statinių panaudojimo. Norint įvertinti šių vynuogių potencialą, reiktų sulaukti daug žadančio 2024 m. derliaus vyno.
VYNAS DEGUSTACIJOS UŽRAŠAI
Vaidoto Pečiulio „Maréchal Foch 2022“
Ernesto Aušvico „Maréchal Foch 2018“, Kauno raj.
Domo Vrubliausko „Maréchal Foch 2023“, Kaunas
Andriaus Diliauto
„Maréchal Foch 2020“
Sergejaus Ignatjevo 2020
Vidutinio ryškumo rubino spalva. Intensyvus vyšnių, vanilės, braškių uogienės aromatas, su vos juntama oksidacija, primenančia konjaką. Daug skanios rūgšties, geras balansas. 9 tūrio proc. 90 % MF, 10 % – kitos.
Vidutinio ryškumo granato spalva. Brandos aromatai – riešutų, džiovintų figų. Saldi pirmoji ataka. 13,5 tūrio proc.
Gili melsva rubino spalva. Nedaug rūgšties, atrodo labai prinokęs ir besioksiduojantis, su juodos duonos natomis. Šokoladiškas. 14,16 tūrio proc.
Vidutinio ryškumo rubino spalva su vandeningu krašteliu. Švarus raudonų uogų aromatas su prieskoniais ir šokoladu. Karsteli ąžuolo taninai.
Blyški granato spalva. Aromatai vystosi link žemuogių ir žolelių, truputį daržoviškas. Lengvas, daug taninų.
Uždraustas sodas „Maréchal Foch 2020“ Vidutinio ryškumo rubino spalva. Kvepia raudonomis uogomis, žemiškas. Sausas. 11,5 tūrio proc.
Winnica Zagardle „Maréchal Foch 2019“
Karolio Dvylio „Maréchal Foch 2023“
Uždraustas sodas
„Maréchal Foch 2020“ Karbomaceracija
1 m. vynmedžių derlius. Skinta spalio pradžioje. 18 °Brix. Spontaninė fermentacija. Maceracija – 2 sav. Stipraus skrudinimo ąžuolo drožlės.
Dėl vynuogių veislės tik spėjama, nes tai 30 m. vynmedis, nuo kurio nuskinama 50 kg uogų. Gali būti ir „Léon Millot“. 20,5 °Brix. Maceracija – 12 d.
Priemolyje augantys 4 m. vynmedžiai. Skinta spalio 13 d . 24,7 °Brix. Maceracija – 10 d.
Molingas dirvožemis, 10–15 m. vynmedžiai. Skinta rugsėjo pab.–spalio pr. 22 °Brix. Ąžuolo drožlės.
88
87
86
85
Lenkijoje, Torūnėje, pirktos vynuogės. 18,5 °Brix. Maceracija – 6 d. Rūgštį mažinančios mielės. 84
Daržoviška branda su vanile, tabaku. Šilkinis, prieskoniškas. Taninai tik ąžuolo. Pastovėjęs atsigavo. 13 tūrio proc. 16 mėn. brandintas ąžuolo statinėje.
Gili melsva rubino spalva. Besioksiduojantis, su lakiąja rūgštimi ir pjaustytais obuoliais. Burnoje žemiškas, besioksiduojantis, su ruginės duonos natomis. Daug rūgšties, vidutinio gausumo taninai. 12 tūrio proc.
Vidutinio ryškumo rubino spalva. Kvepia raudonomis uogomis, žemuogėmis, daržovėmis. Nelabai nokus, bet gaivus, skanus. 11,5 tūrio proc.
Arlie „Nudge Dessert Wine 2018“, Oregonas Brandus, kaip vintažinis portas: džiovintos slyvos, melasa, tabakas. Tankūs taninai, pastiprintas, saldus. 16,1 tūrio proc.
84
4 m. vynmedžiai. Skinta rugsėjo 16 d. 21 °Brix. Maceracija –7 d. Nesulfituotas. 83
Lenkijoje, Torūnėje, pirktos vynuogės. 18,5 °Brix. Karbomaceracija – 10 d., po to maceracija – 6 d. Rūgštį mažinančios mielės.
’Marechal Fosh’. 3 metus brandintas ąžuolo statinėse. 104 g/l cukraus.
83
Nuo 2011-ųjų, kai Lietuvoje buvo suteikta pirmoji vyno gamybos licencija, šalyje atsirado dar bent 14 licencijuotų vyndarių. Licencijos gavimas – tai didelis žingsnis, kurį pasiryžta žengti vienetai iš šimtų šalyje vyną savo reikmėms gaminančių vyndarių mėgėjų.
Nepaisant to, kad Lietuvoje veikia net dvi vyndarių asociacijos, viena Vynuogių augintojų asociacija, viena Mažųjų vyndarių asociacija ir aibė bendruomenių ir būrelių, iki Lenkijos mums dar toli. Ten jau susiformavę vyno regionai, leidžiamos knygos, žemėlapiai, apie Lenkijos vyndarystę rašo užsienio spauda.
Nenorime atsilikti ir lėtai, bet užtikrintai judame į priekį. Kol Vynuogių augintojų asociacija su jos prezidentu Ramūnu Pilveliu rengia be galo svarbų Lietuvos vynuogynų žemėlapį, „Vyno
žurnalas“ kartu su oficialia Lietuvos turizmo agentūra „Lithuania Travel“ pasiryžo sudaryti Lietuvos vyno turizmo žemėlapį –pirmąjį tokį Lietuvoje ir drauge tęstinį projektą, kuris pildomas, atnaujinamas ir aktualus ne tik vietiniams Lietuvos keliautojams, bet ir turistams iš užsienio. Jį bus galima rasti ir „Vyno žurnalo“ interneto svetainėje.
Žemėlapis – tai ir puiki paskata tobulėti ir plėsti savo paslaugas patiems vyndariams. Jame šiuo metu pažymėjome licencijuotus mažuosius vyndarius ir tikimės, kad tokių ateityje bus daugiau. Taip pat žemėlapyje galima lengvai pamatyti, kas kokį vyną gamina, kas šalia vyninės užsiima kaimo turizmu (kavinės, apgyvendinimas), kas gamina ne tik vyną, bet ir distiliatus ir pan.
ŽEMĖLAPYJE PAŽYMĖTOS VYNINĖS
„Česlovo vynas“ – Virkytų k. 1, Šilutės r. „Gintaro Sino“ – Juodalaukių k. 12, Zarasų r.
„Kidulių vynas“ – Sodų g. 26, Kidulių k., Šakių r.
„Šušvės midus“ – Plinkaigalio g. 18, Plinkaigalio k., Kėdainių r. „Mėmelio vynas“ – Pjaulių g. 16, Pangesų k., Klaipėdos r.
„Roksala“ – Taručių k. 8, Rokiškio r.
„Šv. Vincento vyninė“ – Maironio g. 36, Joniškėlio k. Pasvalio r. „Prūsijos vynas“ – Atgimimo g. 21, Kukorų k., Saugų apylinkė, Šilutės r. „Skonis ir menas“ – Veiviržėnų g. 41, Švėkšna, Šilutės r. „Saulės midus“ – Švedės g. 53, Ginkūnų k., Ginkūnų sen., Šiaulių r.
„Vyno kerai“ – Vyčio g. 1, Kaunas
„Geri metai“ – Kun. Antonijaus Dzekano g. 1, Ponasų k., Sužionių sen., Vilniaus r. „Anykščių vynas“ – Dariaus ir Girėno g. 8, Anykščiai Ilzenbergo dvaro vyninė – Ilzenbergo k. 4, Juodupės sen., Rokiškio raj. „Miella“ vyninė – Kauno g. 48, Alytaus k., Alytaus r. „Pakruojo vynas“ – Ramytės g. 8, Klovainių mstl., Pakruojo r.
ILZENBERGO




SAULĖS MIDUS ŠV. VINCENTO VYNINĖ

vynuogių vynas vaisių, uogų vynas
distiliatai midus vyksta degustacijos (būtina rezervacija)
netoliese yra vynuogynas / uogynas / bitynai galima aplankyti vyninę ir pamatyti gamybos procesą
galima nakvynė yra kavinė
Vos kelių arų „Uždraustame sode“ Molėtų rajone Domas Burnickis, Deividas Zaikovskis ir Karolina Buivydaitė užkūrė vyno dirbtuves ir mokslinių tyrimų stotį. Beveik viską daro savo rankomis – nuo vynuogyno iki vyninės įrangos ir programavimo, eksperimentuoja su kultūrinėmis mielėmis, spontanine fermentacija, labai mažais sulfitų kiekiais, malolaktiniu virsmu, karbomaceracija, putojančio vyno gamyba. Tyrimus apibendrinančius Karolinos straipsnius spausdiname „Vyno žurnale“. Todėl šį kartą norime priminti, kad jie Lietuvoje augina iš Vengrijos atsivežtas veisles ir padaro vyno iš vengriškų vynuogių. Kodėl taip yra, pasakoja Karolina, Domas ir Deividas:
„Grįždami iš vieno edukacinio renginio per Vengriją, paragavome raudonojo vyno, kuris pakeitė mūsų gyvenimą. Tai galėjo įvykti bet kur, bet kurioje kitoje Europos vietoje. Tačiau šįkart nutiko Vengrijoje, į pietus nuo Budapešto esančiame mažame kaimelyje, kurio žmonės augina vynuogynus aplink architektūros paveldo statusą turinčius kelių šimtų metų senumo vyno rūsius šiaudiniais stogais. Tai buvo otelas – raudonasis vynas su svaigiu atpažįstamu žemuogių aromatu. Vynu tuo metu nesidomėjome, net negėrėme. Tačiau po to vakaro viskas sukasi apie vyną. Iš ‘Othello’ darome savo putojantį rožinį petnatą „Pykštukas“, kuriame taip pat norime pajusti žemuoges.“
2023–2024 M. LSA LIETUVIŠKO VYNO ČEMPIONATE APDOVANOTI „UŽDRAUSTO SODO“ VYNAI:
„Pykštukas 2023“ – geriausias putojantis vynuogių vynas ir bronzos medalis;
„Baltas 2023“ (L’Acadie Blanc – 23 %; Johanniter – 16 %; St. Pepin – 15 %; Prairie Star – 15 %; Varduva – 10 %; Itasca –9 %; 101814 – 6 %; Prie Blanc – 6 %) – sidabro medalis; „Cserszegi Fuszeres 2023“ – bronzos medalis:
„Varduva 1 2022“ – sidabro medalis;
„Varduva 2 2022“ – sidabro medalis; „Varduva 3 2022“ – bronzos medalis; „Varduva 4 2022“ – bronzos medalis; „Monika 2022“ – bronzos medalis.
2024 M. LSA LIETUVOS VYNO ČEMPIONATE NEKONKURSINĖJE PROGRAMOJE IŠ VENGRIŠKŲ VYNUOGIŲ PADARYTI VYNAI ĮVERTINTI:
„Welschriesling 2022“ – aukso medaliu, „Blaufrankisch 2022“ – bronzos medaliu.







Vyno kalba
Ieva Elvyra Kazakevičiūtė
Britų vyno kritikė ir rašytoja Jancis Robinson kviečia trumpam prisiminti visame pasaulyje mėgstamas kulinarines TV laidas ir klausia: ar neatrodo, kad nykiausia jų dalis –patiekalų vertinimas, kai net ir iškalbingiausių teisėjų žodynas staiga sumąžta?
Rasti pakankamai žodžių skoniui ir kvapui – sunku. „Mes vartojame turtingą žodyną apibūdinti vizualinėms bei garsinėms patirtims, bet pritrūkstame žodžių nusakyti kvapui ir skoniui,“ – teigia maisto ekspertas ir rašytojas Haroldas McGee. Nobelio premijos laureatas, elgsenos ekonomikos specialistas dr. Richardas H. Thaleris palaikė idėją, kad mūsų verbalinė kalba yra per skurdi perteikti vyno subtilybėms ir netgi siūlė žodžius pakeisti vizualiąja medžiaga – diagramomis, kurios tiksliau pavaizduotų vyno savybes.
Tačiau šiame straipsnyje apsiribosiu verbaline kalba ir kelsiu du klausimus: ar gali pasaulyje egzistuoti tik viena vyno kalba ir ar vyno profesionalai moka ją išversti ir susikalbėti su likusiu pasauliu?
ANKSTYVOJI VYNO KALBA
Pirmieji vyno paminėjimai rašytiniuose šaltiniuose užfiksuoti šumerų ir Mesopotamijos laikais, o pirmieji vyno apibūdinimai – saldus ir raudonas – senovės Egipte. Randamuose vyno aprašuose dažniau nusakomas ne vyno skonis, o su juo susijusios emocijos. Romos imperijoje vynas apibūdinamas kaip „ugningas“, greičiausiai turint mintyje šildantį alkoholio efektą, taip pat vadintas džiaugsmo šaltiniu ar vaistu nuo gyvenimo negandų. Poetas Horacijus vyno gėrimą vertino kaip emocinį patyrimą bei nagrinėjo vyno įtaką kūrybingumui ir laimei. Suprantu, kad tokios istorinės įžangos gali atrodyti labiau kaip būtinas higieninis elementas, tačiau prašau kantrybės – prie šių vyno komunikacijos būdų senovės civilizacijose dar grįšime.
Ilgą laiką vyno kalba nesivystė. Tačiau X–XV a. į vyndarystę aktyviai paniro Prancūzijos vienuoliai cistersai. Pradėję stebėti ir išsamiai aprašyti procesus vynuogyne, jie pirmieji realiai įvertino ir žodžiais apibrėžė terroir įtaką; be to, suskirstę vynuogyno plotelius pagal kokybę, padėjo pamatus vėlesnei Premier Cru bei Grand Cru sistemai bei apeliacijoms.
Pirmaisiais esminiais žingsniais formalizuojant vyno kalbą laikoma 1855-ųjų Bordo vyno klasifikacija bei 1935 m. Prancūzijoje sukurta AOC ( Appellation d’Origine Contrôlée ) sistema. Iškilo poreikis standartizuoti vyno terminus, apibrėžiančius vyno regionus, vynuogių veisles bei vyno gamybos procesus. Nors skamba kaip sausoka teisinė užduotis, tačiau būtent kalbos standartizavimas susiejo vyno gamybos ir jo kokybės terminolo -
giją bei vyno gamybos žingsnius ir jų įtaką galutiniam rezultatui butelyje – apie tai visi mokomės ir šiandien.
Tačiau iki tikro susikalbėjimo vyno pasaulyje trūko dar kelių žingsnių. Skonio jutimas ir vertinimas gana subjektyvus dalykas, tad vyno pasauliui reikėjo susitarti, kas yra kas. Nesant vienos sistemos, net ir profesionalai apie tuos pačius vynus kalbėjo labai skirtingais žodžiais, o patys vyno apibūdinimai skambėjo panašiau į Horacijaus poeziją nei į informaciją vartotojui.
MODERNIOSIOS VYNO KALBOS KŪRIMAS
Tokią nesusikalbėjimo problemą XX a. pabaigoje iškėlė Kalifornijos universitete Deivise dirbusi sensorinės chemijos daktarė Ann C. Noble. Dirbdama su sensorine maisto bei gėrimų analize ji greitai pastebėjo vyno kalbos ribotumą, kadangi tuo metu populiarūs apibūdinimai, kaip „subalansuotas“, „elegantiškas“ ar „harmoningas“, nesuteikdavo jokios informacijos apie gėrimo skonį. Dr. A. C. Noble projekto tikslas buvo susieti kiekvieną vyndarystės žingsnį su konkrečiais galutinio produkto aromatais: tokios žinios buvo svarbios tiek vyndariams (siekiant paryškinti konkrečius vyno aromatus ar jų išvengti), tiek ir likusiam vyno pasauliui (siekiant susikalbėti tarpusavyje). Kartu su savo studentais bei Amerikos enologų ir vynuogininkų bendruomene 1984 m. A. C. Noble sukūrė „Aromatų ratą“ ( Aroma Wheel ), kuriame pirmą kartą apibrėžti ir suskirstyti konkretūs vyne užuodžiami aromatai, taip palengvinant vyno apibūdinimą. Pirmą kartą sutarta, jog žoliški, daržoviniai aromatai gali būti išskaidyti į šviežius (žolė, žalieji pipirai, eukaliptai, mėtos) ir džiovintus (šienas, arbata, tabakas); vaisiškumas gali būti uogiškas arba tropinių vaisių ir t. t.
Tuo metu šis suskirstymas buvo detalesnis net už tai, kas buvo dėstoma britų „Wine & Spirit Education Trust“ (WSET),

Autorius: Ann C. Noble , University of California, Davis. Iš anglų kalbos išversta Lietuvos someljė mokykloje
įkurtame 1969 m. Tačiau būtent mokymo institucijos, kaip WSET, Vyno magistrų institutas (Institute of Masters of Wine) bei Someljė magistrų rūmai (Court of Master Sommeliers), nuveikė daugiausiai formalizuojant skonio apibūdinimus, pavyzdžiui, rūgštį ar taninus. Londone įsikūrusių institucijų kursai bei sertifikavimas ilgainiui išplito visame pasaulyje, o drauge ir jų vartojama vyno terminologija.
„METAS DEKOLONIZUOTI VYNĄ“
Didžiojoje Britanijoje sukurtų studijų plėtra prisidėjo prie vienos dažniausiai aptarinėjamų problemų vyno pasaulyje – eurocentristinės vyno kalbos susiformavimo. Mums Lietuvoje pasisekė – čia klimatas ir gamtos gėrybės yra gana artimos Anglijai, todėl ir ten suformuota vyno kalba mums yra artima: „Sauvignon Blanc“ vyne ieškome agrastų, o šampane – sviestiškumo.
Tačiau vyną ragaujame ir apie jį kalbame ne tik Europoje. Susipažinkime su vyno lingviste Alice Achayo, užaugusia Rytų
Afrikoje. Emigravusi į JAV, A. Achayo pastebėjo, kad kasdieniai jos namų vaisiai – mangai, papajos, gvajavos ar pasifloros –europiečių vyno kalboje virto „egzotiniais vaisiais“. Viename interviu ji iškėlė europiečiui kone juokingai skambantį retorinį klausimą: „O kas iš mūsų apskritai yra ragavęs agrastų?“ Kitas jos pavyzdys – obuoliai ir mangai. Nors europiečiai dažnai atskiria vyne juntamą žalių obuolių aromatą nuo raudonų, tačiau mangai visada yra tiesiog mangai, nepaisant to, kad dalis vyną ragaujančių žmonių užaugo valgydami bent penkias skirtingas mangų rūšis.
Panašiai svarsto ir vyno someljė bei rašytojas Miguelis de Leonas, užaugęs Filipinuose: „Pradėjau savo aštuonių savaičių studijas (WSET – aut. past.). Jų metu „Savennières“ vynas man sukėlė duonmedžio aromatais apgaubtus prisiminimus iš vaikystės; paragavęs „Cabernet Franc“, prisiminiau dienas, kai mažas pirkdavau tamarindų saldainius. Tačiau atsikrausčius į JAV joks dėstytojas per visą studijų programą nesupranta, ką bandau pasakyti, ir mano atsakymai laikomi neteisingais. Jaučiuosi taip,
tarsi mano gyvenimo patirtis būtų nurašyta. Nors dėstytojai pataria „pasitikėti savo palete“, tačiau pasitikėdamas savąja, egzamino neišlaikysiu.“ M. de Leono publikuotas straipsnis „Laikas dekolonizuoti vyną“ sulaukė daug atgarsių tarp vyno specialistų už eurocentristinio vyno pasaulio ribų. Liūdna ironija: dažnai sakoma, kad vynas turėtų vienyti žmones, kurti malonias bendras patirtis, tačiau į dalies žmonių patirtis neatsižvelgiama, ir taip nutinka būtent dėl žodžių, kurie nusistovėjo vyno žodyne. Azijos vyno žodyno poreikis girdimas ir plačiau. Pirmoji Azijos vyno magistrė dr. Jeannie Cho Lee rašydama apie daliai vyno vartotojų primetamą nesuprantamą vyno kalbą vadina tai „lingvistiniu imperializmu“. Ji pateikia pavyzdį: tipiškas „Cabernet Sauvignon“ apibūdinimas – juodieji serbentai, kurių aromato ekvivalentas Azijoje yra raudonosios datulės („paprastasis zizifas“, pasak VLKK). „Sykį Honkonge vyno mokslų studento paklausiau, kiek kartų jis yra valgęs juodųjų serbentų. Jis atsakė, jog niekada. Tačiau raudonąsias datules jis valgo kas savaitę. O kodėl, kalbėdami apie minerališkumą vyne, negalime minėti jūrų dumblių? Juos, įvairiai paruoštus, valgome nuolat, ir tai labai praplėstų žodyną, kalbant tiek apie „Muscadet“, tiek apie šabli, tiek apie „Pinot Grigio“.“
Maisto ir vyno mokykla Ningsios universitete Kinijoje 2022 m. atliko tyrimą apie knygoje „Le Nez Du Vin“ (pranc. „Vyno kvapas“) minimų aromatų atpažįstamumą Kinijoje. Tyrime dalyvavo 150 išsilavinimo vyno srityje neturinčių Kinijos piliečių nuo 18 iki 30 metų, kurie nebuvo išvykę iš šalies. Tarp visai nepažįstamų aromatų dažniausiai buvo minimos juodųjų serbentų šakelės, svarainiai, liepžiedžiai, čiobreliai, šafranas. 22 universiteto atstovams buvo duota užduotis surasti vietinius aromatų atitikmenis, ir, pavyzdžiui, juodųjų serbentų ekvivalentu išrinkta japoninės lokvos pasta. Skamba nepažįstamai ir egzotiškai?
Taigi. Lygiai taip pat, kaip ir juodieji serbentai Kinijoje, bet tai nereiškia, kad vietos vyno mėgėjai šio aromato neužuodžia. O dabar įsivaizduokime, kaip patys jaustumėmės degustacijoje, kurioje vynas kvepėtų ne serbentais, o lokvos pasta. Tarp Azijoje mažai suprantamų apibūdinimų dažnai minimi net ir tokie, kaip „sviestiškas“, – kadangi pieno produktai šioje virtuvėje vartojami daug rečiau nei Vakaruose.
KOKIA VYNO KALBA ŠNEKA Z KARTA
„Kiekviename straipsnyje rašoma, kad Z karta nebevartoja vyno. Bet galbūt mes apie vyną tiesiog kalbame ne jų kalba?“ – klausia A. Achayo. Nesu mačiusi straipsnių, kuriuose mažėjantis vyno vartojimas būtų panagrinėtas kalbos aspektu, bet pabandykime.
Pagrindinės vertybės, lemiančios Z kartos (angl. Gen Z ) gyvenimo ir vartojimo sprendimus, yra socialinė atsakomybė, skaidrumas ir autentiškumas, kokybės ir etiškumo santykis, sveikata bei įvairovė ir įtrauktis (angl. Diversity and Inclusion –praktika, kuria skatinama komandose turėti kuo daugiau žmonių iš įvairių demografinių grupių bei užtikrinti, kad visų nuomonės būtų vertinamos vienodai). Paskutinį punktą korporatyvinėje aplinkoje pradėjo formuluoti tūkstantmečio (angl. millennials ) kartos atstovai, tačiau būtent Z karta juo remdamasi priima tiek kasdienius, tiek ir pačius svarbiausius gyvenimo sprendimus. Todėl jei jaunimui Azijoje vynas pristatomas kalbant apie niekad
neragautus europietiškus vaisius arba jei iš Azijos kilę someljė Vakarų pasaulyje yra spaudžiami atsiriboti nuo savo asmeninių patirčių, tai automatiškai iš akiračio trina tam tikrų demografinių grupių gyvenimą, patirtį bei žodyną ir yra visiškai priešinga Z kartos vertybėms.
Z karta daug dėmesio skiria sveikatai ir kokybiškam gyvenimo balansui. O štai tūkstantmečio karta, augdama patyrusi visas įmanomas pasaulines krizes, neretai pašiepiama dėl to, kad renkasi alkoholį kaip greičiausią atsaką į savo bėdas. Po jų atėjusi karta švytuoklės principu tokį sprendimą atmeta. Tačiau Z karta kokybę iškelia virš kiekybės, tad ir vyno kaip kūrinio (o ne tik alkoholio vieneto) naratyvas jiems turėtų būti artimesnis. Tik ar tas naratyvas juos pasiekia? Ar pasiekia jiems priimtina kalba?
Tarptautinė vadybos konsultavimo įmonė „McKinsey & Company“ savo tyrime apie Z kartos vertybes „autentiškumą“ apibrėžė kaip siekį atrasti ir išreikšti savo individualumą, atmetant visuomenėje nusistovėjusias etiketes, stereotipus bei statuso simbolius. Tai skamba kaip visiškas kontrastas vyno pasauliui, kuris – turbūt daug nesiginčydami sutiksime – dažnai dvelkia snobizmu, elitizmu bei tradicionalizmu. Z karta nemato reikalo klausyti kalbėtojų, kurie savo vartojamu žodynu pabrėžia atskirtį tarp savęs ir klausytojo. Nesakau, kad visi vyno profesionalai yra elitistiniai snobai, tenorintys parodyti savo pranašumą prieš paprastus mirtinguosius. Sakau, kad vyno profesionalai, tarpusavyje susikūrę darbui labai reikalingą vyno kalbą, pamiršo ją išversti likusiam pasauliui.
Nesėkmių užgrūdinti ir statuso simbolių siekiantys tūkstantmečio kartos atstovai gal ir galėjo klausyti techninio vyno profesionalų žargono degustacijose ar parduotuvėse ir apsimesti, jog neturi klausimų. Tačiau Z kartos dėmesį reikia užsitarnauti, o patingėję savo žargoną išversti į jų kasdienę kalbą, to dėmesio ir nepritrauksime.
SU KUO SUSIKALBA NATŪRALISTAI?
1970-aisiais pajudėjęs natūralizmo traukinys pagreitį įgavo būtent ties tūkstantmečio ir Z kartomis. Prasidėjęs siekiu tausoti dirvą bei švarinti vynus nuo chemikalų, ilgainiui dalis šio judėjimo ėmė tapatintis su stereotipams nepavaldžiu požiūriu ir menine išraiška. Mažos gamybos apimtys, asmeninės vyndarių istorijos ir jų panaudojimas rinkodarai stiprino bendruomeniškumo jausmą. Socialinėse medijose pradėjome matyti pačius vyndarius, sužinojome jų ūkiuose dirbančių asilėlių ir gyvenančių katinėlių vardus, išgirdome istorijas apie tai, kaip vyno etiketę įkvėpė pirmieji jų vaikų piešiniai (čia nekalbu apie tyliuosius, arba anoniminius, natūralistus – vyndarius, kurie turi ilgą švaraus vyno gamybos stažą, bet savo komunikacijoje to nepabrėžia).
Jei dar kartą peržvelgtume pagrindinių Z kartos vertybių sąrašą, suprastume, kad toks vyndarių natūralistų bendravimas atliepia kiekvieną iš jų: natūralistai dirba tvariai ir aiškiai tai komunikuoja; jie teigia, kad vynas turi pirmiausiai džiuginti ir kad po saule yra vietos kiekvienam skoniui ir aromatui.
Viena iš ryškėjančių natūralistų „reformų“ – liberalėjantis vyno žodynas. Išgirdusi, kaip lengvai ir užtikrintai Z karta kalba apie ragaujamus vynus Vilniaus natūralistų baruose, paprasčiausiai pavydžiu (būdama tokio amžiaus, rinkdavausi tą vyną, kurio

pavadinimą pajėgdavau ištarti mažiausiai save pažemindama prieš padavėjus). Vynas jiems pristatomas labiau per emocinę prizmę – dalijantis asmeninėmis istorijomis iš vynuogynų bei nevaržant vyno epitetų WSET’o lentelėmis. Kalba apie vyną vėl po truputį artėja prie Horacijaus eilių – tampa mažiau techninė ir labiau emocinė. Bet kartu ir mažina atskirtį tarp tų, kas vyno įpila, ir tų, kas jį ragauja.
Natūralu, kad daliai vyno profesionalų tokia komunikacija su klientu atrodo netinkama, paviršutiniška ar sensacionalistinė.
Bet jei natūralistams pavyksta bent kiek sumažinti slenkstį į vyno pasaulį žengiančiai naujai vartotojų grupei – visai vyno bendruomenei tai vis tiek yra pergalė.
VYNININKŲ–ŽMONIŲ KALBŲ ŽODYNAS
Kas konkrečiai vyno kalboje didina atskirtį tarp profesionalų ir vartotojų? „Vyno kalba yra labai techniška. Geras someljė turėtų ne tik puikiai žinoti teorinę informaciją, bet ir mokėti ją pateikti vartotojui, o tai įgyjama su patirtimi“, – teigia 2023 m. geriausiu pasaulio someljė išrinktas Raimonds Tomsons. „Savo parduotuvėje („Barents Wine Collectors“ Rygoje) su kolektyvu nuolat aptariame, kaip pristatome savo vynus, kokias gyvenimiškas patirtis ir skonius galime su jais susieti. Tarkime, jei pasakysiu, kad vynas turi daug rūgšties, profesionalui tai nuskambės kaip teigiamas dalykas, tačiau daugumai vartotojų terminas „rūgštis“ skamba neigiamai. Todėl renkuosi tokius apibūdinimus, kaip „žalio ‘Granny Smith‘ obuolio kąsnis“, tada klausytojas gali iškart įsivaizduoti ir skonį, ir tekstūrą.“ Kaip atskirtį didinantis vyno kalbos elementas dažnai minimas ir elitizmas. Pavyzdžiui, vyno terminų vartojimas jų nepaaiškinus ar atsitiktinis vyno regionų paminėjimas be konteksto, tarkim: „Čia gal ir ne Napa, bet neblogai.“ Nieko nežinantį apie Napos slėnio svarbą toks pasakymas tik sutrikdys ir sukels temos atmetimo reakciją. Niekam nepatinka jaustis iškritusiam iš konteksto. Lenkų lingvistas Dariuszas Galasińskis dalyvavo keliasdešimtyje vyno degustacijų Prancūzijoje ir Vokietijoje stebėdamas jose vartojamą kalbą. Išvados buvo tos pačios – su
Geriausias pasaulio someljė Raimonds Tomsons apie „Pinot Noir" pasakoja 2023 m. „Vyno dienų" lankytojams.
vyno mėgėjais reiktų bendrauti kaip su žmonėmis, norinčiais atrasti vyno žavesį, o ne duomenų analitikais.
Dažna bet kurios srities profesionalų klaida kalbant viešai – prielaida, kad klausytojai ateina su tokiu pačiu žinių bagažu. Išskyrus tuos atvejus, kai kalbame rinkos profesionalams, naudinga suvokti, kad pas mus svečiai susirinko būtent dėl mūsų ekspertinių žinių – tokių, kurių jie patys neturi. Mūsų užduotis yra ne tik supažindinti klausytojus su pagrindiniais terminais (kad viduryje šampano degustacijos dalyviams nekiltų klausimo, ar Blanc de Blancs yra vynuogės), bet ir pateikti juos kasdienybės kontekste. Tarkime, pristatydama natūraliuosius vynus savo tėvų kartos klausytojams, visada papasakoju istoriją, kaip mano tėtis, pirmąkart paragavęs mano pasiūlyto natūraliojo vyno, prisiminė jaunystės laikus ir „dėdės Ričardo vynelį Šančių rūsyje“. Iš vienos pusės – tiesiog nekaltas juokelis, bet pastebėjau, kad gyvenimiški palyginimai ar asociacijos sukuria bendrą kontekstą, ir, prisiminę tokių naminių vynų skonį, dalyviai į naujus aromatus reaguoja daug prielankiau.
Tiesa, kartais po profesiniu žargonu imame slėptis ir kitu atveju – turiu galvoje dažną kalbėtojų baimę neduokdie pasirodyti nepakankamai protingiems. Bet prisiminkite, kad nė viena kalba arba pristatymas nebus sukritikuoti dėl to, kad buvo pernelyg aiškūs. Jums ši tema ir terminologija yra kasdienybė, tačiau jūsų klausytojams – ne, ir jūsų uždavinys – sumažinti atotrūkį tarp klausytojų ir dažnai mistifikuojamo vyno pasaulio.
Noriu akcentuoti ir tai, kas ne pirmąkart minima ir vyno rašytojų simpoziumo diskusijose – kalbant apie vyną būtina atsisakyti seksizmo: vynai nebeturėtų būti nei vyriški, nei moteriški. Nors jau aptarėme skonio ir kvapo žodyno ribotumą, tačiau profesionalai visada ras tinkamų apibūdinimų, neįsprausdami vyno į archajiškus stereotipus.
„Kalbos struktūra formuoja ne tik mintį, bet ir realybės suvokimą“ – teigia lingvistas, filosofas ir politinis aktyvistas Noamas Chomsky. Ir nors dalį vyno magijos įmanoma tik patirti, bet ne aptarti, kiekvieno rinkos profesionalo uždavinys yra ieškoti žodžių, kurie žmones prie vyno suburtų, o ne išskirtų.

Vaidotas
Puklevičius
Prioratas yra savotiškas nedidelis „katilas“, įspraustas tarp gana aukštų kalnų Katalonijoje, ir tai yra neabejotinai vienas nuostabiausių vyno regionų pasaulyje. Prioratas nutolęs nuo Barselonos vos apie 200 km – net vynui nesimeldžiantis turistas gali susivilioti nuostabia galimybe pasprukti nuo šurmulingos Barsos: miškais apaugę kalnai, terasomis susodinti vynuogynai, vaizdingi kaimeliai, tokie ramūs ir tylūs, tarsi prigulę siestai, o juose yra puikių tradicinių restoranėlių, kuriuose galima paragauti tikro katalonietiško maisto. O jeigu dar mėgsti vyną, tai nesvarbu, ar ruduo, ar vasara, ar pavasaris, ar žiema – čia visuomet malonu užsukti į mažas vynines ir mėgautis nerealia vietinio vyno įvairove sėdint kurio nors kaimelio centrinėje aikštėje, klausantis, kaip kas pusvalandį skamba bažnyčios varpas, pranešantis, kad atėjo laikas papildyti taurę.
Manoma, kad dabartinė kalnuota Priorato teritorija vynuogėmis buvo užsodinta romėnų, – matyt, jie pirmieji įžvelgė regiono pranašumus. Po Romos imperijos subyrėjimo, kaip ir visur kitur, kažkoks neaiškios kokybės vynas ten buvo gaminamas, nes vyno reikėjo tiek liturgijai, tiek šiaip buityje. Tačiau tikra vynininkystė Priorate suklestėjo tik į šitą kraštą atsikrausčius vienuoliams. Manoma, kad po rekonkistos, išvalius Kataloniją nuo maurų, karalius Alfonsas Kastilietis panoro kaip galima labiau sukrikščioninti visas atokiausias vietas. Todėl buvo nuspręsta į Kataloniją atkelti kartūzų vienuolyną. O rasti tinkamą vietą naujam vienuolynui karalius pasiuntė kelis riterius. Anot legendos, šiems atvykus į Montsanto kalnų papėdes pasipainiojo kažkoks šnekus vietinis piemuo, papasakojęs riteriams, kad būtent toje vietoje, kur jie sustoję pailsėti, pasirodydavę laiptai, o tais laiptais angelai kopdavę į dangų. Žmonės tais laikais nebuvo linkę tikrinti informacijos iš kelių šaltinių, todėl riteriai ilgai provincijoje neužtruko, grįžo pas karalių ir perpasakojo visą istoriją. Neaišku, ar karalius buvo toks pat patiklus, bet jis pasiūlė tą stebuklingą regioną Kartūzų ordinui. Kartūzai, nežinia, ar susižavėję pasakojimu, ar sugundyti galimybės įsikurti naujame regione, kur jiems bus suteikta teisė rinkti mokesčius, į Prioratą atvyko 1194 metais. Savo kraustynėms pažymėti jie būtent toje vietoje, kur pasirodydavo laiptai į dangų, iš karto pastatė altorių, skirtą Švč. Mergelei Marijai (maždaug toje vietoje dabar stovi senojo vienuolyno griuvėsiai).
8-ajame dešimtmetyje tokios vyninės ir vyndariai, kaip „Cellers Scala Dei“, „Hermanos Barills“, „Rotllan Torra“, užuot tiekę vynuoges kooperatyvams, pradėjo gaminti ir pilstyti jau savo namų vyną. Tačiau tikra Ispanijos vyno pažiba regionas tapo tada, kai į Prioratą atsikraustė grupė hipiuojančių vyndarių: René Barbier, Álvaras Palaciosas, Josepas Lluísas Pérezas, Daphne Glorianas Carlesas Pastrana. Jie jau turėjo geros vyndarystės patirties Riochoje arba Prancūzijoje (pvz., Alvaras Palaciosas patirties sėmėsi „Chateau Petrus“). Jie pastebėjo unikalų regiono terroir ir iš pradžių eksperimentavo kartu leisdami į rinką
„kooperatinius“ vynus. Paskui kiekvienas atskirai, vis įsigydami naujų sklypų, vynuogynų, pradėjo gryninti savo individualų vyndarystės stilių ir pristatyti vyno pasauliui savo ūkiuose pagamintus vynus. Tačiau vyndarių kompanija, dar vadinama La Pandilla de Los Cinco („Penkerių gauja“) arba El Proyecto Clos („Clos projektas“), visuomet laikėsi kartu, dalindamiesi patirtimi ir resursais, ir pamažu sukūrė regione gana unikalią vyndarystės sistemą, kol 2000 metais Prioratui buvo suteiktas DOQ statusas. O šių vyndarių vynai „Clos Mogador“, „L‘Ermita“, „Clos Martinet“, „Clos Erasmus“, „Clos de l‘Obac“ tapo kultiniai.
PRIORATO KLIMATAS IR TERROIR
Priorato klimatas yra Viduržemio jūros, su stipriai jaučiama žemynine įtaka. Jam būdingos karštos, sausos vasaros ir švelnios, vėsios žiemos bei ryškūs dienos ir nakties temperatūrų skirtumai. Vasaros Priorate yra labai karštos, temperatūra dažnai viršija 35 °C, ir šis intensyvus karštis užtikrina, kad vynuogės visiškai prinoktų ir cukraus lygis būtų labai aukštas. Dėl to vynai čia, ypač raudonieji, pasižymi dideliu alkoholio kiekiu ir sodriu, koncentruotu skoniu. Tačiau dėl regiono aukščio ir artumo Montsanto kalnams, nepaisant karštų dienų, naktys gali būti gana vėsios. Toks dienos ir nakties temperatūrų skirtumas padeda išsaugoti vynuogių rūgštingumą, subalansuoja cukraus kiekį ir užtikrina, kad vynai būtų galingi, bet kartu ir gaivūs. Kritulių kiekis regione yra ribotas, ypač vynuogių augimo metu. Kad gautų maistinių medžiagų ir vandens, vynmedžiai leidžia šaknis gilyn, į ypatingą dirvožemio sluoksnį, suteikiantį vynams minerališkumo bei kompleksiškumo. Nors sausos sąlygos sumažina ligų riziką, regiono vėjai kartais gali padidinti sausros riziką. Tačiau dėl gerai drenuojamos dirvos ir gilių šaknų seni vynmedžiai geba išgyventi ir tokiomis sąlygomis, o jų derlius, nors mažas, bet aukštos kokybės ir koncentruoto skonio. Apskritai iššūkių kupinas Priorato klimatas (karštis, mažai kritulių ir prastos dirvos) verčia vynmedžius sunkiai dirbti, todėl jų vynas koncentruotas, sodrus, sudėtingos struktūros ir unikalios mineralizacijos.


Cartoixa d'Escaladei (XII a. kartūzų vienuolyno liekanos)
Jeigu paklausite bet kurio Priorato vyndario, kodėl šio regiono vynas yra išskirtinės kokybės, turbūt 9 iš 10 pasakys, kad tai yra susiję su llicorella (tarti „jikoreja“). Taip kataloniškai vadinamas dirvožemis, kurį daugiausia sudaro rausvai juodas skalūnas su smulkiomis žėručio kvarco dalelėmis, o įvairūs dirvožemio sluoksniai užpildyti molinga dirva. (Važiuojant automobiliu pavakary, kai saulė apšviečia kalvas, dirvožemyje esantis žėrutis gražiai leidžia saulės zuikučius.)
Daugiau apie skalūną, Priorato apeliacijas, kaimelius skaitykite www.vynozurnalas.lt
PRIORATO KAIMAI, VYNUOGĖS, VYNDARIAI

Tai itin kalnuota teritorija, todėl daugelis vynuogynų auginami ant stačių šlaitų ( costers ). Dauguma vynuogynų yra tokie statūs, kad jų būtų neįmanoma auginti neįrengus terasų. Šios dažniausiai tokios siauros, kad jose telpa tik viena ar dvi vynmedžių eilės. Be to, daugelyje vietų šlaitų nuolydis yra daugiau nei 15 proc., o kai kuriuose vynuogynuose jis siekia net 60 proc. Darbas su mechanizuota technika čia beveik neįmanomas, todėl kur neįvažiuoja traktorius, užsiropščia mulai, o šie dar ir patręšia žemę.
Dėl specifinio regiono terroir Priorato vynmedžiai duoda labai mažą derlių – mažiau nei 1 kg nuo vieno vynmedžio. Pavyzdžiui, vyninės „Valla Llach“ geriausio vyno „Mas de La Rosa“ buteliui pagaminti reikia 6 vynmedžių derliaus (panašiai kaip darant saldųjį soterną). Todėl šio regiono vynai yra brangesni nei kitur. Nepaisant to, kad Prioratas užima labai mažą teritoriją, derliaus nuėmimo laikotarpis skirtinguose kaimuose labai skiriasi. Jis paprastai prasideda Belmunto miestelyje rugsėjį ir baigiasi spalio pabaigoje arba lapkričio pradžioje Poreroje ir La Morera de Montsante. Karštesniais ir sausesniais metais, kaip šiemet, kai
kurie vyndariai derlių pradėjo imti jau rugpjūčio viduryje. Pagrindinės ir pagal taisykles rekomenduojamos Priorato regiono vynuogių veislės yra ‘Grenache’ ir ‘Carignan’. Leidžiamos raudonosios vynuogės: ‘Garnatxa Peluda’ („plaukuotoji“), ‘Tempranillo’, ‘Piquepoul’, ‘Cabernet Sauvignon’, ‘Cabernet Franc’, ‘Pinot Noir’, ‘Merlot’ ir ‘Syrah’. Beveik 90 proc. pasodintų vynuogių sudaro raudonosios, iš kurių dažniausiai gaunami galingi ir kompleksiški, bet kartais ir labai subtilūs vynai. Ilgą laiką vyndariai aktyviai eksperimentavo su tarptautinėmis veislėmis, tačiau ir čia neatsiliekama nuo naujosios bangos, kuri skatina vyndarius kuo daugiau naudoti „tradicinių“ vynuogių. Be to, pastaraisiais metais suaktyvėjo ir baltojo vyno gamyba. Svarbiausios baltosios vynuogės yra ‘Garnacha Blanca’, kurios baltojo Priorato vyno paletėje sudaro apie 40 procentų. Įprastai baltosios garnaš laikomos gana nuobodžia, neišraiškinga veisle, bet specifinis Priorato terroir šiai veislei taip tinka, kad čia pagaminti vynai turi nuostabų natūralų balansą, jie dažnai būna labai minerališki, galingi, bet drauge ir rafinuoti, subtilūs. Daug vyndarių mėgsta nemaišyti ‘Garnacha Blancos’ ( monocépage ), bet ji taip pat dažnai maišoma ir su kitomis baltųjų vynuogių veislėmis, tokiomis kaip ‘Macabeu’, ‘Pedro Ximénez’, ‘Chenin Blanc’, ‘Xarello’, ‘Piquepoul’, ‘Parellada Montonega’ ir tipinėmis Ronos slėnio vynuogėmis, t. y. ‘Marsanne’, ‘Roussanne’, ‘Viognier’. Kai kurie vyndariai daro vynus ir visai nenaudodami ‘Garnacha Blancos’. Žodžiu, baltojo vyno spektras tikrai platus.
Mintis padegustuoti geriausių Priorato vynų kilo supratus, kokie jie gali būti skirtingi, įvairūs. Todėl baltojo vyno degustacijai pasirinkome 4 vynus, pagamintus iš kuo skirtingesnių vynuogių bei jų mišinių. Tai tikrai įdomi patirtis, nes baltieji sudaro labai mažą dalį (gal tik iki 10 proc.) visos vyno gamybos. O daugelis gamintojų mano, kad baltieji vynai dėl savo itin minerališkos struktūros gali būti naujas garvežys, kuris trauks visą Priorato vyno ešaloną.


Gratalopsas
PIRMAS KĖLINYS – BALTIEJI
Familia Nin Ortiz Terra Vermella 2020
(100 % Parellada Mononega)
Clos de L’Obac Kyre 2019 (35 % Garnatxa blanca, 30 % Macabeu, 30 % Xarel.lo, 5 % Moscatel de Alejandria)
Cellers Scala Dei Massipa 2021 (70 % Garnatxa Blanca, 30 % Chenin Blanc)
Clos de L’ Obac L’Escarpat 2022 (Xarel.lo, Macabeu)
ROŽINIAI
Partida Pedrer Priorat Rosado 2019 (Garnatxa, Monastrell, Carignan)
Terroir Al Limit Priorat Roc d’Aubaga 2017 (Garnacha: 80 % Blanca, 10 % Gris ir 10 % Tinta
Butelį atidarėme likus 3 valandoms iki degustacijos. Biodinaminis vynuogynas tiesiog rėkte rėkė iš taurės – labai stiprus gyvuliškumas. Galvojome, kad su laiku tie redukciniai kvapai išsivadės. Tačiau ir po trijų valandų vynas šaukė: aš esu labai biodinaminis ir be sulfitų, o mano mielės natūraliausios. Spalva šviesiai geltona. Jeigu esi optimistas, aromatas marokietiškų raugintų citrinų, jei pesimistas – vėdarų. Skonis labai minerališkas, stipriai išreikšta, bet subalansuota rūgštis, ilgai išliekantis poskonis. Gal reikėtų atidaryti kitą butelį. 88–93 balai.
Vyną atkimšome prieš 3 valandos ir tada viskas atrodė puikiai: kriaušių, obuolių natos, riešutai, šiaudai, migdolai, medus. Burnoje sviestiškas. Praėjus 3 valandoms nuo atidarymo kvapas buvo geras, tik gal suintensyvėjo marcipaninės natos, pradėjo panašėti į pietų Ronos ‘Marsane’ / ‘Rousane’ pagrindu padarytus vynus, tačiau skonis išliko trumpiau. Tikiu, kad kitas butelis bus žymiai geresnis. 92–94 balai.
Aromatai: citrusų žievelės, Provanso žolelės, jazminų arbata, medus. Burnoje minerališkai tvirtas, bet ir labai sodrus, su švelnaus citrinų kremo poskoniu. Be abejo, vieningai pripažintas geriausiu iš trijulės. 93 balai.
Iš vieno vynuogyno Torroja del Priorato kalnuose. Pagaminta tik 601 butelis. Spalva – geltono aukso. Aromatas: dieviškai sodrus, kriaušių, medaus, neaiškių gėlių, šiek tiek vaško, džiovintų abrikosų, dūmų. Burnoje sausas, vidutinio stiprumo subalansuotos rūgšties, juntama tropinių vaisių puokštė, lydima sviesto, vanilės, anyžių ir citrinų natų. Subtiliai minerališkas ir labai subalansuotas ilgai išliekantis poskonis. 94 balai.
Vidutinio sodrumo lašišos spalva. Intensyvus braškių, kreminio varškės deserto, titnago, vyšnių ir dūmų aromatas. Svaresnis nei vidutinis, sodrus ir koncentruotas, sauso, žemiško vaisių skonio su redukcijos ir sūrumo užuominomis. Ryškios rūgšties, šiek tiek taniniškas, o poskonis maloniai kartus. 92–93 balai.
Pagamintas kaip raudonasis, maceruotas kartu su šakelėmis, spontaniškai fermentuotas, išpilstytas nefiltruotas. Gintarinė spalva su lašišos atspalviais. Intensyvus džiovintų braškių, raudonųjų serbentų, prieskonių, vaistinių žolelių, džiovintų rožių ir kinrožių žiedlapių, juodosios arbatos aromatas. Svaresnis nei vidutinis, nepaprastai struktūruotas, vos kreminės tekstūros ir juodosios arbatos, braškių, arbūzų bei prieskonių skonio, užbaigiamas puikiai integruotu didesniu nei vidutinis rūgštingumu. 90–92 balai.
O raudonojo vyno degustacijoje atskirai ragavome 3 ‘Cariñenos’ pagrindu įvairių kaimų vyndarių, iš įvairaus amžiaus vynmedžių derliaus padarytus vynus bei 3 ‘Garnachos’ pagrindu (arba nemaišytus) padarytus vynus. Po to įterpėme dar 2 subrendusius mišinius ir 2 rožinius vynus tarp baltojo ir raudonojo. Na, o pabaigai palikome vi di ranci – vietinį desertinį vyną, daromą soleros būdu.
Taigi, iš viso degustavome 15 vynų – tiek išragavus, jau galima daryti išvadas, ar Priorate iš tikro yra laiptai į dangų.

RAUDONIEJI, PAGAMINTI ‘GARNACHOS’ PAGRINDU
Alvaro Palacios Finca Dofi 2000 (80 % Garnatxa, Cabernet Sauvignon, Merlot, Syrah)
Mas Martinet Els Escurçons 2006
Terroir Al Limit Les Manyes 2013
Labai graži rubino spalva. Džiovintų vyšnių šokolade, kalėdinio prieskoniško meduolio, lengvas tabako, miško samanų aromatas. Vynas ne sunkus, bet labai elegantiškai intensyvus, taninai visiškai susigulėję, lieka nuostabiai malonus pieniško šokolado poskonis. Vynas, matyt, jau negerės. Laikas gerti. 92–93 balai.
Kala sirpiomis vyšniomis, figų džemu su šiek tiek dūmo ir tabako. Taip pat vidutinio svarumo, labai elegantiškas, švelnus, maloniai saldus kaip gerai subrendęs „Chateneuf-du-pape“, glotnus, lengvo minerališko prieskonio, vidutinės rūgšties ir labai ilgai išliekančio salsvo poskonio. 94–96 balai.
Pagamintas vien iš 800 m aukštyje augančių 1960 m. sodintų ‘Grenache’ vynuogių, maceruotas su visomis kekėmis. Aromatai labiau žemiški, po lengvais dūmų, skrudintos mėsos, deguto, odos, rozmarinų kvapais slėpėsi šokoladinė slyvų uogienė. Dar rafinuotesnis ir lengvesnio stiliaus nei pirmieji. Labai elegantiškas, vaisiškas ir ilgai išliekantis poskonis. Puikus pavyzdys, kaip Priorato vynas gali būti burgundiškai elegantiškas. 91–93 balai.
RAUDONIEJI, PAGAMINTI ŠIMTAMEČIŲ ‘CARIGNAN’ PAGRINDU
Cims de Porrera Classic 2001 (85 % Carignan, 15 % Garnatxa)
Terroir Al Limit, Arbossar 2013
Vall Llach Mas de La Rosa 2017 Gran Vinya Classificada
RAUDONIEJI MIŠINIAI
Clos Mogador Priorat 2004
(49 % Garnacha, 29 % Carinena, 16 % Syrah, 10 % Cabernet Sauvignon)
Mas Doix Priorat Costers de Vinyes Velles 2009
(50 % Carinena, 48 % Garnacha ir 2 % Merlot)
DESERTUI – SOLERA
Cellers de Scala Dei Priorat Vi Ranci (Garnatcha)
Labai elegantiškai intensyvus rūkytų slyvų aromatas, su vanilės, vyšnių, penkių prieskonių mišinio, Provanso žolelių „padažu“ ant viršaus. Vidutinio svarumo, tiesiog nuostabiai ir tobulai užpildantis gomurį, priverčiantis užmerkti akis ir sudainuoti Ozzy’o Osbourne’o dainą „Mama, I am comming home“. 93–95 balai.
Vidutinio intensyvumo rubino spalva su granato atspalviu. Aromatai: vidutinio sodrumo dūminis gervuogių, slyvų, žemės, vyšnių žiedų, keptų žolelių ir gėlių. Vidutinio svarumo, gaivus, gyvybingas ir energingas, elegantiškos struktūros, aksominės tekstūros, kupinas šviežių vaisių skonio su žolelių ir prieskonių natomis, vidutinio rūgštingumo ir labai švelnių taninų. 93–94 balai.
Pagamintas vien tik iš ‘Cariñenos’ vynuogių, pasodintų 1925 m. ir auginamų 600–1900 m aukštyje. Labai tamsi rubino spalva. Aromatas toks stiprus, kad baisu, jog sukant taurę jos nesuskaldytų. Trešnių, vyšnių, slyvų, rožių, vanilės, penkių prieskonių mišinio aromatai. Dar jaunas ir labai „raumeningas“, tiesiog neįtikėtinos koncentracijos – kaip aukščiausios klasės eau de parfum Saldžių kaulavaisių, dūmų, juodojo šokolado skonis, jau gana švelnūs, bet dar stiprūs taninai. Pats poskonis išlieka be proto ilgai, ir kiekviena sekundė verta sumokėto euriuko. 95–96 balai dabar, o po 5–10 metų gal ir visas 100.
Intensyvus, koncentruotas aromatas su gervuogių, vyšnių, saldaus tabako, juodųjų serbentų, kavos, prieskonių, džiovintų našlaičių ir žemės natomis. Svarus, sodrus ir koncentruotas, tačiau darnus, gaivaus ir sudėtingo, ilgai išliekančio žolelių ir dūminių vaisių aromato, maloniai aštrus, su tabako ir kakavos užuominomis. Aksominių, vidutinio intensyvumo taninų. 94–95 balai.
Vynmedžiai sodinti apie 1902 m. Vidutinio sodrumo rubino spalva. Intensyvus, sudėtingas aviečių, slyvų, odos, rožių, našlaičių, miško paklotės, prieskonių ir tabako aromatas. Vidutinio svarumo, koncentruotas ir kupinas skonio, tačiau lieknas ir elegantiškas, šilkinės ir aksominės tekstūros, dūminių ir prieskoninių raudonų vaisių, tabako ir šokolado skonio, vidutinio rūgštingumo, vidutinių šilkinių taninų, ilgai išliekančio poskonio. 93–94 balai.
Pirmas vynas užpiltas 1982 m. ir toliau brandintas leidžiant vynui oksiduotis. Sodri gintarinė, šiek tiek drumsta spalva. Intensyvus odos, džiovintų slyvų, skrudintų lazdynų riešutų, džiovintų abrikosų aromatas. Ilgiau palaikius taurėje atsirado ir lengvas grybų aromatas. Vidutinio svarumo, bet ir intensyvus, koncentruotas, kremiškas, cheresiškas, džiovintų vaisių ir sūdytų migdolų poskonio. Formaliai tai desertinis vynas, bet visai nesaldus, o netgi savotiškai gaivus. 94 balai.


Geras vynas neabejotinai yra didelė šventė gomuriui. Vyno skoniui atsiskleisti ne mažiau svarbios taurės, o jų švara – galutinė nata, sukurianti bendrą įspūdį tiek priimant svečius namuose, tiek ir baro, restorano lankytojams.
Vyną norisi gurkšnoti iš švarių ir spindinčių taurių, tad švaros priemonių lyderė Lietuvoje UAB „Manjana“ dalinasi patarimais, kurie nenuvils, o taurės išliks akinamai švarios.
JEI TAURES PLAUNATE RANKOMIS
• Naudokite šiltą vandenį ir švelnų indų ploviklį, be kvapiklių ir papildomų pridėtinių medžiagų, tokių kaip glicerinas, –jos sunkiau nuskalaujamos.
• Plaukite minkšta mikropluošto šluoste, venkite kempinėlių su šiurkštuma ir kitų abrazyvinių medžiagų, galinčių subraižyti taurės paviršių.
• Gerai nuskalaukite šiltu vandeniu, kad pašalintumėte indų ploviklio ir nešvarumų likučius.
• Taurę sausinkite blizginimui skirta mikropluošto šluoste. Ji puikiai sugeria drėgmę ir blizginant ant stiklo nepalieka plaušelių. Jei sausinsite daugiau taurių, naudokite blizginimui skirtą virtuvinį mikropluošto rankšluostį.
• Venkite sausinti taures su popieriniu ar medvilniniu virtuviniu rankšluosčiu. Jie nėra skirti taurių blizginimui, todėl ant paviršiaus palieka audinio plaušelių, kurių dėl intensyvaus sausinimo atsiranda vis daugiau, o įelektrintas paviršius pritraukia aplinkoje esančias dulkes.
JEI TAURES PLAUNATE INDAPLOVĖJE
• Įsitikinkite, kad indaplovė yra švari ir joje nėra susikaupusių maisto likučių.
• Taures geriausia plauti atskirai nuo kitų indų, kad ant lėkščių likę maisto likučiai plovimo metu nesubraižytų taurių paviršiaus.
• Papildykite indaplovės druskų ir skalavimo skysčio talpas. Indaplovių druska minkština vandenį, todėl indai labiau spindi, o indaplovių tabletės efektyviau atlieka savo darbą. Skalavimo skystis užtikrina tinkamą indų džiovinimą, ypač stiklinių ir taurių.
• Indaplovės tabletes rinkitės su papildomomis savybėmis, kurios suteikia stikliniams indams spindesio.
Tikimės, kad taurių priežiūros patarimai buvo naudingi ir mėgaudamiesi vyno skoniu drauge džiaugsitės spindinčiomis taurėmis.

STUDIJŲ PRADŽIA
TRUMPIEJI VYNO KURSAI VILNIUJE IR KITUOSE MIESTUOSE
2025 sausio 15 d. Panevėžys 2025 sausio 28 d. Vilnius
KAM SKIRTA Pradedantiems profesionalams ir mėgėjams
TRUKMĖ 1,5 mėn. 6 vakarinės paskaitos 1 k. per savaitę Iš viso – 18 akad. val.
KALBA Lietuvių
TURINYS

STUDIJŲ PRADŽIA 2025 ruduo
KAM SKIRTA
Pažengusiems mėgėjams ir profesionalams. Rekomenduojama po someljė studijų arba WSET Level 2 Award in Wines
TRUKMĖ Dieninės studijos. 4 dienos – 1 k. per savaitę. Iš viso – 35 val. auditorijoje
Kalba Anglų
Daugiau informacijos


Dr. Arūnas Starkus Lietuvos someljė mokyklos studijų vadovas, WSET diplomantas, šampano magistras, buvęs Vyno magistrų instituto studentas, LSA steigėjas ir prezidentas 2008–2015 m.

Narimantas Miežys Daugkartinis Lietuvos ir Baltijos šalių someljė čempionatų nugalėtojas

Rasa Starkus Lietuvos someljė mokyklos įkūrėja, LSA steigėja ir prezidentė 2005–2007 m., WSET absolventė, Bordo vyno mokyklos absolventė

Gabrielė Pravilonienė „Vyno klubo“ vyno ekspertė, WSET Vyno diplomo studijų absolventė, Vyno magistrų instituto studentė
SOMELJĖ STUDIJOS
2025 sausio 27 d. (1 semestras)
2025 sausio mėn. (2 semestras)
2025 sausio 29 d. (3 semestras)
Profesionalams ir mėgėjams
Visa trukmė: 3 semestrai – 1,5 metų
Semestre – 12 vakarinių paskaitų 1 k. per savaitę
Semestras – 42 akad. val.
Lietuvių

2025 pavasaris ir ruduo
Mėgėjams ir profesionalams. Tinka ir pradedantiesiems
Dieninės studijos. 3 dienos – 1 k. per savaitę Iš viso – 18 val. auditorijoje
Anglų


Petras Jarašūnas „Vyno klubo“ vyno ekspertas

Andrius Pagojus „Vyno klubo“ vyno ir stipriųjų gėrimų ekspertas
2025 pavasaris ir ruduo
Profesionalams ir mėgėjams. Tinka ir pradedantiesiems
Dieninės studijos. 3 dienos – 1 k. per savaitę Iš viso – 18 val. auditorijoje
Anglų


2025 ruduo
Mėgėjams ir profesionalams. Tinka ir pradedantiesiems
1 diena paskaitų – 7 akad. val.
Anglų


Martynas Pravilonis Daugkartinis Baltijos someljė čempionato nugalėtojas, Europos someljė čempionato finalininkas, Someljė magistrų rūmų studentas, WSET diplomantas.

Arminas Darasevičius Lietuvos someljė asociacijos prezidentas, daugkartinis Lietuvos someljė čempionatų nugalėtojas
Klausiame Lietuvos someljė mokyklos studentų. Nuo 2006 m.
čia mokėsi per 2500 vyno mėgėjų ir profesionalų. Juos į kursus apie vyną ir kitus gėrimus atvedė skirtingi motyvai. Tačiau visų gastronominis gyvenimas po studijų pasidarė įdomesnis.
Monika Balčiauskaitė, Vilniaus miesto operos vadovė ir prodiuserė
SOMELJĖ STUDIJŲ II SEMESTRO STUDENTĖ

Kaip kursai pakeitė Jūsų santykį su vynu?
Someljė kursai labai pakeitė santykį su vynu ir vis dar keičia! Į mokyklą atvedė smalsumas ir vyro stumtelėjimas. Pradėjus gilinti žinias, akyse prašviesėjo: lentynose ar vyno meniu nebeieškau pažįstamos etiketės ar to bene vienintelio žinomo pavadinimo, o priešingai – kažko nematyto, neragauto ar naujai paragauto pamokose. Šeimos atradimas (tik nesijuokit!) – petnatai! Ir natūralieji vynai. Someljė kursuose ir vyno pasaulyje – kaip miške: kuo gilyn, tuo daugiau medžių. Bet prisimenu nutikimą vasarą: su vyru važiavome į mėgstamą restoraną Latvijoje, pietavome, maistą derinome su vynais, bet premium vyną pasikuklinome rinktis. Ragavome „Pinot Gris“, kurį mums pristatė kaip vyną iš senų vynuogynų – uodžiam, čepsim, stebimės ir diskutuojam, kad mums, tyčia ar ne, tikriausiai įpylė aukštesnės klasės vyno. Klausiu someljė, o jis paslaptingai teatsakė: gal... gal... Bandau po stalu telefone gūglinti etiketę – o varge, veik 100 eurų už butelį. Na, tai nebent kokiai didelei šventei ar jubiliejui... Bet džiūgavom, kad gavom progą paragauti ypatingo vyno. Kitą dieną neapleidžia mintis apie tą vyną. Vėl telefone ieškau ir žiūriu, kad ta kaina – už 6 butelius, ne vieną! Tai spėkit, kuo draugus vaišinsim ir „mulkinti“ bandysim…
Ką patartumėte svarstantiems rinktis kursus ar būsimiems studentams?
Jeigu radote someljė kursus, tikriausiai tai nutiko ne veltui, tad išdrįskite! Net jeigu dvejojate, ar šie mokslai jums, be naujų ar gilesnių žinių, ten sutiksite bendraklasių, bendraminčių ir vyno mėgėjų bendruomenę.
Ir labai patarčiau dalyvauti „Vyno klubo“ ir Someljė mokyklos organizuojamuose renginiuose: „Vyno dienose“, vyno ir desertų čempionate, meistriškumo pamokas, vakarienes – juose mokslo šaknys ne tokios karčios, o vaisiai jau nokstantys!
Saša Baidakova, restorano „Le Travi“ vadovė ir someljė
BAIGĖ WSET II LYGIO VYNO KURSUS

Kas iš studijų Jums buvo vertingiausia?
Vyno pasaulyje dirbu dvejus metus, restorane „Le Travi“ esu atsakinga už vyno parinkimą. Nepaprastai naudinga buvo pagrindinė kurso dalis – vyno degustavimo struktūrizavimas ir supratimas, ką reiškia skirtingi skoniai ir aromatai. Iš įvairių vyno degustacijų buvo likę keli dalykai, kurių tuo metu iki galo nesuprasdavau – sakydavau sau, kad išsiaiškinsiu juos kada nors vėliau, bet taip niekada ir neišsiaiškindavau. Mokslai padėjo man pagilinti žinias, kurių įgijau dirbdama šioje srityje, ir viską susieti tarpusavyje.
Kokią įtaką studijos padarė Jūsų vyno pasirinkimui restorane arba tam, kaip vyną pristatote svečiams?
Žinios, įgytos kurso metu, neabejotinai pakeitė mano požiūrį į darbą. Ragaudama vyną, dabar mąstau ne tik apie tai, ar jis man patinka, bet ir apie tai, kas konkrečiai patinka ir kaip tai apibūdinti. Restorano svečiams galiu geriau padėti išsirinkti patinkantį vyną. Svečiai ne visada žino, kaip tiksliai apibūdinti, kas jiems patinka, bet dabar galiu jiems užduoti geresnius klausimus, kad išsiaiškinčiau.
BAIGĖ TRUMPUOSIUS VYNO KURSUS

Kodėl nutarėte mokytis apie vyną?
Jau kurį laiką vis pasvajodavau daugiau sužinoti apie vyną. Entuziastingai dalyvaudavau degustacijose. Šią vasarą net kelionės į Italiją tikslas buvo ragauti ir pažinti lankyto regiono vyną, keliavome į vyno gamyklą. Praėjusiais metais, Naujųjų išvakarėse, užrašiau vieną iš tikslų 2024-iesiems – pagaliau baigti vyno pažinimo kursus Someljė mokykloje. Labai džiaugiuosi, kad pavyko šią svajonę išpildyti. Kaip juokavau pradėjusi kursus, tai bene vienintelis mokslas, kurio saldūs ne tik vaisiai, bet ir šaknys.
Kita vertus, po pirmosios paskaitos jaučiausi kiek suglumusi, nes suvokiau, kad nebus taip paprasta, kaip maniau – vyno pasaulis toks platus ir kompleksiškas, jame tiek plonybių ir niuansų... Tad pasiryžau daug ir sunkiai dirbti, tai yra degustuoti daug vyno ir įsiklausyti į savo pojūčius.
Dar viena priežastis apsispręsti buvo tai, kad jau kurį laiką buvome „įsikandę“ vieną mėgstamą vyną (vynuogių veislę), ir vis pagalvodavau: kaip nuobodu, juk pasaulyje yra tiek daug gero vyno, reikia tik jį atrasti ir prisijaukinti!
Galbūt kursai padėjo įgyti kokį nors naują su vynu susijusį įprotį?
Labiausiai džiaugiuosi, kad nuo šiol nebijau eksperimentuoti, ragauti naujų vynų. Pamenu, vienos paskaitos metu degustavome vyną, kuris man labai nepatiko – galvojau, kad niekada tokio nepirkčiau ir negerčiau. Bet tada dėstytojas labai gražiai pakvietė į jį pasižiūrėti kitaip – pabandyti jį suprasti, pajusti: „Jeigu yra ką apie vyną pasakyti – jis jau geras.“ Man labai patiko šis požiūris. Juk vynas – kaip koks chameleonas: ragaujant vieną, atsiskleidžia vienokios savybės, o priderinus prie patiekalo – suskamba jau kitaip.
O ką jau kalbėti apie tinkamą temperatūrą, taurę…
Taip pat pirmą kartą supratau, kokie someljė turi būti atidūs aplinkai, kvapams. Per paskaitas supratome, kad viena yra atpažinti kvapą – taip, esu tokį užuodusi! – bet daug sunkiau yra tą kvapą įvardinti. Pamenu dėstytojo žodžius: „Visi žinome, kaip kvepia obuolys, bet ar visi galėtume atpažinti obels žiedo aromatą?“ Tada lėkiau į parduotuvę pirkti pasiflorų, nes susigriebiau, kad jų skonį atpažinti galiu, bet kvapo nesu įsidėmėjusi.
Juokinga buvo, kai sužinojau, jog šabli yra šardonė, o primitivas bus vadinamas sausu, net kai jame yra likutinio cukraus. Iš naujo pamilau portą, atradau madeirą. Esu labai laiminga – daug sužinojau ir supratau, kad dar labai daug ką noriu sužinoti.
Labai buvo smagu, kad paskaitas vedė skirtingi dėstytojai.
Kiekvienas savaip pristato temą, kiekvienas yra savita asmenybė, turinti pašaukimą atsiduoti vyno pasauliui.
Karolina Kinčinaitė, restorano „HeJi“ arbatos someljė
SOMELJĖ STUDIJŲ I SEMESTRO STUDENTĖ

Ar spaudimą mokytis pajutote labiau iš reiklių „HeJi“ svečių, ar iš vadovo – Lietuvos someljė čempiono Martyno Pravilonio?
Galbūt studijose įgytas žinias jau pavyko pritaikyti darbe?
Restorane dirbu arbatos someljė. Pastebėjęs mano gabumus, atsidavimą bei smalsumą, dalyvauti mokymuose paskatino kolega, vadovas Martynas Pravilonis. Iki šiol nebuvau vyno mėgėja, tačiau po šio pusmečio galiu drąsiai teigti, jog prie vakarienės restorane paprašyčiau balto vyno taurės, o nebe kokteilio ar alaus boalo. Studijų metu sužinojau nuostabiausių dalykų ne tik apie vyną. Labiausiai džiugino tai, kad įgijau ir naujų žinių apie kavą, arbatą, kurios praverčia dabartinėje darbovietėje, gaminant restorano svečiams arbatą. Įgytomis žiniomis mielai pasidalinau ir su savo kolegomis – vedžiau mokymus apie arbatos gamybą, kilmę, rūšis, jos naudą. Didžiuojuosi savimi, nes nemaniau, kad pavyks susidoroti su nerimu savo pačios vedamų mokymų metu. Manau, kad drąsos ir pasitikėjimo suteikė ir Someljė mokykloje įgytos žinios.
Su nekantrumu laukiu dienos, kai drąsiai ir su pasitikėjimu ne tik kolegoms, o ir garbingiems restorano svečiams išdrįsiu pristatyti baltąjį, raudonąjį ar putojantį vyną. Kai su pasimėgavimu pasakosiu jiems apie visame pasaulyje gaminamus išraiškingo skonio vynus.
Vladas Liepuonius



Spalio vidurys. Po vėjuotą ir lietingą Helsinkį vedžioju rūškaną amerikiečių turistų grupę, o pats nevalingai skaičiuoju net ne dienas, o valandas. Dar apie penkiasdešimt valandų su jais – ir ši trijų savaičių odisėja, o ir visas protu sunkiai suvokiamas dviejų šimtų dienų turistinis sezonas pagaliau baigsis. Vietinė gidė, nepaisydama šiam miestui būdingos darganos, stebina elegancija ir savo gyvybingumu bando įžiebti bent šiokią tokią liepsnelę mano sušalusių keliauninkų širdyse. Ir jai net truputį sekasi. Vienas dėdulė iš Alabamos atkreipia dėmesį, jog ji tikrai ne vietinė, distanciją nuolat laikanti suomė. Per daug jos judesiuose energijos ir šilumos. Nuskambėjus Moldovos vardui, kyla lengvas sumišimas, palydimas klausimo „O kur tai?“ Pasinaudojęs lengvu sąmyšiu, tarsteliu, jog šios vasaros atostogas praleidau būtent Kornelijos (gidės vardas) gimtinėje. Iš nustebimo net šiaurės orą atlaikanti elegancija atsitraukė, ir ore pakibo amžinas klausimas: „Na, ko tau ten?“ Ir išties, ko man ten? Norėjau baigti tyrinėti Balkanų pusiasalį, kurio rytinį pakraštį mano vaizduotė brėžia nuo Kipro iki Moldovos. Norėjau nebrangios šalies (tokios neradau), iš kurios per trumpas atostogas išspausčiau kaip galima daugiau. Norėjau buvimo niekur, to paribio jausmo, kurį Gagaūzija ar Padniestrė turėjo suteikti. Ir, žinoma, norėjau vyno – kitokio, dvelkiančio neatrastų skonių egzotika. Privalu paminėti, jog Moldovos vynai dar iki kelionės man buvo šiek tiek pažįstami. Ryškiai pamenu, kaip mes, trys rimti vaikinai, Ignalinos miškuose šventėme mano garbingą šešioliktąjį jubiliejų, degtinę užgerdami desertiniu kagoru. Mano džiaugsmą paragavus ne visai aiškiomis aplinkybėmis 1 Moldovoje prigijusio vyno, pakeitė nustebimas ir net nuoširdus nusivylimas: kodėl mano tėvai geria visokias bjaurias rūgštynes, kai pasaulyje yra tokio nuostabiai saldaus nektaro? Be jokios abejonės, po tokios gėrimų kombinacijos vakaras baigėsi tragiškai. Manieji sweet sixteen buvo tokie sweet , kad ir šiandien į viską, kas saldu, žiūriu, švelniai tariant, skeptiškai. Kelionėje būtent šį moldaviško „rašalo“ stereotipą ir noriu sau perkurti. Yra gero serbiško, makedoniško, bulgariško ar bosniško vyno, tad kodėl negalėtų būti ir gero moldaviško.
RŪSIAI
Atvykus į sostinę Kišiniovą, savo spalvomis, garsais ir judesiu gatvėje primenantį 2000-ųjų Gariūnus, didysis darbas – „Milesti Mici“ vyno rūsių lankymas. Buvusiose klinčių kasyklose įsikūrę didžiausi vyno rūsiai pasaulyje yra bene labiausiai lankomas turistinis objektas Moldovoje. Tai daugiau nei du šimtai kilometrų požeminių tunelių, iš kurių vyno saugojimui naudojami kiek daugiau nei penkiasdešimt. Ekskursijos metu parodomi vos trys. Čia saugoma apie 2,5 mln. butelių vyno, iš kurių apie 70 proc. raudonieji, 20 – baltieji ir tik 10 – saldieji. Atskiros šeimos iš viso pasaulio išsiperka savas nišas. O štai čia – Kirkorovo ir Pugačiovos vynai. O toje salėje puotavo pats Rusijos prezidentas. Daug plepalų, daug šou, daug nuovargio tą patį mintinai išmoktą
tekstą tūkstančius kartų kartojančios merginos veide. O vynas lieka kažkur fone. Klausimus lydi pažadai plačiau apie vyną papasakoti degustacijos metu.
Bet pažadai ir lieka pažadais. Prieš mane – devynios taurės, bet po visos degustacijos (sausųjų ar saldžiųjų) burnoje lieka tas pats, kiek erzinantis salsvas poskonis. Vynams trūksta ryškumo, stiliaus, unikalumo. Tokie neišraiškingi salstelėję birzgaliukai, kurių gurkštelėjęs tuoj pat užmiršti. Bandymai kalbinti padavėjąsomeljė-jaunuolį ir sužinoti ką nors daugiau atsimuša lyg į sieną. Šalia sėdėjusi pora iš liūdnųjų Rytų gauna svarbiausią informaciją: „Geriau imkit šitą. Saldus ir pigus. O šitas taip, toks mėgėjui ( dlia liubitelia ), toks europietiškas.“
Nuo 2006 m. (papildomi apribojimai – 2013 m.) Rusija taiko Moldovos vynams embargą (apie 80–90 proc. visos vyno produkcijos eksportuota į Rusiją) – tai stiprus smūgis ir taip itin skurdžiai Europos valstybei. Rašant šias eilutes (2024-ųjų lapkritį), Moldova vėl tik per plauką praslydo Europos link. Bet ryšiai su Rusija labai stiprūs. Ir tai susiję ne tik su sovietine praeitimi, kuomet Moldova buvo saule, šviežiais vaisiais ir saldžiais vynais lepinusi respublika. Tam tikra prasme Rusija nukaldino atskirą moldavų tapatybę, kuomet istoriškai Rumunijos Besarabijos regionas po 1812 m. tapo Rusijos imperijos dalimi. Tad saitų su Rusija trūkinėjimas – ne tik ekonominis iššūkis. Ieškoma tautos tapatybės apskritai. Ieškoma ir naujų rinkų, tad ir naujos kokybės.
VYNAI
Grįžęs į Kišiniovą nenoriu pasiduoti ir ieškau geros vyno parduotuvės ar baro pačiame mieste. Palyginti neseniai įsikūrusi „Carpe Diem“ laikosi naujoviškos koncepcijos, nes susitelkusi tik į Moldovos vynus ir yra vieno, ne itin didelio gamintojo atstovai mieste. Tai vienintelė vyninė mieste, kuriame vyno lentynose vis dar dominuoja dideli valstybiniai ar pusiau valstybiniai koncernai, o restoranuose (nes vynas geriamas tik juose) daugiausia dėmesio skiriama interjerui (pavyzdžiui, dešimtys televizorių ekranų rodo liepsną židinyje) ir tik po to maistui ar gėrimams. Pasitikusi mergina sutrinka išgirdusi norą paragauti unikalių Moldovos vynų. Traukiami vynai, turintys priminti Prancūziją, Vokietiją arba Ispaniją. Tokiai strategijai nepasiteisinus, susisiekiama su vyresnia kolege ir… visas vakaras taip ir praeina su telefoniniais pasakojimais bei konsultacijomis. Kompaniją man palaikęs atsitiktinai sutiktas ispanas buvo sužavėtas.
2010 m., ieškodama naujų rinkų, Moldova imasi reformų: įkuriamas prekinis ženklas „Moldovos vynas“, nacionalinis vyno registras, aktyviai deramasi su Europos Sąjunga. 2016 m. šalis susitvarkė savo vyno regionų geografines nuorodas, stengdamasi užtikrinti kokybę ir agresyviau veržtis į europinę rinką 2. Taigi, nors Moldova gali didžiuotis tūkstantmetėmis, dar Romos imperijos 3 laikus siekiančiomis vyndarystės tradicijomis, pažangūs vyndarystės būdai ir supratimas ateina tik dabar.
1 Kahoras (Cahors) yra nedidelis miestelis Prancūzijos pietuose (netoli Tulūzos), kur gaminamas raudonasis vynas, dažniausiai iš ‘Malbec’ vynuogių. Apskritai primena tvirtą Bordo vyną. O štai kagoras yra pastiprintas desertinis vynas iš Moldovos, gaminamas iš ‘Cabernet Sauvignon‘ vynuogių ir, anot legendos, atkeliavęs į šalį caro Petro I iniciatyva (kaip ir viskas Rusijoje). Panašu, kad tai tik legenda, nes Moldova Rusijos imperijos dalimi tapo praėjus beveik šimtmečiui po Petro I mirties. Vynas labai išpopuliarėjo, naudotas liturgijoje ir dideliais kiekiais vartotas Georgijaus Rasputino. O jo giminystė su prancūziškuoju pusbroliu visgi miglota.
2 Remiantis internete rastais duomenimis, apie 60–70 proc. Moldovos vyno keliauja į Europos Sąjungos šalis. Tačiau visi Moldovoje kalbinti vynininkai sutartinai teigė, jog pagrindinė rinka – Kinija, kuriai pirmiausia reikia kiekio, o ne skonių.
3 Pusiau mitas, pusiau tikrovė. Bet didžiuotis netrukdo.

Oficialiai šalyje yra trys vyno regionai plius vienas. Kodru (Codru) – vidurio Moldovoje esantis didžiausias PGI regionas šalyje. Kalvingas, itin derlingu (vynmedžiams gal net per derlingu) dirvožemiu pasižymintis, saulėtas, šiltas regionas, gaivinamas vėsių vėjų iš Vidurio ir Rytų Europos. Vynuogynai dažniausiai įveisiami palei Pruto ir Nistru upes esančiuose kalvų šlaituose. Dominuoja ‘Cabernet Sauvignon’, ‘Chardonnay’, ‘Merlot’, ‘Rhein Risling’ vynuogės. Stefan Voda – Moldovos pietryčiuose esantis regionas, labai stipriai veikiamas Juodosios jūros. Daugiau lietaus, bet ir daugiau šilumos. Beveik jokių žiemų. Vynuogės auga vidutiškai 150 m virš jūros lygio (Kodru dukart aukščiau). Dirvoje daug geležies, tad uogos susiurbia daug mineralų. Dominuoja ‘Cabernet Sauvignon’, ‘Chardonnay’, ‘Merlot’, ‘Pinos Gris’ ir ‘Rara Neagra’ vynuogės. Valul Lui Trajanas (Valul Lui Traian) – trečiasis Moldovos vyno regionas, stipriai veikiamas Viduržemio jūros, ypač pietinė dalis. Siprūs vėsūs vėjai pučia nuo Besarabijos stepės, bet apskritai tai šilčiausias Moldovos vyno regionas su bene seniausiomis vyndarystės tradicijomis. Sutikti vietiniai labiausiai didžiavosi būtent iš Valul Lui Trajano kilusiais vynais. Dirvožemis sluoksniuotas, molingą sluoksnį keičia smėlingas. ‘Cabernet Sauvignon’, ‘Merlot’, ‘Sauvignon Blanc’ – iš esmės dominuojančios vynuogės. Divino (Divin) regionas yra rezervuotas stipriesiems alkoholiniams gėrimams. Šio PGI įvedimas tam tikra prasme buvo revoliucinis, nes pirmą kartą Moldova pabandė užtikrinti stipriųjų gamybos kokybę. Šalis sovietmečiu išgyveno tris dideles antialkoholines kampanijas – 1958, 1972 ir ypač 1985 metais. Paskutinioji šlavė viską – buvo sunaikinta apie 30 proc. visų šalies vynuogynų. Bet ypač agresyviai kautasi su stipriaisiais gėrimais. Tad kokybiški stiprieji gėrimai buvo beveik išnykę ir šio regiono apibrėžimas yra stiprus žingsnis kuriant naują tradiciją. Moldovos brendis (vietiniai vadina konjaku) visada gaminamas
tik iš vietinių vynuogių, tradiciškai distiliuojamas ir bent trejus metus (bet yra ir dešimties bei dvidešimties metų) laikomas ąžuolo statinėse. Šių eilučių autoriui pasisėdėjimas viešbučio bare su keliolika skirtingų brendžių buvo bene ryškiausias skonio patyrimas per visą kelionę. Gėrimai labai aromatingi, skonis kiek aštrokas, bet nurijus lieka malonus, suvaldytas salsvumas. Apskritai Moldovos brendžiai labai prieskoningi, ryškūs, ugningo balkaniško charakterio.
Nors šalyje dominuoja tarptautinės vynuogių veislės, bet vis daugiau dėmesio skiriama vietinėms. Tačiau ne visai sėkmingai. Vynai iš ‘Feteasca Alba’, ‘Feteasca Regala’, ‘Feteasca Neagra’ vynuogių greičiausiai bus iš kaimyninės Rumunijos. Restorane dažniau pasiūlys ‘Legendos’ ir ypač ‘Vioricos’, kurios yra išveistos atitinkamai 1969 ir 1970 metais. Tai hibridinės veislės, neįtikėtinai derlingos ir… prėsko skonio.
Kelionė baigiasi kažkur už Kišiniovo, moldavų supratimu, prabangioje kaimo turizmo sodyboje. Vynas moliniame puodelyje – „autentiška“. Ir vėl saldu. Muskatinis distiliatas samagoniškai aštrus. Bet nykščio didumo balandėliai nuostabūs. Tarp Rumunijos ir surusintos savos tapatybės besiblaškantį Moldovos identitetą aiškiai atspindi ir vynas. Keistos, pusiau savos, pusiau svetimos legendos ir statistikos 4. Kiekybės siekimas ir kokybės ilgesys. Ieškoma autentikos, bet viskas vertinama per europietišką prizmę, norint daryti „rislingus“ ar „bordo“. Ir tas niekada nepranykstantis, net varginantis popsinis salsvumas. Kita vertus, kaimyninė Rumunija labai sparčiai keičiasi į gera, siūlydama vis įdomesnių vynų, ypač iš Transilvanijos. Norisi tikėti, jog veik per atsitiktinumą vis sugebanti Europon praslysti Moldova pajėgs susitvarkyti ir savo vynų portfelį. Ar tiesiog išaugs tą (post) sovietinį polinkį į cukriuką. O gal tiesiog reikia palikti Kišiniovą ir leistis į nuoseklesnę kelionę ieškant mažųjų vyninių?
4 Labai dažnai oficialiuose vyninių internetiniuose puslapiuose statistiniai rodikliai, vynuogių istorijos, kilmės paaiškinimai yra ne iš Moldovos, bet iš Rumunijos arba drauge su Rumunija. Tad nors šalis atskira, bet tuo pat metu drauge.
Karolina Buivydaitė, „Uždraustas sodas“
Kviečiame drauge nerti gilyn į vyną bei patyrinėti vieną iš svarbiausių procesų, kuris iš vynuogių sulčių sukuria tokį sudėtingą ir įvairialypį gėrimą. Šis vyksmas vadinasi fermentacija, o jo vykdytojai
šįkart ir yra pagrindiniai straipsnio herojai. Ne, tai ne vyndariai. Tai mūsų mažieji draugai bei vieni svarbiausių vyninės darbuotojų – mielės.
Nors vynas daromas jau 8 tūkst. metų, tačiau realios fermentacijos priežastys buvo išsiaiškintos palyginus labai neseniai. Dar XIX a. viduryje buvo manyta, kad fermentaciją sukelia irimo procesai. Mielių vaidmenį fermentacijoje pirmasis įžvelgė ir apibūdino Louis Pasteuras, prancūzų mokslininkas, kurį drąsiai galima vadinti ne tik fermentacijos, bet ir visos mikrobiologijos tėveliu. L. Pasteuras nustatė, jog mielės geba cukrų paversti alkoholiu. „Fermentacija – tai kvėpavimas be deguonies“, teigė jis. Šio reiškinio supratimas bei konkrečių mielių rūšių naudojimas užtikrino greitesnę fermentaciją su nuspėjamais rezultatais. XIX a. pabaigoje buvo identifikuota pagrindinė vyno ir alaus mielių rūšis – saccharomyces cerevisiae. Visos saccharomyces genties mielės geba cukrų paversti alkoholiu.
Turbūt galvojate, kad pagrindinis mielių gyvenimo tikslas toks ir yra – atsidurti kokiame nors saldokame skystyje ir padaryti iš jo neblogą alkoholį, o gyvenimo moto galėtų būti „fermentum, ergo sum“?.. Tenka suabejoti. Fermentacija mielėms yra gana neįprastas ir anaiptol nedžiaugsmingas gyvenimo etapas, beveik visada pasibaigiantis jų mirtimi. Bet, kaip sakoma, ir šuo kariamas pripranta, tad mielėms evoliucijoje teko gerokai prisitaikyti prie fermentacinių sąlygų. Galime netgi teigti, kad standartinei vyno taurei (125 ml) paaukojama apie 625 mln. mielių gyvybių, mat aktyvios fermentacijos metu viename mililitre vyno darbuojasi apie 5 mln. mielių. Suprasti mieles tikrai sunku. Šis, atrodytų, toks mažas ir primityvus padarėlis nieko nedaro paprastai. Na, o viską, ką daro, gali daryti ne vienu, o daugybe būdų pasirinktinai. Mielės gali laisvai keisti savo medžiagų apykaitos schemas, gali rinktis, kokiu būdu joms daugintis, ir netgi keisti lytį.
Skirtingos sąlygos veikia mielių medžiagų apykaitą. Kai
mielės gauna daug deguonies bei nedaug cukraus, jos kvėpuoja deguonimi, dauginasi pumpuravimo būdu, o iš cukraus pagamina CO2. Šis metabolizmo tipas vadinamas mielių kvėpavimu, ir jei mielių paklaustume, kas yra normalus gyvenimas, jos nurodytų būtent šį modelį:
• Mielės + deguonis + truputį cukraus = dar daugiau mielių + CO2
Tačiau mums įdomiausia, kas darosi mielėms patekus į skystą aplinką, kurioje daug cukraus, kaip nutinka pradedant daryti vyną:
• Mielės + cukrus + skysta aplinka = dar daugiau mielių + etanolis + CO2 + metabolizmo šalutiniai produktai + šiluma
Mielių dėka vyne atsirandantys aromatai bei skoniai yra tai, ką formulėje pavadinome metabolizmo šalutiniais produktais. Gal mielėms jie ir šalutiniai, bet tik ne mums. Tad pažiūrėkime atidžiau, ką fermentacijos metu sukuria mielės.
CUKRAUS METABOLIZMAS, ARBA GLIKOLIZĖ
Pagrindiniai fermentuojami cukrai yra gliukozė ir fruktozė. Mielės niekada nesuvalgo viso cukraus, nedidelė jo dalis lieka vyne, subalansuodama rūgštį bei teigiamai paveikdama poskonį. Likutinis cukrus sausuose vynuose dažniausiai sudaro apie 2 g/l.
Tai fruktozės bei gliukozės likučiai, taip pat nefermentuojami cukrūs: ksilozė, arabinozė, ribozė. Pradžioje mielės gliukozę ir fruktozę paverčia piruvatu, o pastarąjį toliau išskaido į etanolį ir CO2. Šiame procese dar pagaminama glicerolio, acetaldehido ir acto rūgšties.
Glicerolis – tai saldokas, klampus alkoholis. Aukštesnėje temperatūroje jo pagaminama daugiau, todėl didesni glicerolio

Ką mielės duoda vynui. Mielių metabolizmo produktai bei jų aromatai (aut. Karolina Buivydaitė, Domas Burnickis – „Uždraustas sodas“)
kiekiai dažnesni raudoname vyne. Tai teigiamas komponentas, suteikiantis vynui kūno, arba svarumo, bei „užapvalinantis“ poskonį.
Acetaldehidas – ne itin žavingas komponentas, laimei, vykstant fermentacijai, mielės iš jo padaro etilo alkoholį ir CO2, tad vyne jo lieka nedaug. Cheminė etanolio oksidacija ilgainiui didina acetaldehido kiekį bręstančiame vyne, todėl senuose, oksiduotuose vynuose pradedame užuosti sudaužytų obuolių aromatą.
Acto rūgštis glaudžiai susijusi su vienu iš vyno kokybės parametrų – lakiosios rūgšties kiekiu vyne (angl. volatile acidity, VA) bei sudaranti virš 90 proc. visų lakiųjų rūgščių vyne. Ji suteikia vynui aštraus ir rūgštaus actiško skonio bei kvapo. Sausame vyne jos tegali būti labai mažai, tačiau šiek tiek didesni kiekiai suteikia kompleksiškumo ir savitos dermės saldžiajam, kekeriniam bei ledo vynui.
LAKIEJI SIEROS JUNGINIAI
Tai vieni kvapniausių ir stipriausiai vyno aromatą galinčių paveikti komponentų. Jie tarsi sparnai, galintys nešti aromatą aukštai ir toli, deja, pats aromatas ne visada sukelia pasigėrėjimo atodūsį. Jei šių junginių koncentracija maža, dauguma jų suteikia vaisiško aromato, tačiau jei didesnė, atsiranda redukcinių aromatų: supuvusių kiaušinių, nuotekų, degtukų, kopūstų, gumos, svogūnų ar česnakų. Beveik viskas, kas vynui suteikia „redukcinį charakterį“, yra sieros junginiai. Dalis sieros junginių vyne esti savaime, tačiau daugumos jų atsiradimą nulemia būtent tai, kaip mielės pasielgs su misoje esančiais sieros šaltiniais. O kartais jos elgiasi labai negražiai.
Vandenilio sulfidas (H2S) – tai, matyt, blogiausia, ką mielės gali padaryti iš sieros junginių. Su šiuo akibrokštu yra susidūręs kone kiekvienas vyndarys: fermentacijos metu vynas ima skleisti supuvusių kiaušinių smarvę. Priežastys tokios: dažniausiai vyno misoje nėra pakankamo organinių sieros junginių kiekio. Mielės – labai nagingi padarėliai, ir jei joms ko nors trūksta, jos sukasi su tuo, kas yra po ranka, tad ima sierą iš neorganinių junginių – sulfato ir sulfito. Šiame procese H2S yra tik tarpinis metabolinis produktas. Ar jis bus toliau sėkmingai išskaidytas, ar pasiliks vyne ir pagadins jo kvapą, nulemia azoto, svarbaus mielių mitybai, kiekis misoje: jei jo pakankamai, mielės savo darbą užbaigs, suskaidydamos H2S. Tačiau jei misoje trūksta azoto, procesas nutrūks, ir H2S ims kauptis. Tad fermentacijos metu reikia dažnai stebėti (tiksliau, uostyti) procesą, ir pajutus šiuos nemalonius kvapus tuojau duoti mielėms azoto. Pastebėta, kad gebėjimas gaminti H2S smarkiai priklauso nuo konkrečios mielių rūšies, tad selekcijos būdu jau yra sukurta mielių, kurios tiesiog nesugeba prigaminti H2S. Benzilo merkaptanas (fenilmetano tiolis) – tai skelto titnago, sudegusio degtuko aromatai. Kas bandė įskelti ugnį titnagu ar patrinti du titnagus vieną į kitą, tas žino, apie ką kalbama. Šis specifinis kvapas kartais laikomas tam tikrų baltųjų vynų savybe, pavyzdžiui, šabli arba šardonė iš vėsesnių Australijos regionų. Ir nors dabar madinga titnagiškas natas vyne sieti su terroir ar titnago kiekiu vynuogyno dirvožemyje, tačiau tai labiau rinkodaros triukas negu tiesa. Uolienos tipai ir vyno savybės yra susijusios netiesioginiu ir žymiai sudėtingesniu ryšiu, nei dažnai bandoma pateikti. Titnagiškas vyno aromatas atsiranda ne dėl regiono ar

titnago kiekio dirvožemyje, o dėl sieros junginių, susidarančių fermentacijos metu. Šis terminas galėtų reikšti veikiau stiliaus ypatybę nei terroir nulemtas savybes. Skeltas titnagas, šlapias akmuo, kreida – visi šie apibūdinimai dažnai siejami ir su epitetu „minerališkas“. Tas „minerališkas“ aromatas stiprėdamas kažkuriuo metu tampa „reduktyvus“. Viskas priklauso nuo lakiųjų sieros junginių kiekio. Taigi, jeigu vyndariui pasiseka išlaviruoti ir pasiekti itin subtilų reduktyvaus aromato balansą, kai sieros junginiai lyg plazdena, lyg visai išnyksta ore, toks vynas gali būti apibūdintas kaip minerališko aromato. Tai subtiliausia, ką galima padaryti su lakiaisiais sieros junginiais.
Merkaptanai – tai „blogieji“ tioliai. Merkaptanu yra kvėpinamos bekvapės gamtinės dujos, kad galima būtų lengvai pajusti jų nuotėkį. Tad kvapą, manau, įsivaizduojate.
Glutationas (GSH) – tai nelakus sieros junginys, turintis stiprių antioksidacinių savybių. Šios savybės padeda išsaugoti vyne oksidacijai jautrius aromatinius junginius, ypač tiolius.
TIOLIAI
Tai taip pat yra lakiųjų sieros junginių grupė, tiesiogiai priklausanti nuo mielių. Kai kurių veislių, pavyzdžiui, ‘Sauvignon Blanc’, ‘Colombard’, ‘Verdejo’, ‘Chardonnay’, ‘Riesling’ vynuogėse yra sudėtingų junginių, vadinamų tiolių prekursoriais. Tiek vynuogėse, tiek jų sultyse šie junginiai yra neužuodžiami – jie nelakūs. Kai kurios mielės turi specifinių fermentų, kurie vykstant metabolizmui gali „nukąsti“ ir atlaisvinti tiolius, padarydami juos lakius. Ir staiga vynas įgauna aromatų, kurie iki tol buvo neužuodžiami. Kiek netikėta, kad šią sudėtingą schemą įvaldė ir kraftiniai aludariai, sukę galvas, ką čia dar padarius, kad savo
iki negalėjimo „užapyniuotiems“ ir aromatingiems IPA alums suteiktų dar daugiau aromato. Alaus mison tiesiog įdedama tiolių prekursorių turinčios vynuogių veislės išspaudų (o daugiausia prekursorių ir slepiasi būtent odelėse) ir jiems pritaikytų mielių – štai jums ir pasifloromis bei tropiniais vaisiais kvepiantis sovinjoniškas IPA alus.
Tioliai:
• 4MMP – juodųjų serbentų šakelės, buksmedis, zuikiakrūmis. Jei koncentracija didelė – kačių šlapimo „aromatas“;
• 3MH – citrusai: žaliosios citrinos, greipfrutai, apelsinai, pasifloros;
• 3MHA – pasifloros, gvajavos, agrastai. Jei koncentracija didelė – prakaito kvapas;
• 4MMPOH – citrinų žievelės, citrusai.
AUKŠTESNIEJI ALKOHOLIAI
Mielės šiuos alkoholius pagamina iš cukrų ir amino rūgščių. Palyginimui, etanolis yra maža, linijinė molekulė, turinti du anglies atomus. O aukštesnieji alkoholiai turi tris ar daugiau anglies atomų, jų molekulės yra ilgesnės, sudėtingesnės, todėl galvą nuo jų skauda labiau. Tai išties aromatingi junginiai, sukuriantys vyne kompleksiškus, sudėtingus aromatus, o blogesniu atveju – „karštus“, alkoholiškus, skiedikliškus, deginančius kvapus. Šių alkoholių susidaro daugiau, jei vynas fermentuojamas aukštesnėje temperatūroje, tad raudonajame vyne jų dažniausiai būna daugiau nei baltajame.
Izoamilo alkoholis – gausiausiai vyne aptinkamas aukštesnysis alkoholis, turintis alkoholiško, viskio, vaisių aromato. Naudojamas sintetinių vaisių aromatų (bananų, kriaušių, vyšnių) gamyboje.
• Izobutilo alkoholis – eteriškas, vyniškas, alkoholiškas aromatas.
• Metionolis – žoliškas, daržoviškas, sieriškas, virtų daržovių, bulvių aromatas.
• Fenetilo alkoholis (2-feniletilas) – gėliškas, rožių aromatas.
ESTERIAI
Gausi lakių ir kvapnių junginių grupė. Esteriai gali būti tiek natūraliai esantys vynuogėse, tiek mielių veiklos produktas. Šįkart minėsime tik tuos, kurie sukuriami mielių. Šių esterių yra dvi grupės: acetatų esteriai ir etilo esteriai.
ACETATŲ ESTERIAI
Jie susidaro iš kurio nors aukštesniojo alkoholio, prisijungiant acto rūgščiai. Šis susijungimo procesas – hidrolizė – gali vykti į abi puses, tad vynui bręstant bei susidarius tinkamoms sąlygoms (žemam pH ir aukštesnei temperatūrai) aromatas gali dingti, vėl išsiskaidydamas į acto rūgštį ir aukštesnį alkoholį.
Šie esteriai suteikia vynui skanių, stiprių vaisių aromatų. Darant vyną iš neutralių veislių, esteriai gali gerokai pagelbėti šiaip jau blankiam ir neišraiškingam vynui. Galima sakyti, kad aromatas sukuriamas tiesiog iš nieko, tereikia mielių, gebančių gaminti daug esterių, ir pakankamai maisto mielėms, kad galėtų visa tai sukurti. Esterių aromatai stipriausi būna praėjus pusei metų po fermentacijos; vėliau dėl hidrolizės procesų jie gali ir visai pradingti.
• Izoamilo acetatas – bananų, kriaušių aromatas. Turi savybę sustiprinti ir kitus aromatus, veikia kaip savotiškas aromatų stipriklis.
• Izobutilo acetatas – vaisiškas, obuolių aromatas.
• Heksilo acetatas – žalių obuolių, gėliškas, vaisiškas aromatas.
• Fenetilo acetatas – saldus, gėliškas, medaus, aviečių aromatas.
ETILO ESTERIAI
Jie atsiranda jungiantis etanoliui ir riebalų rūgštims. Šie esteriai kukliau prisideda prie vyno aromatų nei itin aromatingi acetato esteriai. Tačiau mažesni kiekiai teigiamai paveikia vyno kompleksiškumą, didesni gali pridaryti problemų.
Etilo acetato mažas kiekis suteikia vynui vaisiškumo ir kompleksiškumo. Didesnis suteikia specifinį, nemalonų nagų lako valiklio aromatą bei sustiprina lakiosios rūgšties pojūtį. Tai gana dažna vyno yda. Tiesa, prigaminti etilo acetato gali ne tik mielės, bet ir acto rūgšties bakterijos.
• Etilheksanoatas suteikia vaisiško, brendiško, braškių, anyžių aromato.
• Etilo butanoatas suteikia vaisiško, obuolių aromato.
• Etilo oktanoatas suteikia muiliško, bananų, kriaušių aromato.
• Etilo dekanoatas suteikia aliejiško, gėliško, vaisiško aromato.
AUTOLIZĖ
Mielės net po mirties nenustoja rūpintis vynu. Procesai, vykstantys pomirtiniame mielių gyvenime, vadinami autolize: tai mirusių mielių „susinaikinimo mechanizmas“, kai veikiant įvairiems fermentams mieles sudariusios medžiagos išskaidomos. Jos papildo vyną aminorūgštimis, riebalų rūgštimis ir manoproteinais polisacharidais. Vyno laikymas su negyvomis mielėmis vadinamas sur lie. Šis procesas pažįstamas ir putojantiems vynams, daromiems su antrine fermentacija buteliuose. Laikymas su mielėmis pagerina vyno organoleptines savybes: suteikia svarumo, kremiškumo, kompleksiškumo, taip pat užtikrina spalvos stabilumą, suteikia vynui riešutiškų, skrebučio, kepinių, mieliškų aromatų.
VYNINĖJE
Paminėjome tik kai kuriuos svarbiausius mielių sukuriamus komponentus. Iš tiesų jų yra žymiai daugiau. Mielės geba ne tik vienu metu vykdyti daugybę sudėtingų procesų. Jos gali strateguoti, ką ir kaip joms daryti. Fermentacinėje aplinkoje jos gali rinktis: ar, kaip joms ir įprasta natūralioje aplinkoje, kvėpuoti deguonimi (kurio, ištirpusio vynuogių sultyse, yra pakankamai) ir negaminti jokio alkoholio, ar visgi pereiti į kitą metabolizmo schemą – nustoti kvėpuoti deguonimi ir užsiimti fermentacija. Mielių tikslas yra tiesiog vienaip ar kitaip gauti energijos, reikalingos augimui ir dauginimuisi. Abi metabolizmo schemos tai užtikrina. Tačiau energijos gavyba fermentavimo būdu yra dešimt kartų neefektyvesnė, negu kvėpuojant deguonimi. Kitaip tariant, alkoholinė fermentacija mielėms visai nenaudinga. Vis dėlto, nepaisant nieko, jos renkasi pereiti į anaerobinės fermentacijos schemą ir dovanoti žmonijai tauriųjų gėrimų. Juk jei ne šis
herojiškas ir pasiaukojantis mielių sprendimas, tai, kaip sakoma, „sėdėtume sausai“ ir skaitytume žurnalą apie bites. Šis fenomenas vadinasi Krabtrio efektas (pagal jį ištyrusio anglų biochemiko Herberto Grace’o Crabtree’o pavardę). Tik saccharomyces cerevisiae ir dar kelios mielių rūšys gali taip elgtis, todėl mielės skirstomos į Krabtri-teigiamas ir Krabtri-neigiamas rūšis. Iš pažiūros nelogiškas mielių sprendimas, be abėjo, yra gudrybė. Juk į fermentacinę aplinką natūraliai patenka ne tik saccharomyces cerevisiae mielės, bet ir daugybė kitokių mielių, kurių dauguma nėra prisitaikiusios gyvuoti esant didesnei etanolio koncentracijai. Ir visos jos konkuruoja dėl maisto šaltinio – gliukozės. Pasirinkusios alkoholinę fermentaciją, mielės laimi konkurencinę kovą: pagal šią metabolizmo schemą jos gali daugintis žymiai greičiau ir kiekybe užgožti konkurentes; o didindamos etanolio kiekį, jos mažina kitų rūšių išgyvenamumą. Tiek ši, tiek kitos mielių gudrybės rodo viena – šis padaras yra tikra fermentavimo mašina, profesionali ir prisitaikiusi prie įvairių fermentacinių sąlygų taip, kad visada būtų pirma, visada laimėtų konkurencinę kovą ir kad būtent ji sufermentuotų mums alkoholinius gėrimus. Tai patvirtina ir archeologija: puodų šukėse, amforose – visur, kur buvo fermentuotas alkoholis randami ne kas kita, o saccharomyces cerevisiae pėdsakai. Tad nuo seniausių laikų iki pat dabar šios mielės yra dažniausiai ir gausiausiai sutinkama rūšis ten, kur „vyksta reikalai“: fermentacinės talpos, įranga, visa vyninės aplinka, ir keli ar keliolika metrų nuo vyninės pastato. O toliau?.. O toliau ji beveik dingsta.
DOMESTIKUOTA AR LAUKINĖ?
Paminėjome tik kai kuriuos svarbiausius mielių sukuriamus komponentus. Iš tiesų jų yra žymiai daugiau. Mielės geba ne tik vienu metu vykdyti daugybę sudėtingų procesų. Jos gali strateguoti, ką ir kaip jai daryti. Fermentacinėje aplinkoje jos gali rinktis: ar, kaip jai ir įprasta natūralioje aplinkoje, kvėpuoti deguonimi (kurio, ištirpusio vynuogių sultyse, yra pakankamai) ir negaminti jokio alkoholio, ar visgi pereiti į kitą metabolizmo schemą – nustoti kvėpuoti deguonimi ir užsiimti fermentacija. Mielių tikslas yra tiesiog vienaip ar kitaip gauti energijos, reikalingos augimui ir dauginimuisi. Abi metabolizmo schemos tai užtikrina. Tačiau energijos gavyba fermentavimo būdu mielei yra dešimt kartų neefektyvesnė, negu kvėpuojant deguonimi. Kitaip tariant, alkoholinė fermentacija mielėms visai nenaudinga. Vis dėlto, nepaisant nieko, jos renkasi pereiti į anaerobinę fermentaciją ir dovanoti žmonijai tauriųjų gėrimų. Juk jei ne šis herojiškas ir pasiaukojantis mielių sprendimas, tai, kaip sakoma, „sėdėtume sausai“ ir skaitytume žurnalą apie bites. Šis fenomenas vadinasi Krabtrio efektas (pagal jį ištyrusio anglų biochemiko Herberto Grace’o Crabtree’o pavardę). Tik saccharomyces cerevisiae ir dar kelios mielių rūšys gali taip elgtis, todėl mielės skirstomos į Krabtri-teigiamas ir Krabtri-neigiamas rūšis. Iš pažiūros nelogiškas mielių sprendimas, be abėjo, yra gudrybė. Juk į fermentacinę aplinką natūraliai patenka ne tik saccharomyces cerevisiae mielės, bet ir daugybė kitokių mielių, kurių dauguma nėra prisitaikiusios gyvuoti esant didesnei etanolio koncentracijai. Ir visos jos konkuruoja dėl maisto šaltinio – gliukozės. Pasirinkusios alkoholinę fermentaciją, mielės laimi konkurencinę kovą: pagal šią metabolizmo schemą jos gali daugintis žymiai greičiau ir kiekybe užgožti konkurentes; o didindamos etanolio kiekį, jos mažina kitų rūšių išgyvenamumą. Tiek ši, tiek kitos
mielių gudrybės rodo viena – šis padaras yra tikra fermentavimo mašina, profesionali ir prisitaikiusi prie įvairių fermentacinių sąlygų taip, kad visada būtų pirma, visada laimėtų konkurencinę kovą ir kad būtent ji sufermentuotų mums alkoholinius gėrimus. Tai patvirtina ir archeologija: puodų šukėse, amforose – visur, kur buvo fermentuotas alkoholis, randama ne kas kita, o saccharomyces cerevisiae pėdsakai. Tad nuo seniausių laikų iki pat dabar šios mielės yra dažniausiai ir gausiausiai aptinkama rūšis ten, kur stovi fermentacinės talpos, vyno gamybos įranga, t. y. visoje vyninės aplinkoje ir keli ar keliolika metrų nuo vyninės pastato. O toliau?.. Toliau ji beveik dingsta. Ir tai yra dar viena keistenybė. Pagal biologinės nišos teoriją, rūšis egzistuoja toje aplinkoje, prie kurios ji yra labiausiai prisitaikiusi. Ir mintyse jau skriejame į vynuogyną ir ieškome mūsų mielių ant vynuogių ar vynmedžių. O ten – „nieko nėra namuose“. Tiksliau, yra, bet visiškai ne tai, ko tikėjomės: ant vynuogių saccharomyces cerevisiae santykis su kitomis mielėmis yra 1 : 20000. Tai itin menki kiekiai. Bandant išsiaiškinti šių mielių paplitimą, buvo vykdomos paieškos tiek arti žmogaus ūkinės veiklos, tiek toli nuo jos. Iš visų tirtų vaisių tikimybė surasti šią rūšį ant vynuogių buvo mažiausia (1,8 %), o didžiausia – ant kriaušių (28 %); apskritai tikimybė aptikti šias mieles ant vaisių buvo mažesnė (6,5 %) negu ant žemės (10,8 %) ar medžių žievės (16,5 %). Miško dirvožemyje paplitimas buvo didesnis (13,7 %) nei sodų dirvožemyje (9,1 %). Tyrimai parodė, kad saccharomyces cerevisiae paplitusi gan tolygiai, be ryškesnio skirtumo tarp gamtinės ar ūkinės aplinkos. Visiškai ne taip, kaip daugelis tikėjosi. Žinoma, tai nepaneigia fakto, kad saccharomyces cerevisiae mielių yra aptinkamos vynuogynuose ir nemažai tokių rūšių yra netgi komercializuotos, nurodant regioną ar vynuogyną, kur buvo rastos. Tačiau kad ir kaip žiūrėtume, rezultatų neįmanoma pritempti prie biologinės nišos teorijos, jei manytume, kad vėliau fermentuojamos uogos yra natūrali šių mielių buveinė. Ant uogų ši rūšis itin reta, tačiau viskas staiga pasikeičia, kai didelis kiekis uogų sutraiškomas ir visa uogų masė homogenizuojasi žmogaus sukurtoje, nenatūralioje aplinkoje. Va čia saccharomyces cerevisiae iškart parodo, kas yra situacijos šeimininkas! Lyg čia ir būtų jos natūrali biologinė niša. Labai tikėtina, kad taip ir yra. Tereikia įrodyti, kad mūsų fermentacijos meistrė buvo domestifikuota žmonijos istorijos priešaušryje kartu su ožkomis, vilkais ir grūdinėmis kultūromis. Genetiniai saccharomyces cerevisiae tyrimai rodo, kad pati rūšis yra laukinė, t. y. nedomestifikuota. Ypač kolonijos, gyvenančios ant medžių žievės ir miškuose. Tačiau skverbdamiesi gilyn į šios rūšies geneologinio medžio tankmę pamatysime, kad kadaise tos dvi šakos – laukinė miškų ir naminė vyninės – išsiskyrė. Remiantis genomo tyrimais, tai galėjo nutikti prieš 9 tūkst. metų. Tai beveik sutampa su archeologiniais duomenimis, nes seniausi vyno fermentacijos pėdsakai aptikti Gadachrili Goroje, neolito gyvenvietėje Sakartvele, ir datuojami 8 tūkstm. Galima sakyti, kad kaip rūšis, saccharomyces cerevisiae yra mielės klajoklės: jos nėra prisitaikiusios prie konkrečios biologinės nišos, tačiau yra plačiai pasklidusios įvairioje aplinkoje. O per tūkstantmečius puikiai fermentuoti išmokusios vyno mielės saccharomyces cerevisiae randamos ir vyninėje – ten, kur joms ir vieta.














Teksto autorė – Agnė Dovydaitytė
Iliustracijos – R. Daskevičiaus nuotraukos, atspindinčios esminius jo karjeros etapus
Vienoje iš prekybos centro kavinių, apsuptas dirbtinės šviesos ir spalvingų parduotuvių iškabų, maisto fotografas
Robertas Daskevičius kviečia mus pažvelgti į savo pasaulį. Gal ne tiek kviečia, kiek įsileidžia.
Roberto akis aštri detalėms: jis atkreipia mano dėmesį į tai, kad skirtingos šviesos šaltinių kombinacijos šioje susitikimo erdvėje keltų iššūkį net patyrusiam fotografui. Tačiau šiandieniniame skaitmeniniame amžiuje visi – nuo atsitiktinių lankytojų iki maisto tinklaraštininkų – nuolat fotografuoja savo patiekalus ar gėrimus. Mano pašnekovas samprotauja: kodėl gi tiesiog nepasimėgavus momentu, kompanija, maistu? „Pereinam į gyvenimo modelį, kai nebe mes formuojam, o mums formuoja. Kalbu apie socialinę mediją ir jos reikšmę mūsų gyvenime. Man dėl to pikta.“ R. Daskevičius laikomas vienu geriausių Lietuvos maisto fotografų. Jo darbai sulaukė pasaulinio pripažinimo, papuošė „Michelin“ vadovą; Roberto kadrai yra ir viena svarbiausių projekto „30 geriausių restoranų Lietuvoje“ sudedamųjų dalių; jo knygai „52 kartai“ pozavo ir kalbėjo geriausi šalies šefai.
Apie R. Daskevičiaus fotografavimo stilių ir techniką tegu pasakoja jo fotografijos, o mes klausiame apie tai, kas slepiasi anapus objektyvo. Beje, romantiškos istorijos, kaip atrado savo aistrą fotografijai, R. Daskevičius, pasirodo, neturi.
Kaip prasidėjo tavo, kaip fotografo, kelias? Ar tai vaikystės svajonė ar atsitiktinumas?
Laiminga krizės pasekmė. Blogi dalykai, kurie atsitinka, atveria kitus kelius.
2004 metais dirbau IT sektoriuje, prasidėjus krizei, reikėjo ieškotis kažko kito. Tuo metu kaip tik kartais padėdavau organizuoti renginius, prireikus išsitraukdavau ir fotoaparatą, nufotografuodavau. Vėliau palygindavau savo nuotraukas su užsakomų fotografų ir kažkaip natūraliai ten įnėriau.
Aišku, viena yra kai sau kažką fotografuoji, kita – kai reikia vystyti verslą nuo A iki Z ir nuo nulio: nuolatinis mokymasis, užsakymų paieška, investicija į techniką…
Tai nepradėjai iš karto nuo maisto?
Bandžiau viską: vestuvės, konferencijos, renginiai, architektūra... Kas paskambindavo, ten eidavau. Ilgainiui išsigrynino kelios temos, tarp kurių, žinoma, buvo ir maistas.
Bet ir šiuo metu fiksuoju ne tik gastronomiją. Ten galbūt jaučiuosi komfortabiliausiai ir žinau daugiausiai, bet neišeiti iš savo komforto zonos irgi nėra gerai, tad mane galima pamatyti ir renginiuose, ir reklaminėse technologijų įmonių fotosesijose.
Ar vizuali restoranų komunikacija juda link profesionalumo, o gal atvirkščiai – daugėja organiško turinio? Kitaip sakant, ar netrūksta darbo?
Darbo netrūksta, bet tendencijos dvejopos. Viena vertus, „Michelin“ dėmesys Lietuvai ir 30-uko grįžimas motyvavo ne vieną restoraną pažiūrėti, kaip jis atrodo išorėje, išaugo poreikis profesionalių nuotraukų, kurios apie restoraną pasakotų žmonėms, nieko apie jį nežinantiems, išskyrus tai, kas matosi restoranų giduose ir socialiniuose tinkluose.
Kita vertus, tiek restoranų finansinė situacija, tiek organiško turinio populiarėjimas reiškia, kad kai kurie restoranai padeda turinį kurti patys – paprasčiau, greičiau, pigiau. Ilgainiui jie nusivilia, supranta skirtumą ir laiko sąnaudas darant net paprastą, bet tvarkingą nuotrauką ir vėl grįžta prie profesionalių nuotraukų.

Kiti panaudoja kelias profesionalias, kelias buitines, tačiau bendras vaizdas tada atrodo tiesiog neestetiškai. Todėl daugėja užsakymų padaryti ne tik profesionalių patiekalų nuotraukų, bet ir užfiksuoti gyvenimiškų situacijų iš virtuvės, restorano gyvenimo.
Tie, kas nesamdo profesionalų – pasmerkti?
Ne, tikrai galima ir su telefonu pasidaryti normalių nuotraukų ir sukurti vientisą vizualinę restorano stilistiką. Bet ir tai reikalauja tam tikrų sąlygų. Kai kurių restoranų virtuvių apšvietimas toks, kad net profesionalui keltų iššūkių.
Anksčiau būdavo paprasčiau – dienos šviesos lempos, ir viskas. Biure – biuro apšvietimas. Prieš važiuodamas žinai, kokią techniką pasiimti, ir to užteks. Dabar – nebežinai, ko tikėtis, į fotosesijas vežiesi tikrai daug.
Restorano erdvėje su tais iššūkiais susiduria klientai. Užsisako patiekalą, nufotografuoja, pasidalina socialiniuose tinkluose, užtagina restoraną. O nuotraukoje viskas atrodo ne tik neskaniai, bet tiesiog blogai. Ir ką tada daryti? Norisi pasidalinti klientų turiniu, bet maistas neatrodo reprezentatyviai…
Tai kaip tas sąlygas sukurti ar susikurti? Gal yra kokių taisyklių ar patarimų?
Kiekviena situacija tokia individuali, kad ją galima įvertinti tik esant vietoje. Universalių tiesų nėra.
Gal apšvietimas netinkamas, o gal kampas, gal stalas… Žmogus juk atėjo pavalgyti, bet kažkodėl jis galvoja, kad yra
fotografas. Ir kartais pamiršta džiaugtis ta akimirka. Tas pats ir su renginiais. Organizatoriai, net pasisamdę profesionalų komandą, vis tiek patys filmuoja, fotografuoja, kaip išmano. Ką jie su ta medžiaga darys? Dažniausiai lieka nepanaudota. Geriau palikti tai profesionalams ir pasimėgauti savo renginiu.
Vis dėlto mėgstantiems fotografuoti maistą knygoje esu pateikęs keletą „fotopatarimų“, kurie gali praversti norintiems į maisto fotografiją pažiūrėti profesionaliau.
Sutrumpintos ištraukos iš R. Daskevičiaus knygos „52 kartai“ ŠVIESA
• Susiraskite geriausiai apšviestą vietą, pavyzdžiui, prie didelio lango.
• Naudokite vieną šviesos šaltinį.
• Naudokite atšvaitus, pavyzdžiui, baltą popieriaus lapą.
• Fotografuokite iš priešingos pusės, nei sklinda šviesa.
• Nepasikliaukite automatiniais telefono ar fotoaparato režimais.
RAKURSAI IR STILIZAVIMAS
• Išbandykite įvairius rakursus.
• Negaiškite per daug laiko – maistas praranda išvaizdą.
• Pirmiausia rakursas, po to – stilizavimas, papildomi aksesuarai.
• Nebijokite maisto prakąsti, atpjauti, patrupinti – patiekalas atrodys tikras.
TECHNIKA
• Investuokite į gerus fiksuoto židinio objektyvus.
• Naudokite trikojį.

Iš asmeninio projekto „52 kartai”. Nuotrauka pateko į trumpąjį sąrašą pasauliniame maisto fotografijos konkurse Londone.
Mano pirmas fotografuotas knygos „viršelis”, kuris pasauliniuose maisto ir vyno knygų apdovanojimuose pateko į finalą. (Geriausia kulinarinė knyga Lietuvoje ir antra geriausia kulinarine knyga Rytų Europoje – tarptautiniai apdovanojimai „Gourmand World Cookbook Awards 2013“)



• Nustatykite tinkamą baltos spalvos balansą. Jei nežinote, kas tai, išsiaiškinkite.
• Žinokite visas fotoaparato funkcijas.
• Daug fotografuokite.
• Naudokite specializuotas redagavimo programėles: „Lightroom“, „Priime“, „Snapseed“.
KITI PATARIMAI
• Naudokite pagalbininkus: kopėčias, vandens purkštuką, lipnią gumą įrankiams prilaikyti, pincetą, ausų krapštuką lėkštėms pavalyti ir t. t.
• Nuolatos tobulinkite įgūdžius: ieškokite įkvėpimo internete, bet nekopijuokite, pirmiausia investuokite ne į įrangą, o į knygas ir mokslus.
• Fotografuokite pavalgę, kad susikoncentruotumėte į fotografiją, ne į alkį.
Ar pats restoranas neturėtų būti motyvuotas sukurti tą fotogenišką aplinką ir taip „įdarbinti“ fotografuojančius svečius?
Restoranai dažnai žino savo apšvietimo problemą, bet retai kuris tai sprendžia. Galiu ant pirštų suskaičiuoti apšvietimą susitvarkiusius restoranus. Žinau, kad tikrai yra reikalų tai padaryti ir net nėra daug profesionalų, kurie galėtų padėti šiuo klausimu.
Skamba sudėtingai… Ką daryti paprastam maisto blogeriui ar restorano svečiui?
Mėgautis maistu.

Jau keletą metų fotografuoji vyno ir desertų derinių čempionatą „Wine + Dessert“. Šiais metais duodamas interviu neatrodei labai patenkintas, kaip kai kurie desertai buvo patiekti. Gal gali plačiau pakomentuoti?
Ne tik čempionate, bet ir restoranų kasdienybėje kartais žmonės galvoja, kad platinti (t. y. išdėlioti lėkštėje – red.) gali bet kas. Nieko sudėtingo. Kažkokie trupinukai, tada masė kažkokia, o tada papuošimas – traškučiais, morengais ar dar kuo, kas paslėps trūkumus.
Daug šefų nuėjo paprastesnio desertų išdėliojimo keliu, nes, greičiausiai, sukūrę ką nors įmantresnio supranta, kad taip išdėlio -
ti geba tik jie vieni. O atkurti juos tenka neretai visai komandai. Kitas aspektas – dubenėliai. Jie padeda svečiui ar teisėjui vienu šaukštu paimti visus ingredientus. Bet nuotraukose jie nebūtinai atrodo patraukliausiai. Žinoma, pirmiausia vertinamas skonis, bet atradus originalų patiekimą, deserto vertė gali išaugti – jis gali tapti traukos tašku, kuriuo bus dalinamasi.
Kalbėjai, kad žmonės restorane pamiršta pasidžiaugti maistu. Ar pats spėji pasidžiaugti savo pasiekimais, ramiai peržiūrėti nuotraukas?
Norėtųsi daugiau. Pavyzdžiui, prieš keletą metų, kai buvo išleista mano maisto ir fotografijų idėjų knyga „52 kartai“, prasidėjo karantinas. Visoje restoranų industrijoje sukilo ir kainos, ir baimės. Viskas galiausiai pasibaigė, bet į senas vėžes grįžti ne taip paprasta.
Dabar atrodo, kad nepakankamai pasidžiaugiau tuo pasiekimu, prie kurio tiek dirbau. Norėtųsi atsisėsti, pavartyti, vėl suburti komandą.
Bet visko išmokstama. Džiaugtis momentais ir pasiekimais mane šiuo metu moko šeima. Seniau kaip durnius į visas šeimos keliones tempdavausi didelę tašę technikos, o dabar mėgaujuosi momentu. Nuotraukas vis tiek pasidarome, net atsispausdiname, bet esmė yra ne tai.
Po tiek metų fotografijoje ar vis dar mokaisi ir tobulėji? Iš kur semiesi įkvėpimo?
Talento aš neturėjau. Visa, ką turiu, – mokymosi ir nuolatinio tobulėjimo rezultatas. Dabar mokytis daug lengviau, savo karjeros pradžioje pirkdavau begales valandų mokymų medžiagos ir žiūrėdavau. Šiandien technologijos net leidžia turėti interaktyvius nuotolinius mokymus su savo autoritetais kitame pasaulio krašte, individualias sesijas ir pan.
Tačiau vienas didžiausių lūžio taškų ar supratimo momentų mano karjeroje buvo, kai pradėjau fotografuoti backstage kino aikštelėse. Stebėdavau, kaip dirba 50 ar 100 žmonių komandos, kaip preciziškai viskas vyksta, kaip jie susistato apšvietimą – viskas sustyguota, apskaičiuota, suplanuota ir pan. Ir dabar man juos įdomu stebėti – kaip kinta technologijos, viskas paprastėja, greitėja, bet kokybė yra išlaikoma žmonių.
Mėgstamus fotografus, aišku, seku ir instagrame. Su fotografais susirašinėjame, pakomentuojame vienas kito nuotraukas, stebime progresą.
Kokie tavo svajonių projektai?
Tokių tikslų neturiu išsikėlęs. Jiems neįvykus ateitų nusivylimai. Bet dalykai klostosi savaime. Eini, darai ir neplanuotai atsiduri ten, kur net nežinojai, kad norėtum.
Pavyzdžiui, su kolega gavome užsakymą iš „Lego“. Buvo netikėta, bet unikali patirtis. Prisiminiau vaikystę, kai „Lego“ be galo laukdavome, nes tai buvo didelis deficitas. O po daugelio metų štai fotografavau jų produktą, kuris dar net nebuvo išleistas į rinką, ir turėjome laikyti jo nuotraukas paslaptyje gal pusę metų. Tuomet suvoki, kiek į priekį planuojami tokie projektai. Bet ar tai kažkada buvo mano tikslas? Ne.
Aišku, norėčiau pafotografuoti ir garsiausius pasaulio šefus, pastebėti iš arti procesą: kaip jie dirba, kiek dėmesio skiria… Bet ir Lietuvoje dar yra šefų, su kuriais neteko dirbti. Ir čia dar yra ką veikti.

O ar esi turėjęs blogų patirčių? Juk esi aplankęs tiek daug Lietuvos restoranų, o mes visi žinome apie visokias hell’s kitchen... Ar buvo vietų, kurias pafotografavęs nenorėtum ten grįžti valgyti?
Buvo, bet į tokias patirtis koncentruotis nenoriu. Vis dėlto mes šią industriją vadiname svetingumo sektoriumi. Atėjęs į restoraną darbiniais ar nedarbiniais rekalais per kelias minutes galiu pasakyti, ar ten svetingumas yra vertybė, ar ne.
Ar gamini pats?
Taip, gaminu ne tik sau, žmonai, bet ir vaikams, kad ir jie suprastų skirtumus ir atrastų naujus skonius, suprastų, kas yra kokybė…
Tokių atradimų vis dar patiriu ir aš. Rašydamas knygą ir bandydamas receptus supratau mažus niuansus, kurie reiškia didelius skirtumus. Recepte rašoma: pipirai. Kokie pipirai? Žiupsnis druskos. Kokią druską naudojo šefas, o kokią tu? Ir panašiai.
Tas pats fotografijoje. Geriausi fotografai gali pasakyti tau tiksliai, kokią techniką naudojo, kokie nustatymai buvo, kaip susistatė apšvietimą. Bet tavo atveju tai neveiks: nebūsi identiškoje erdvėje, nepasidarysi identiškų atstumų… Dėl to svarbiausia valdyti situaciją ir suprasti, kas ir kodėl yra daroma, o ne bandyti aklai atkurti ar kopijuoti.
Savo kelionės pradžioje mokeisi iš fotografų, kurie perėjo iš analoginės į skaitmeninę fotografiją ar net iš nespalvotos į spalvotą. Šiandien matomas kitoks virsmas – iš fotografijos į vaizdo formatą, iš horizontalaus į vertikalų. Ar pastebi tai, ar keitiesi su rinka?
Kuo toliau, tuo daugiau ne tik fotografuoju, bet ir filmuoju, man tai patinka ir kelia naujų iššūkių. Nors priprasti prie vertikalaus formato dar sunku. Bet taip, visa rinka dabar nori daugiau ir daugiau vaizdo turinio.
Vis dėlto labai gerai matosi, kai daroma tik dėl to, nes taip reikia, bet nesimato koncepto, neaišku, kodėl restoranas filmuoja vienokius ar kitokius vaizdus, ką tuo nori pasakyti. Tai tiesiog prisideda prie bendro triukšmo ir taip apkrautoje internetinėje erdvėje ir nebūtinai kuria vertę.
Robertas Daskevičius prisipažino: fotografija jam patinka ir dėl to, kad atveria kelius ten, kur kitaip nebūtum atsidūręs. Pokalbio metu jis prisiminė vieną iš fotografijos meistrų – Joe McNally, jam, kaip fotografui, buvo suteikta galimybė užlipti į aukščiausio pasaulio pastato Burdž Chalifos (Dubajus, JAE) viršūnę kad nufotografuotų profesionalius laipiotojus, toje viršūnėje turėjusius pakeisti elektros lemputę. Ant šio pastato tėra buvę vienetai.
Pačiam Robertui yra tekę būti ant Katedros stogo, tuometinio „Kempinskio“ viešbučio stogo ir, žinoma, šimtų restoranų virtuvėse. Kiekviena tokia patirtis reiškia didelį pasitikėjimą ir atsakomybę.
Visiems esamiems ir būsimiems Lietuvos restoranų, kavinių, barų darbuotojams Robertas linki pasidžiaugti. Ne tik sustoti ir prisiminti savo pasiekimus, bet ir kolegų. Gavome Mišeliną? Pasidžiaukime, palaikykime vieni kitus. Pagalvokime, kaip galime KARTU pasiekti dar daugiau. To dar labai trūksta. Ir nebijokime klysti ar sustoti. Pabaigti vieną etapą ir pradėti kitą.
Lietuvos gastronomija keičiasi, teigiami pokyčiai vyksta kosminiu greičiu, ir visa tai įamžina Robertas Daskevičius. Ačiū už pokalbį.


Bordex vyno lentynos Nuo 43 Eur
Louis Roederer
Ledo kibirėliai
Nuo 99 Eur

Iš pirmo žvilgsnio vynas su kava visiškai nedraugauja, netgi priešingai – po kavos gerti vyną yra vyno žudymas. Tačiau visgi kava ir vynas, jeigu jie vartojami ne kartu, turi tam tikrų esminių sąsajų. Turbūt niekas geriau nepapasakos apie „rimtą“ kavą už Vytautą Kratulį, kuris savo kelionę kavos pasaulyje pradėjo maždaug tuo metu, kai kava iš plataus vartojimo prekių kategorijos pradėjo sukti ir į gurmė pasaulį. Susėdome su Vytu prie keturių skirtingos kavos puodukų.
Vytautą Kratulį kalbina Vaidotas Puklevičius
Manęs asmeniškai nereikia įtikinėti, kad kava yra ne mažiau subtilus ir vežantis reikalas negu vynas, bet tu, kaip žmogus, paniręs į kavą iki ausų, man pasakyk, kodėl apie kavą galima kalbėti vynui skirtame žurnale?
Aš manau, kad kava yra savotiškas dienos vynas, o „Vyno žurnalas“ skirtas tiems, kas domisi ne tik vynu, bet apskritai visais subtiliais dalykais, tarkim, produkto skonio kilme, ar nori suprasti priežastinį ryšį tarp žaliavos augimo vietos ir galutinio produkto skonio. Juk smalsūs žmonės nori praplėsti savo žinių ribas, suprasti daugiau negu eilinis plataus vartojimo produktų vartotojas. Be to, kava ir vynas turi labai daug bendra. Sutinku, kad po kavos vynas nelabai eina, bet tiek vynuogės, tiek kavauogės yra uogos, ne vaisiai, todėl abiem reikalinga fermentacija. Negana to, ir kavą, ir vyną veikia terroir, t. y. dirvožemis, klimatas, gamybos procesas, netgi demografija, tradicijos. Skiriasi tuo, kad vienas produktas yra alkoholinis, o kitas – nealkoholinis, vienas tave „užbūstina“, o kitas – atpalaiduoja. Dar, žinoma, skiriasi ir pati gamybos grandinė: vyno gamintojai dažniausiai (nors tikrai nebūtinai) ir augina vynuoges, o kavos augintojai galutinio produkto paprastai negamina. Kitas skirtumas – geras vynas kainuoja tikrai daug, o štai kava, kad ir labai gera, santykinai pigi. Bet tai ir suprantama, nes kava yra trumpo vartojimo produktas ir jos, deja, negali išlaikyti taip ilgai, kaip gero vyno.

Kai pradedame kavą lyginti su vynu, akivaizdu, kad kalbame ne apie visą kavos produkciją, bet apie specifinę kavą. Vyno rinkoje vartojame terminą fine wine, o kavos – specialty coffee. Kaip tu pats apibūdintum specialty kavą, kas tai – specialioji, rūšinė, gourmet, „elitinė“ kava?
Jeigu pamatytum ūkininkus, kurie augina kavą, apie elitiškumą mažiausiai pagalvotum. Specialty kavą augina visiškai paprasti vietiniai kaimiečiai, nepretenduojantys į jokį elitą. Aišku, yra nemažai tokių augintojų, kaip Pacai Salvadore, Rodriguezai Bolivijoje, kurie gali lygintis ir su žymiausiomis vyndarių elito šeimomis, tarkim, kokiais Antinoriais. Bet iš esmės žmonės, kurie augina kavą, yra labai arti žemės. Užtat jie turi tiek aistros, meilės žemei, tam darbui, kurį jie dirba, ir sugeba užauginti tokią puikią
žaliavą išskirtiniam produktui. Todėl sakyčiau, kad yra net keletas specialty kavos apibrėžimų. Pats paprasčiausias, kad tai yra ypatingas gamtos ir žmogaus kūrinys, užauginamas, apdorojamas tam tikroje apibrėžtoje teritorijoje, ūkelyje, kurį paskui su meile ir pagarba jau vartojimo vietoje kavos gėrėjams paruošia kavos skrudintojai. O kalbant mažiau poetiškai, specialty kava – tai tokia ne masinės produkcijos kava, būtinai arabika, su labai konkrečia informacija, kur ta kava užauginta, įvardinant konkretų ūkį, nurodant, kaip ji apdorota (plauta, džiovinta, anaerobinė), ir būtinai – skrudinimo datą. Dažnai būna nurodomas ir kavos augavietės aukštis. Kitaip tariant, specialty kava netiesiogiai jungia visą neatsiejamą grandinę tarp augintojo, žaliavos pirkėjo, skrudintojo, baristos ir vartotojo. Be to, kaip ir geras vynas, taip ir kava yra vertinama pagal specialią vertinimo sistemą. Kaip ir vyno pasaulyje, populiariausia kavos vertinimo sistema – šimtabalė. Tiksliai nežinau, bet manau, kad kažkada šita idėja buvo „pavogta“ iš Roberto Parkerio. Specialty kava bus įvertinta nuo 80 iki 100 balų, o viskas, kas vertinama iki 80 balų, bus masinis, arba comodity, produktas. Yra ir kitų vertinimo sistemų, bet, nepaisant to, keliabalė sistema būtų, jos tikslas – padėti vartotojams išsirinkti ypatingus produktus. Jau sakiau, kad specialty kava yra tik arabika. Robusta, kaip rūšis, neturi reikiamų savybių, kad būtų priskirta specialty kategorijos kavai. Yra manančių, kad ir iš robustos galima kai ką padaryti, bet aš įsitikinęs, kad šiandien reikia apsiriboti arabika, nes viskas, kas ne arabika, yra arba grynai masinė produkcija, arba labai keisti bandymai, kurie tik gali „subalamutinti“ vartotojus.
Gerai, kuriam laikui pamirštam robustą ir kalbam tik apie „normalią“ kavą. O kaip didėjantis specialty kavos poreikis atsiliepia kainoms?
Maždaug nuo 2010 metų visa masinės gamybos kava brangsta biržoje, o ką jau kalbėti apie specialty nišos kavą. Jos poreikis didėja aritmetine progresija, už ją kiekvienais metais sumokama žymiai brangiau. Praeitą dešimtmetį kainos kilo keletą kartų, o dabar jos kyla keliasdešimčia kartų, ir vartotojai pasiruošę mokėti. Šiandien už „Cup of Excellence“ aukciono kavą mokėti 100 USD/ kg yra visiška norma.


Skamba gana juokingai: už gero vyno butelį užsimerkus mokamas šimtas pinigų ir daugiau... Bet vyno kainas XXI amžiaus pirmojo dešimtmečio pabaigoje labai sukėlė kylanti Azijos ir, visų pirma, Kinijos rinka. Įsivaizduojame, kad Azija yra arbatos žemynas. Ar tai teisinga? Ar visgi Azija ir kavos rinkoje kelia tokią pat sumaištį, kaip ir vyno pasaulyje?
Ekonominiai dėsniai veikia ir Vakaruose, ir Azijoje, vartojimo mados – taip pat. Azijos vartotojai yra prekės ženklų medžiotojai, vakarietiško stiliaus pamėgdžiotojai. Žinoma, prie to labai prisideda ekonominė Azijos sėkmė. Be to, ne tik Kinija ekonomiškai kyla. O kadangi arbata nėra madinga Vakaruose, tai ir arbatos industrija Azijoje nėra tokia madinga kaip kavos, ji labai jau tradicinė, ne moderni. Kavos Azijoje geriama daugiau ir daugiau, o Japonijoje


kavos suvartojimas jau seniai aplenkęs arbatos. Manau, kad Korėjoje lygiai taip pat. Tai lemia šalies modernėjimas, vakarietiškas gyvenimo būdas. Pavyzdžiui, prestižiškiausio kavos konkurso „Cup of Excellence“ istorija prasidėjo nuo „ITC Gourmet Coffee Potential Project“ organizacijos, kurios vienas iš pagrindinių veikėjų buvo kultinė kavos pasaulio asmenybė – japonas Hidetaka Hayashi, o jis kava pradėjo prekiauti 1962 metais, kai apie specialty kavą dar niekas nekalbėjo.
Aš pats labai retai geriu Azijos kavą, nes man atrodo, kad gera kava asocijuojasi su Centrine, Pietų Amerika ir Afrika. O jei jau kalbame apie Aziją, tai iš karto iškyla arba vaikystės prisiminimai (indiška tirpi kava, traumos, patirtos Vietname geriant smalos skonio kavą), arba tokie turistų „monijimai“ kaip „šikučių“ arba luvakų kava. Kodėl rimti kavomanai dažnai pamiršta apie Aziją, kaip vietą, kur galima gauti geros kavos? Ir ar jos ten galima gauti?
Kopi Luvaką pažįsta labiau turistai negu kavomanai, ir tai tikrai turistų apgaulė. Indija daugiausia žiūri kiekybės, ne kokybės, bet ir ten po trupučiuką atsiranda gerų kavų, tik dar nedideliais kiekiais ir ji vargiai konkuruoja su kitų šalių kokybe. Vietnamas yra didžiausia pasaulio robustos šalis, nors sąlygas auginti arabiką turi, bet jos auginama dar labai labai mažai, nes geriau uždirbama iš kiekybės. Vietnamo robusta yra noriai perkama italų ir vokiečių
kavos gamintojų, kurie maišo ją į masinės kavos mišinius. Bet šiaip dabar visur atsiranda tendencija auginti itin kokybišką kavą, nes tai yra prestižas ir ūkiui, augintojui. O didieji kavos prekiniai ženklai jau į masinės produkcijos portfelius įtraukia ir specialty kategorijos kavos.
Gerai, apžvelkime Azijos kavos pasaulį. Nuo kurios šalies pradėsime?
Azijoje kavą augina Indonezija, Vietnamas, Papua Naujoji Gvinėja, Tailandas, Taivanas, Indija, Laosas, Kambodža, Kinija, Filipinai. Aš pats 2022-ais aplankiau Indoneziją, 2023-iais Tailandą, o šiais metais – Taivaną. Pastaruoju metu ieškau kavos iš Azijos. Ne visada esu patenkintas tuo, ką gaunu, bet noriu, nes matau potencialą. Visi trys aplankyti kavos regionai yra gana unikalūs savo terroir, kavamedžių veislėmis, apdorojimo technikomis, gebėjimais, galimybėmis, ir matau, kad jos dėl savo skirtingumo gali patikti labai skirtingų patirčių ir poreikių vartotojams. Pradėsiu nuo Tailando. Kavos čia užauginama mažai, ir dar pusė užauginamos kavos – robusta. Skonio diapazoną riboja aukštingumas, kavamedžių įvairovė, apdorojimo technikos. Lyginant su kitom šalim, Tailando kava greičiausiai niekada negalės pasiekti skonio gelmių, bet visgi tai gali būti puiki galimybė susipažinti su specialty kokybės kava apskritai ar su Azijos regiono kavomis. Tailande dominuoja ‘Catimor’ kavamedžių veislė, tiesa, man asmeniškai ji nelabai patinka. Tailando ūkininkai savo plantacijose užsisodinę daug prabangios ‘Geishos’ veislės kavamedžių, o tai jau pakelia lygį.
O koks yra geros Tailando kavos skonis?
Rudas cukrus, cinamonas, gvazdikėlis, pipiras, tropiniai skoniai, raudonas obuolys, rūgštis dažniausiai citrusinė. Ta citrusinė rūgštis – irgi yra tam tikras įvairovės trūkumas. Rūgščių juk yra įvairių, bet kiek aš degustavau, dominuoja citrusinė.
Na, o kaip Indonezija? Tai juk milžiniška šalis, daug salų, ten turbūt turėtų būti didelė įvairovė…
Didžiulė šalis. Nenormalaus dydžio. Makro ir mikroklimatų įvairovė. Pirmiausia – kas yra Indonezija? Java, Sumatra ar Papua? Klimatas labai įvairus, bet vienija ilgametis tradicinis Indonezijos ūkių naudojamas apdorojimo būdas, vadinamas šlapiuoju ( wet-hulled ), kai apdorojant kavauogę nuimamas ne tik minkštimas, bet iškart ir plonytė apsauginė plėvelė, o pupa paliekama „nuoga“ ir tada džiovinama. Šis metodas yra rizikingas, bet jeigu ūkininkas nesuklysta, kava įgauna samanų, grybų, humuso, tabako aromatų. Bet kartu šios kavos ir sultingos, ir vaisiškos. Dar vienas išskirtinis regiono požymis – tai savotiškas miltingumas, kai ragaujant veliasi liežuvis. Taigi, nors Indonezijoje auginama daug skirtingų kavamedžių veislių, tiek vietinių, tiek populiarių visame pasaulyje, kaip ‘Bourbon’, ‘Typica’, bet šiandien daugiausia dėmesio skiriama apdorojimui. Manau, kad tendencijos keisis, bus skirta daugiau dėmesio ir auginimui, veislių atrinkimui, o visa tai sudėjus bus išgauta daug tyresnė kava. Beje, pagal terroir Indonezijos Naujosios Gvinėjos salos dalis gali būti labai perspektyvi vieta kavos auginimui – geras aukštingumas, arti pusiaujo, puikus dirvožemis, žodžiu, viskas, ko reikia. Tik ten kol kas labai prasta infrastruktūra.
Gerai, ragausime Indoneziją. Bet tu šiais metais buvai Taivane ir, kaip suprantu, ne lustų pramonę plėsti į Lietuvą. Kuo ypatinga Taivano kava, jeigu tu jau ten nusibeldei? Kava Taivane vis dar yra tam tikra egzotika. Pagrindinė seniai atgabenta veislė, kurios auginama daugiausia, yra Kenijos ‘SL-34’. Bet jau yra ir daug ‘Geishos’ medelių. Kavos skonis? Kadangi daug ‘Geishos’, tai kai kurios labai išraiškingios. Turbūt vienas ryškiausių ir geidžiamiausių skonių – persikų, būdingas gerai „Geishai“. Apskritai, jeigu randi šio regiono kavos puodelyje persikus, gali būti tikras – tai „Geisha“. Ta senoji, geroji „Geisha“, iš Panamos... Taivano ūkininkai gerai pažįstami su Panama, visi pabuvoję, susipažinę, patyrinėję, parsigabenę sėklų. Smagu, jog Taivano „Geishos“ skonis autentiškas – sunkus persikas, tiršta ir kartu tyra kava. Kitokia yra kolumbietiška „Geisha“, joje gali justi gėliškumą, lengvutį jazminą. Bet, aišku, priklauso nuo ūkio, vietos. Taivano kavos turi daug kitų smagių aromatų ir skonių – aviečių, gvajavų, gali rasti ir riešutiškumo, šokoladiškumo, gėliškumo, ananasų, ličių.
Jau užsimaniau Taivano kavos. Kiek jos padaroma?
Taivano kavos yra labai mažai, o ūkininkai ypatingai maži. Mažai žemės ūkinei veiklai, viskas griežtai ribojama, ūkininkai kenčia nuo žemės drebėjimų ir taifūnų. Be to, darbo jėga brangi, todėl ūkininkai turi suktis patys, bet, skirtingai nuo kitų regionų, čia jie yra apsiginklavę technika, turi savo kilnojamas meteorologines stotis, tikrina dirvą, orą, kritulius. Taip pat turi ir automatines laistymo sistemas, dengtą šiltnamį džiovinimui – kitaip ir neišdžiovinsi tos kavos dėl permainingų oro sąlygų, kurios užklumpa staigiai, dėl taifūnų. Visa tai yra didžiuliai pinigai ir visiškai nesuvokiama kitose šalyse. Bet, aišku, todėl ta kava ir daug kainuoja. Taivano specifika, kad arbata ir kava čia sukasi kartu. Degustavau arbatą, labai puikią. Iš ūkininko, kuris yra ir arbatos, ir kavos augintojas. Sunkiausias mano klausimas jam buvo toks: kai tu visą dieną ragauji arbatą, kada laikas kavai? Supratau, kad jis labiau yra arbatininkas negu kavininkas, nes jis man labai gražiai atsakė: „Kava man padeda dirbti su arbata. Aš įvaldau žodyną, pradedu suprasti arbatą geriau dėl to, kad auginu kavą ir bendrauju su kavininkais, jie padeda plėsti akiratį.“ Užklausiau augintojo, kur jie deda likusią kavą, kurios nepateikė konkursui. Ją parduoda vietiniams skrudintojams arba prekiauja savo parduotuvėje. Ne kokioje internetinėje, o tu turi paskambinti ir turi atsitrenkti nusipirkti tos kavos. O vidutinės kokybės kavos kaina yra maždaug 100 USD už kilogramą. Ir tai vietoje. Galim įsivaizduoti, kokia bus konkurse – mažiausiai po 200 USD, o gal ir 300, ir 500 už kilogramą. Žodžiu, jeigu norėsite Taivano kavos, jau nupirkome jos aukcione.
Tai kada sulauksime tikrai geros Azijos kavos Lietuvoje?
Dar iki Kalėdų, gruodžio pirmą, antrą savaitgalį pakviesime ragauti, pristatysime Taivano ir Indonezijos prabangių kavų, kurias įsigijome „Cup of Excellence“ kavos aukcione.
O kol galėsime kasdien rinktis šių regionų kavą iš specialty kavos skrudintojų lentynų, reikės palaukti. Tiek Kinija, tiek Indonezija, Tailandas, Taivanas nėra dideli arabikos augintojai. Procesas užtruks, ir itin geros arabikos greitai nebus. Šiandien šių kraštų specialty kavos yra retas paukštis, itin reta galimybė jos atsigerti. Todėl kai jau bus lentynose – griebkit.

Kiekvieno vyno skonį formuoja skirtingi veiksniai. Gebėti paaiškinti aromatų ir pojūčių burnoje priežastis – daugelio vyno profesionalų ir pažengusių mėgėjų, siekiančių suprasti vyną, svajonė. Deja, net ir patys vyndariai ne visada sugeba tai padaryti. Ko nepasakysi apie Antoine Vincent ir Bénédicte Vincent bei Philipą Tuinderį – „Chateau Fuisse“ bendrasavininkisu Burgundijos pietuose esančiame Puji Fiuisė ( Pouilly-Fuissé AOP ). Jie puikiai išnarsto svarbiausią ūkio vyną „Tête de Cuvée“, padėdamas suprasti ir visus kitus ne tik jų šeimos gaminamus apeliacijos „Chardonnay“.
Puji Fiuisė vynuogynuose vyrauja keturi dirvožemio tipai:
• skalūnas. Kai ‘Chardonnay’ auga ant skalūno, vyne formuojasi lengvi gėliški aromatai. Tokio dirvožemio vynui kiek trūksta intensyvumo, todėl galutiniam vynui jis suteikia lengvumo;
• kalkakmenis Burgundijos pietuose yra iš Juros periodo, taigi sudarytas iš amonitų – spiralės formos jūros gyvūnų liekanų. Jie vynui suteikia medaus, žemės riešutų skonio ir minkštumo pojūčio burnoje;
• mergelis – kalkakmenio ir molio mišinys. Ant tokio dirvožemio augančios ‘Chardonnay’ turi citrusinių aromatų – mandarinų, apelsinų žievelių;
• molis. Kaip molis vynuogyne limpa prie batų, taip ir vynas iš tokio dirvožemio uogų limpa prie gomurio – tekstūriškas, sviestiškas.
Kiekvieno dirvožemio vyną jie fermentuoja skirtingai:
• skalūninį – nerūdijančio plieno talpose, siekdami išlaikyti lengvumą, gėliškumą;
• kalkakmenio vynuogės keliauja į senas statines – ąžuolas neturi užgožti vyno minerališkumo;
• molingo dirvožemio vynuogės keliauja į naujas ąžuolo statinės, nes vynui reikia deguonies, kuris nugludins, sušvelnins vyno „kampus“ ir suteiks vanilės, cinamono, gvazdikėlių aromatų.
„Chateau Fuisse Tête de Cuvée Pouilly-Fuissé AOP“ gimsta sumaišant visų keturių dirvožemio tipų vyną, taigi jame atsispindi visa apeliacijos skonių ir stilių įvairovė.




Vyno ir desertų derinių čempionato rezultatai

DERINIO
VYNO BARAS „SOMM“ (VILNIUS): Algimantas Kviklys, Ingrida Komisarovaitė, Ignatij Semionov.
Šaltalankių ir svarainių ledai su karamelizuoto baltojo šokolado kremu ir „Weingut Knipser Petit Doux 2023“.



RESTORANAS „ARRIVÉE“ (KAUNAS): Evaldas Juška, Edgaras Kazokaitis, Eglė Purvaneckaitė.
„Desertinė kelionė su Mažuoju princu“ (Rožė, Planeta, Skrybėlė) ir „W&J Graham’s Six Grapes Reserve Ruby“ portas.
II vietos prizą – „Duval-Leroy“ šampa-no kardą įsteigė „Vyno klubas“.
I vietos prizą – penkias dėžes (per 30 kilogramų) „Dvaro“ sviesto būsimiems desertams ir kūrybai įsteigė AB „Pieno žvaigždės“. Šis sviestas gaminamas pagal unikalią technologiją ir tik iš šviežios saldžios grietinėlės, todėl išsiskiria sodriu skoniu ir yra lengvai tepamas.
Lengviausią čempionato derinį apdovanojo vanduo „Akvilė“. Komandai atiteko poilsis „Vytauto SPA“ ir vandens prenumerata.

RESTORANAS „RED BRICK“ (UKMERGĖS RAJ.): Arnor Ingi Bjarkason, Odysseas Stavros, Oliver Stavros, Ilona Petrošiūtė, Lina Marija Balčiūnaitė.
Kavos ir grybų karamelinis kremas su karamelizuotais burokėliais, morkomis ir citrinos, verbenos ažūru ir austriškas „Weingut Sattlerhof Sauvignon Blanc TBA 2017“.
III vietos prizą – itin aukštos kokybės kepimo formas visai restorano komandai įsteigė buitinės technikos gamintojas „Neff“. Geriausio čempionato vyno prizą – vyno pilstymo sistemą „Coravin“ įsteigė „Vyno klubas“.


RESTORANAS „DINE“ (VILNIUS): Barbora Čepulionienė, Arminas Darasevičius, Justina Borkovskaja, Donatas Šatkauskas, Pavelas Čepulionis.
Deginto baklažano ir rudojo sviesto ledai su chalvos natomis (deginto baklažano ir rudojo sviesto ledų desertas su chalva, rūkytos paprikos tuile , žagrenio ir saldymedžio pudra) ir prancūziškas „Château Nairac Barsac 2003“.
Publikos simpatijos prizą – knygų apie gėrimus rinkinį įsteigė Lietuvos someljė mokykla.




RESTORANAS „AMANDUS“ (VILNIUS): Rita Ramanauskaitė, Lukas Stasytis, Ernestas Žitkauskas, Deimantė Kleinauskaitė.
Desertas „Dūzgės“ (medaus biskvitas, grietinės kremas, moliūgai, svarainiai, moliūgų sėklos, lazdynų riešutai, šermukšniai) ir itališkas „Donnafugata Ben Rye Passito di Panteleria 2021“.
RESTORANO „PACAI“ KOMANDA „MIELOS MIELĖS“ (VILNIUS): Goda Juknaitė ir Kamilė Bartusevičiūtė.
Šimtalapio interpretacija (dekonstruotas šimtalapis: aguonos, sviestas, pienas, grietinėlė, tešla, mielės) ir PAR vynas „Vin de Constance 2019”.
Lietuviškiausio deserto prizą įsteigė lietuviškumo tradicijas puoselėjantis „Dvaro“ prekinis ženklas.




RESTORANAS „DEMO“ (VILNIUS): Tadas Eidukevičius, Kasparas Alkevičius, Gytis Pečiulis, Rokas Pocius.
Desertas „Antra gyvybė“ (juodintas pienas, ryžiai, ikrai, vyšnios, svarainiai) su prancūzišku „Chateau Beaulon Pineau des Charentes 1985“.
Geriausio deserto prie kavos prizą – profesionalius mokymus apie kavą surengs „Rocket Bean“.
RESTORANAS „NINETEEN18“: Asta Oleškevičiūtė, Andžej Traskovskij, Simonas Laukaitis.
Desertas „Šiaurės įkvėptas“ (deginto sviesto sausainis, kepti obuoliai, kalvadosas, obuolių sultyse ir acte marinuotos mėlynės, angliškas kremas su sūriu morengu, tongapupė, cinamonas, gvazdikėliai, imbierai, anyžiai) ir itališkas „La Spinetta Passito Oro 2015“.
Stilingiausio deserto prizą – aukso spalvos „L‘Atelier du Vin“ vyno dekanterį komandai įteikė „Vyno klubas“.





Geriausio deserto prie kavos prizą gauti pretendavo (trumpajame sąraše)
RESTORANAS „JUSTA PASTA“: Anna Levkovich, Aleksandra Gusakovskaja, Kseniya Harabyova, Dzmitryi Prokharau.
Desertas „Justa Perfetto“ (tamsus šokoladas, kakavos milteliai, gorgoncola, džiovintos slyvos, kakavos pupelės, vermutas, manų kruopos, jaučio kraujas, baltasis šokoladas, pistacijos) ir itališkas „Montefalco Sangrantino Passito“.
Lietuviškiausio deserto prizą gauti pretendavo (trumpajame sąraše)
RESTORANAS „ELVEN“ (VILNIUS): Adomas Jegnoras, Arūnas Stramkauskas.
„Elven“ sūrio pyragas (varškė, pasukos, medus, žiedadulkės, bičių duona) ir Gintaro Sino „Apple Icewine“.


Lengviausio derinio prizą gauti pretendavo (trumpajame sąraše)
„CLOUD KITCHEN“ IR ILZENBERGO DVARO KO -
MANDA: Jaroslavas Masliukas ir Tadas Paplauskas.
Desertas „Saldus svarainis“ (putėsiai, grietinėlė, baltasis šokoladas, migdolų miltai, mangai, liofilizuoti svarainiai) ir Ilzenbergo pusiau saldus svarainių vynas.



Jaunųjų šefų prizas
KAUNO KOLEGIJA IR „ŠUŠVĖS“ MIDUS: Sigita Malinauskienė, Ignas Augustinavičius ir Aida, Sandra, Ernestas, Deimantė.
Desertas „Jogailos sapnas“ (rekonstruotas „Medutis“, sūrio ir grietinėlės putėsiai, agurkų ikriukai bei liofilizuoti agurkai) ir „Šušvės Agurkinis 2022 m.“ midus.
Prizas – Rasos Starkus įsteigtas „Cluizel“ šokolado rinkinys.



Jaunųjų šefų prizas
KAUNO TECHNOLOGIJŲ MOKYMO CENTRO
KOMANDA „AŠ TOKS, KAIP IR TU“: Vytautas Laibinis, Evelina Kraujelytė, Grytė Bezarienė, Giedra Sadauskienė.
Desertas „Įtrauktis“ (mačos arbatos milteliai, sviestas, grietinėlė, prieskoniai, avietės, uogos, aitriosios paprikos, šokoladas, kakava, kiaušiniai, pagardai, kreminis sūris) ir nealkoholinis putojantis vynas „Lyre‘s Classico“.
Prizas – Rasos Starkus įsteigtas „Cluizel“ šokolado rinkinys.


KOMANDA „VMS“ (BIRŠTONAS): Andrius Lekavičius, Julita Liutikaitė, Žilvinas Šapranauskas, Darius Dabrovolskas, Žilvinas Byčius.
Desertas „Rudens derlius“ (putėsių pyragaitis: svarainiai, vaisiai, medus, grietinėlė) ir austriškas „Weingut Sattlerhof Sauvignon Blanc Beerenauslese“.
Vyno ir desertų derinių čempionatas organizuojamas nuo 2010 m. siekiant kartą per metus Lietuvos virtuvės šefų, konditerių, someljė, vyno, midaus gamintojų, prekiautojų dėmesį sutelkti į desertą ir (saldų) vyną. Nuo varžybų pradžios daugelis geriausių Lietuvos profesionalų ne kartą jose dalyvavo, audrino savo fantaziją ir dalijosi idėjomis su kitais. Lietuviškiausio deserto, lengviausio derinio, deserto prie kavos kiti specialūs prizai ir įtempta kova dėl pagrindinio prizo – „Auksinės šakutės“ skatina restoranų kūrybingumą desertų srityje ir didina saldaus vyno pasiūlą, todėl Lietuvos restoranų lankytojai gali mėgautis bene įdomiausiais desertais Baltijos šalyse. Saldumynų mėgėjams reikia dairytis ne tik į varžybų nugalėtojus. Bendras lygis yra toks aukštas, kad neretai dešimtos vietos derinys yra labai puikus ir vien dėl jo verta užsukti į restoraną. Tuo labiau kad dauguma komandų žada varžyboms sukurtus derinius įtraukti į nuolatinį meniu. Atkreipkite dėmesį, kad varžybose dalyvauja restoranai iš visos Lietuvos. Čempionato svetainė – www.vynasirdesertai.lt. Čempionate vyno ir desertų derinius vertino: „Verslo žinių“ „Laisvalaikio“ rubrikos redaktorė Beatričė Laurinavičienė; leidinio „Falstaff“ Šiaurės Europos šalių redaktorius iš Estijos Aivaras Hansonas; gastronomijos publicistas, knygų autorius, Italijos „Associated Foreign Press“ narys Paulius Jurkevičius; tinklaraščio „Sezoninė virtuvė“ kūrėja ir knygų autorė Renata Ničajienė; „Vyno žurnalo“ autorius Linas Vaitulevičius; gastronomas ir keliautojas Vytaras Radzevičius; restoranų konsultantė ir vyno bei vandens someljė Urtė Mikelevičiūtė-Dervynas, „Lapės vestuvių“ įkūrėja Laura Vagonė; „Another Bite“ įkūrėja Eglė Tranaitė-Mascarenhas. Vertinimo komisijos darbą koordinavo čempionato sumanytojas, Lietuvos someljė mokyklos bei „Vyno klubo“ įkūrėjas, „Vyno žurnalo“ vyr. redaktorius Arūnas Starkus. Renginį vedė kulinarinių knygų autorė, televizijos laidų vedėja Beata Nicholson.


Desertas „Tartelette de menagerie“ (obuoliai, šeivamedžių uogos, svarainiai) ir prancūziškas „Drouet Maxence Extra Vieux Pineau des Charentes 1989“

„TAURAKALNIS“ IR „VYNO KLUBAS“: Kristina Eremeeva, Petras Jarašūnas.
Desertas „Gustus populi“ (obuoliai, šermukšniai, verbenos) ir itališkas „Planeta Passito di Noto 2022“.


Desertas „Bičiuliai“ („Medutis“, įkvėptas rudens: krosnyje ilgai keptų moliūgų kremas su grietine, moliūgų sėklų pralinė, naminio medaus ir lazdynų riešutų biskvitas, ‘Mirabelle’ slyvų ir japoninių greipfrutų padažas, šalavijų lapai) ir prancūziškas sidras „Dupont Givre Cider de Glace 2022“.

PAGRINDINIS RĖMĖJAS

PARTNERIAI
GASTROBARAS „ESSE“ (BIRŠTONAS): Salvijus Gudžinskas, Justinas Stonkus.

„HARMONY PARK“ (PRIENŲ RAJ.): Povilas Mažrimas, Brigita Kubelskienė.

Trumų ir šampano harmonija (baltojo šokolado ganašas su trumais, lazdynų riešutų traškutis, trumų perlai, gervuogių pudra) ir prancūziškas „Taitinger Champagne Les Folles de la Marguetterie Brut“.
RĖMĖJAI, ORGANIZATORIAI






Linas Vaitulevičius

„Ir kas jau ten tokio sudėtingo – priderinti vyną prie deserto… Paprasčiausia chemija: rūgšties, alkoholio ir cukraus balansas, nutaikytas taninų kartumas ir tekstūra, desertą papildantys arba maloniai kontrastuojantys vyno aromatiniai terpenai, įvairūs esteriai...“ Maždaug toks galėtų būti apsišvietusio skeptiko komentaras išgirdus kvietimą apsilankyti 14-ame Lietuvos vyno ir desertų derinių čempionate ir patirti atradimo džiaugsmą. Ir skeptikas iš dalies yra teisus: derinant desertą ir vyną, techninės žinios praverčia ne mažiau nei techninė akcijų analizė biržos makleriui.
Vis dėlto tobulo derinio sukūrimas labiau primena alchemikų pastangas paversti įprastas medžiagas – šviną, sierą, druską –tauriuoju auksu. Tačiau šiuolaikinio chemijos mokslo išjuokta bei nuvertinta regimoji alchemijos pusė – tik ledkalnio viršūnė, savotiška dūmų uždanga. Garsus šveicarų psichiatras ir psichoterapeutas C. G. Jungas atskleidė slaptą ir kur kas svarbesnę psichologinę alchemijos prasmę – kaip asmeninės transformacijos procesą, kelionę, kurioje keičiamasi siekiant tobulybės.
Tikroji alchemija yra menas paprastą, kasdienišką, net toksišką – kaip švinas ar alkoholis – materiją paversti kažkuo nepaprastu, amžinuoju „auksu“. Pavyzdžiui, seilę varvinančiu deserto ir vyno deriniu. Iki alcheminio virsmo veda klaidus ir vingiuotas tobulumo paieškų kelias. Susitapatindamas su tuo, kas vyksta kolboje (virtuvėje, vyno rūsyje), alchemikas pats keičiasi ir bręsta kaip kūrėjas, asmenybė. Alchemikų žodžiais tariant, transmutuo -
ja kartu su savo kūriniu. Kelionė į materijos gelmes yra ir kelionė į savo paties vidų – būtent apie tai rašė Paulas Coelhas romane „Alchemikas“. Ne veltui šią kelionę alchemikai vadino Didžiuoju darbu (lot. Opus Magnum ) ir skirstė į keturis etapus, į kuriuos galima suskirstyti bet kokį svarbų virsmą, taip pat ir kūrybines tobulo vyno ir deserto derinio paieškas. Štai tie etapai.
• Nigredo – kančių, abejonių, chaoso stadija, lydima melancholijos ar net depresijos (nežinojimas, nuo ko pradėti, „juoda naktis“).
• Albedo – sudedamųjų dalių atrinkimo, išplovimo, išvalymo stadija, kurios metu išgryninama idėja (alchemikų simboline kalba, „juodą naktį pirmąkart blausiai apšviečia mėnulis“, t. y. atsiranda teisingos krypties nuojauta).
• Citrinito – iš atrinktų ir išgrynintų sudedamųjų dalių surenkama nauja struktūra, ima ryškėti trokštamo rezultato kontūrai (alchemikai šią stadiją prilygina gelsvam „aušros“ sušvitimui, kai pačios saulės dar nematyti).
• Rubedo – darbo pabaiga, išgautas „auksas“, idėjos pavertimas kūnu (tobulu deriniu), lydimas pakilumo ir nušvitusios sąmonės (alchemikų simboline kalba, „saulės patekėjimas“).
Tikrasis alchemikų „auksas“ buvo prasmės ir nemirtingumo paieška. Nebūtinai tiesiogine fizine prasme – labiau savęs įprasminimo, svajonių išpildymo, profesinio pripažinimo, savirealizacijos. Vyno ir desertų derinių čempionate šį „auksą“







simbolizuoja pagrindinis prizas – auksinė (!) šakutė, lydimas euforijos ir nepakartojamo pergalės jausmo. Verta dalyvauti gyvame renginyje, kad tai patirtum savo kailiu.
Čempionato dalyviai – tarsi šiuolaikiniai alchemikai – pernaudojo ankstesnes patirtis, nuojautą, intuiciją ir mokslines, technines, medžiagines žinias kurdami subjektyviai tobulą vyno ir deserto derinį, įkūnijantį jų vertybes ir pasaulėžiūrą.
Kodėl alchemikai taip mėgsta naudoti simbolinę kalbą savo patirčiai išreikšti? Ogi todėl, kad simboliai leidžia peržengti skaldančios ir poliarizuojančios logikos ribas, mums įprastą dualumą: myliu–nekenčiu, gerai–blogai, balta–juoda, skanu–neskanu, rūgštu–saldu. Geriausias pavyzdys – saldi „Mažojo princo“ interpretacija, kurią „Arrivée“ komanda simboliškai perteikė keturių dalių deserto ir „Graham‘s“ porto deriniu (II vieta): stiklo gaubtu pridengta rožė buvo ne tik gėlė, bet ir estetizuotas transportavimo indas gaiviam uogų esencijos lašui iki lūpų atnešti. Jo paskirtis – nuplauti ankstesnius skonius ir paruošti gomurį desertui. Mažojo Princo planeta pasirodė esanti šokolado, gvazdikėlio ir cinamono musas, o šokolado ir skrudintų kavos pupelių skonio skrybėlė slėpė „lapę“, tiksliau, trapų lapės formos šokolado lakštelį. Žaidimas simboliais ir jų reikšmėmis priminė garsųjį siurrealisto René Magritte paveikslą su pavaizduota pypke ir prierašu: Ceci n’est pas une pipe ( pranc. „tai ne pypkė“ –suprask, tai tik grafinis pypkės simbolis). Gerai parinktas portas pastiprino ir sujungė deserto sudedamąsias dalis į vientisą patirtį. Lieka tik pacituoti patį „Mažojo Princo“ autorių Antoine’ą de Saint-Exupéry: „Tobulybė pasiekiama ne tada, kai nėra ko pridėti, o tada, kai nėra ko atimti.“
„Red Brick“ komanda desertą sukūrė iš nekilmingų (verbena), labai žemiškų (burokėliai, morkos, grybai), netgi nurašytų
(panaudota kava) sudedamųjų dalių, savotiškos alcheminės materia prima . Kruopštus darbas ir teisingai parinktos proporcijos davė įspūdingą rezultatą, kurį savo užrašuose pasižymėjau labai lakoniškai: „Wow, menas!” Buvo netikėta, kvapnu, neįprasta, labai skanu. Skoniai pamažu lydėsi ir mainėsi burnoje. „Weingut Sattlerhof Sauvignon Blanc TBA 2017“ vynas iš pietinės Štyrijos žemių vertas atskiro komentaro! Papildęs derinį džiovintais ir egzotiniais vaisiais, burnoje vynas buvo gaiviai minerališkas ir organiškai susiliejo su žemiškom deserto natom. Deserto estetika taip pat pagirtina. Subjektyviai laikau šį derinį lygiaverčiu nugalėtojui.
Kalbant apie nugalėtojus, „Somm“ restorano komandos derinys (I vieta) dar kartą priminė, kad mažiau kartais gali būti daugiau. Šaltalankių ir svarainių ledai, karamelizuotas baltojo šokolado kremas – štai ir visos pagrindinės sudedamosios dalys. Tačiau deserto svarainiai – ne paprasti, o ypatingi: šefas Algimantas Kviklys panaudojo savo tėvo išvestą svarainių veislę „Darius“. Šio ypatingo ingrediento alcheminis atitikmuo būtų lapis philosophorum , arba paslaptingasis filosofinis akmuo, kurį įmaišius kolboje netaurūs metalai virsta auksu, o deserto ir vyno derinys – vertu „Auksinės šakutės“. Lengvas ir vaisiškas „Weingut Knipser Petit Doux 2023“ vynas taip pat turėjo svarainių natą, tačiau ir „nuo savęs“ pridėjo puokštę egzotinių vaisių (mangai, pasifloros), suteikdamas kompleksiškumo, bet nė trupučio nesusilpnindamas bendro lengvumo pojūčio. Vizualiai neperkrautas derinys savo lengvumą išlaikė ir burnoje, todėl pelnytai gavo dar ir prizą už lengviausią derinį.
Alcheminio proceso metu senoji forma, kaitinama kolboje, dažnai subyra į ją sudarančius elementus ir iš šių elementų ima formuotis kažkas visiškai nauja. Šiuo keliu pasuko „Pacų“
komanda (lietuviškiausio deserto nominacija), dekonstravusi mums visiems nuo vaikystės šeimos švenčių pažįstamą šimtalapį. Tradicinės sudėtinės dalys (aguonos, sviestas, tešla, pienas, mielės) buvo išardytos ir vėl sujungtos į naują formą, išgaunant naujovišką estetiką ir norimus tekstūrinius potyrius, kuriuos sustiprino degintų mielių ledai bei garsusis Pietų Afrikos „Klein Constantia Vin de Constance“ 2019 metų derliaus desertinis vynas, papildęs derinį persikų ir apelsinų žievelių aromatu su muskatų riešutų nata. Apie praktinius dalykus – tobulą porcijos dydį ir valgymo patogumą, akivaizdu, taip pat buvo pagalvota. Čia ir vėl suveikė principas „nauja – tai gerai užmiršta sena“, o vis dar gyvi sentimentai tradiciniam šimtalapiui turėtų šiam desertui garantuoti ir komercinę sėkmę.
Gilų įspūdį paliko „Demo“ restorano komandos derinys „Antra gyvybė“, čempionate kiek netikėtai įvertintas kaip geriausiai tinkantis prie kavos. Desertui panaudotas juodinto pieno ryžių pudingas, išgautas ilgai kaitinant slėginiame inde, primena alchemijai be galo svarbaus filosofinio akmens sintezę. Pastarajam skirtos medžiagos taip pat dedamos į uždarą indą ir labai ilgai kaitinamos, palaikant pastovią temperatūrą, slėgį. Deserte drąsiai ir kūrybiškai dera iš pirmo žvilgsnio nelabai tarpusavyje suderinami elementai: osetros eršketo ikrai, kompotinės vyšnios, ryžių traškučiai, lazdyno riešutų pralinė, baltasis pelėsis, juodinta svarainių melasa. Ar iš aprašymo pavyko įsivaizduoti skonį? Labai abejoju... Neužtenka išgirsti pasakojimą apie vaivorykštę, būtina pačiam pamatyti. Lygiai kaip ir šį desertą būtina ragauti norint pajusti jo skonį. Kūrybiškumas ir sąmoningas kanono laužymas (tiek turinio, tiek formos) įrodo, kad „Michelin“ vertintojai nesuklydo, skyrę restoranui pirmąją žvaigždę. Prie deserto buvo patiektas brandus ir sodrus „Chateau Beaulon Pineau des Charentes 1985“ vynas, kurio saldi aromatų puokštė (gvazdikėliai, cinamonas, imbieras, prieskoniai) ir ilgai išliekantis
sušildantis skonis (troškinti vaisiai, abrikosai, medus) pakylėjo ir taip labai gerą desertą iki tobulo. Mano akimis, šis derinys prilygo čempionato nugalėtojui, nors yra labai skirtingas, neturintis nieko bendra su lengvumu. Tiesa, turėčiau prisipažinti visada buvęs sodresnių ir „nuodėmingesnių“ desertų mėgėjas – lengvi ir gaivūs desertai man tarsi dar vienas žingsnis nealkoholinio vyno link...
Norėčiau paminėti ir čempionato veteranus – „Dine“ komandą. Jau ne pirmi metai žaviuosi neišsenkančia konditerės Barboros Čepulionienės fantazija ir drąsa žaisti maistu, kurti džiaugsmą. Šiemet vizualiai nuostabaus grožio ir simetrijos desertas priminė alchemikų tėvo Hermio Trismegisto frazę „kaip viršuje, taip ir apačioje“: simetriškas viršutinę ir apatinę deserto dalis skyrė kiauraraštis tuile – rūkytos paprikos vaflio ažūras. Pats desertas – deginto baklažano ir rudojo sviesto ledai su chalva, žagrenio ir saldymedžio pudra. Artimųjų Rytų skonis buvo maloni alternatyva visiems tiems obuoliams, svarainiams ir medui, kurių buvome spėję lig soties prisiragauti ankstesniuose deriniuose. Dvidešimties metų brandumo koncentruotas gintarinis Bordo vynas iš Soterno „Chateau Nairac Barsac 2003“ derinį papildė persikų, abrikosų, medaus natomis ir dar kartą įrodė, koks vis dėlto universalus ir prie įvairaus skonio ir stiliaus maisto tinkantis yra Soterno vynas – tikrai vertas rinktis!
Paminėjau man labiausiai įstrigusius DERINIUS. Be jų, dar buvo keletas perspektyvių desertų, kurie, mano nuomone, nukentėjo dėl netinkamai parinkto vyno. Pasitaikydavo ir priešingai: nelabai ryškų, kiek monotonišką ar kontroversiško skonio desertą aukštyn tempdavo (bet, deja, ir užgoždavo) puikus vynas. Dalyvių tai niekaip neturėtų atgrasyti nuo kūrybos, apie kurią Antoine’as de Saint-Exupéry yra taikliai pasakęs: „Kurti – tai nukelti kitą ten, iš kur jis matytų pasaulį tokį, kokį nori matyti, o ne siūlyti jam naują pasaulį.“

Lietuvos someljė asociacija
Lietuvos someljė asociacija
Geriausias vintažinis šampanas
PERTOIS MORISET LE SPECIAL CLUB
GRAND CRU LE MESNIL-SUR-OGER 2016
Gaivūs žalių obuolių, baltų gėlių aromatai. Itin kremiškas putojimas, gaivi, energinga rūgštis. Ilgai išliekantis poskonis, kuriame dominuoja žaliųjų citrinų tonai su stipriu minerališkumo pojūčiu. (LK)
HEDONIST

Geriausias nevintažinis / multivintažinis šampanas
CHARLES-HEIDSIECK BRUT RESERVE
Kvepia nokių citrinų žievelėmis, raudonais obuoliais, subtiliais kepiniais, skrebučiu, džiovintais vaisiais ir kedrų riešutais. Juntama subtili rūgštis, skonis minerališkas ir ryškus. Ilgai išliekantis poskonis. (IS ir LK) MV GROUP DISTRIBUTION LT

Geriausias tradiciniu būdu pagamintas putojantis
VERTICE GOUVEIO DOURO 2015, PORTUGALIJA
Citrinų, greipfrutų aromatą papildo nokių persikų, švelnus prieskonių, vanilės, skrebučio aromatas. Burnoje juntama gaivi rūgštis. (IS) MV GROUP DISTRIBUTION LT

Geriausias Charmat būdu pagamintas putojantis
PROVERBIO PROSECCO, ITALIJA
Vaisiškas, sultingas, kvepiantis kriaušėmis, sunokusiomis citrinomis, obuoliais. Burnoje juntama puiki dermė. Ilgai išliekantis poskonis. (MP)
KALNAPILIS

Geriausias Charmat būdu pagamintas putojantis
SENSI PROSECCO COLLEZIONE EXTRA DRY NV, ITALIJA
Intensyvus prinokusių geltonų slyvučių, kriaušių, gėlių aromatas. Burnoje lengvas, minkštų burbuliukų, elegantiškas, prinokusių kriaušių poskonio vynas. (AD)
RIMI

Geriausias Charmat būdu pagamintas putojantis
BOTTEGA GOLD BRUT PROSECCO DOC, ITALIJA
Antaninių obuolių, šviežių kriaušių, grietinėlės bei obelų žiedų aromato vynas. Burnoje sausas, minkštos putos, geros dermės ir ilgai išliekančio minerališko poskonio. (MP)
TRIDENS

Geriausias Pet Nat
LA GRANGE TIPHAINE ROSÉ ROSA ROSAM 2023, PRANCŪZIJA
Vyšnių spalvos ir intensyvaus braškių, trešnių ir prieskoninių žolelių aromato vynas. Svarus, intensyvus vyšnių skonis. Sodrus, pilno kūno, uogų poskonis. (NM)
SOMMELIER PARTNERS

Geriausias „Chardonnay”
WEINGUT KNIPSER CHARDONNAY RÉSERVE 2020, VOKIETIJA
Intensyvus, išraiškingas vaisių ir gėlių aromatas. Burnoje pilnas, kompleksiškas, sviestiškas. Puikus švelnumo ir jėgos balansas. Itin sodrus ir nugludintas, intensyvus poskonis. (NM) SOMM

Geriausias „Sauvignon Blanc“
GREYWACKE SAUVIGNON BLANC 2023, NAUJOJI ZELANDIJA
Šeivamedžių, jūros, baltų kaulavaisių, serbentų aromatas. Burnoje gan koncentruotas, nokus, lengvai salstelintis, su minerališkomis natomis pabaigoje. Gan ilgai išliekantis poskonis. Kremiška, noki rūgštis. (IB) TERUA

„Riesling“
WEINGUT HIRSCH ZOBINGER
GAISBERG RIESLING 2015
Cirtusų, gėlių aromatas. Burnoje juntamos medaus, prieskoninių žolelių natos. Gaivaus, minerališko stiliaus. Ilgai išliekančio, gerai subalansuoto skonio. Sukuria tvirto, bet jaunatviško vyno įspūdį. (NM) SOMM

Geriausias kitų veislių baltasis
MOUNT RILEY MARLBOROUGH
PINOT GRIS 2023
Vidutinio intensyvumo gelsvos spalvos vynas kvepia geltonais obuoliais, persikais, greipfrutais, agrastais, baltaisiais serbentais su subtilia žoliška nata. Burnoje koncentruotas, galingas, ilgai išliekančio prieskoniško poskonio. (MP)
IKI

Geriausias natūralusis baltasis
DAKISHVILI FAMILY SELECTION
RKATSITELI AMBER DRY 2020, SAKARTVELAS
Cukruotų imbierų, razinų, keptų slyvų aromatas. Galingi nokūs taninai, jaučiamas reikalingas kartumas. (SL)
DAKTARO VYNAS

Geriausias rožinis
LEONE DE CASTRIS FIVE ROSES
SALENTO IGT 2023, ITALIJA
Ryški rožinė spalva. Aviečių, braškių, prinokusių persikų, rožių žiedlapių aromatas. Gaivus, vaisiškas, intensyvus vynas. (IS)
VYNO KLUBAS

Geriausias natūralusis raudonasis
SAN DONATINO CHIANTI CLASSICO RISERVA 2016
Vidutinio intensyvumo spalva su granito atspalviu. Raudonų aviečių, prieskonių ir švelnus džiovintų spanguolių aromatas. Taniniškas vynas.
SOMMELIER PARTNERS

Geriausias Prancūzijos raudonasis
CHÂTEAU FAIZEAU SELECTION
VIEILLES VIGNES MONTAGNE-SAINTÉMILION AOP 2020
Instensyvi rubino spalva. Kompleksiškas aromatas: nokių trešnių, vanilės, kardamono, skrebučio. Burnoje nokus, sausas, su gausiais taninais, šildantis, bet subalansuotas. Ilgai išliekančio poskonio. (IS)
MV GROUP DISTRIBUTION LT

Geriausias Prancūzijos raudonasis
CHÂTEAU LAROQUE ST. EMILION GRAND CRU 2014
Didelė raudonų ir juodų uogų, prieskonių aromato puokštė. Burnoje gaivus, pilnas sunokusių taninų. Sodrus prieskonių, raudonų uogų poskonis. (NM)
IKI

Geriausias Prancūzijos raudonasis
DELAS CHANTE PERDRIX CORNAS AOC 2019
Melsva rubino spalva. Mėlynių, gervuogių, figų aromatas. Burnoje justi sodrus, nokus skonis, pilnas tamsių uogų. Gausus švelnių taninų. Intensyvus, sodrus vynas. (NM)
LIVIKO

Ispanijos raudonasis
ALEJANDRO FERNÁNDEZ TINTO PESQUERA RESERVA RIBERA DEL DUERO DOP 2018
Skrudinimo, prieskonių, šokolado, tabako, slyvų, gervuogių, juodųjų serbentų aromatas. Išraiškingas, elegantiškas, labai ilgai išliekantis prieskonių, šokolado, gervuogių poskonis. Puikaus balanso, gaivios rūgšties, švelnių taninų vynas. (AD)
LIVIKO
Geriausias Italijos raudonasis
IL VALENTIANO BRUNELLO
DI MONTALCINO DOCG 2018 Švarus, sultingas, puikios koncentracijos vynas kvepia juodomis vyšniomis, slyvomis, gvazdikėliais, rozmarinu, tabaku bei nauja oda. Ilgai išliekančio, elegantiško poskonio vynas. (MP)
HEDONIST

Geriausias Portugalijos raudonasis
SECRET SPOT DOURO TINTO DOC 2019
Sodri tamsiai raudona spalva. Kompleksiškas, intensyvus prieskonių, vanilės, slyvų šokolado, juodųjų serbentų aromatas. Gausūs, tvirti taninai, galinga, gaivi rūgštis. Ilgas prieskonių, vanilės, juodų uogų poskonis. (AD)
HEDONIST


Geriausias Naujojo Pasaulio raudonasis
ERRAZURIZ DON MAXIMIANO 2017
Sodrios spalvos vynas kvepia kakava, kava, vanile, juodomis vyšniomis bei slyvomis, išnyra gaivios kedro, mėtų užuominos. Burnoje vynas veržlus, sultingas, puikios struktūros. (MP)
PRIKĖ LIETUVA

Geriausias kitų kraštų raudonasis
MARKOWITSCH RIED ROSENBERG 1QTW 2021, AUSTRIJA
Veržlus, taniniškas, kiek laukinis vynas kvepia raudonomis uogomis, žolelėmis, prieskoniais. Puikios dermės, ilgai išliekančio poskonio. (MP)
VYNO KLUBAS

Geriausias „Pinot Noir“
KNIPSER SPATBURGUNDER
KIRSCHGARDEN 2019, VOKIETIJA
Rubino spalvos. Vidutinio intensyvumo elegantiškas vyšnių, raudonų serbentų, žolelių, prieskonių aromatas. Burnoje ilgai išliekantis gaivios, švelnios rūgšties, prieskonių ir raudonų uogų poskonis. (AD)
SOMM

Geriausias natūraliai saldus
ZANTHO BEERENAUSLESE
BURGENLAND 2020
Nuostabios dermės, koncentruoto aromato bei skonio saldusis vynas kvepia medumi, konservuotais persikais, ananasais bei citrinų žievelėmis. Ilgai išlieka elegantiškas poskonis. (MP)
RIMI

Geriausias portas
QUINTA DO CRASTO TAWNY 10 YO
Blyškios granatų spalvos vynas kvepia džiovintomis bruknėmis, apelsinų cukatais, oda, vanile, prieskoniais. Burnoje elegantiškas, puikiai subalansuotas bei puikiai integruoto alkoholio. (MP)
PRIKĖ LIETUVA

Geriausias pastiprintas
LUSTAU PEDRO XIMÉNEZ SAN EMILIO. GERIAUSIAS KATEGORIJOJE
Gintaro spalvos vynas kvepia figomis, džiovintomis slyvomis, apelsinų marmeladu, kavos bei kakavos milteliais. Burnoje tirštas, kremiškos tekstūros bei itin saldus. Visa tai subalansuoja sultinga rūgštis. (MP) MV GROUP DISTRIBUTION LT

ir redaktoriai:
Bartusevičiūtė

Barnaut Grand Cru Brut Millésimé 2012

Bruno Paillard Assemblage Millésimé 2012

Deutz Amour De Deutz Brut 2013









Blanc De Blancs Vintage Brut 2018
Lanson Noble Cuvée Brut 2004
Laurent Perrier Brut Millesime 2015
Legras & Haas Blanc de Blancs Millesime 2014
Pertois Moriset Le Special Club Grand Cru Le Mesnil-sur-Oger 2016. Geriausias kategorijoje
Nokių citrinų spalva. Citrinų ir auksinių obuolių aromatas, vėliau atsiranda kvapnios persikų uogienės, medaus ir brijošės aromatai. Burnoje juntama sultinga rūgštis. (IS)
Citrusų aromatas su žalių paprikų atokvapiu. Burnoje gaivus, ryškios rūgšties, primena žalius antaninius obuolius. Minerališkas. (IS) SOMM
Citrinų spalva. Juntamas linksmas citrinų, antaninių obuolių, skrebučio ir lydyto sviesto aromatų žaismas. Sultinga rūgštis ir jūros akmens minerališkumas. (IS)
Subtilūs baltų gėlių ir kriaušių aromatai. Itin malonūs, smulkūs burbuliukai. Puikiai integruota rūgštis. Ilgai išliekantis poskonis, kuriame dominuoja citrusai, alyviniai obuoliai. (LK)
Sviestiškas, grietinėliškas aromatas su nokių geltonų vaisių bei riešutų užuominomis. Burnoje tvirtas. Pasižymi labai šviežia, jaunatviška rūgštimi. (KB)
Juntami subtilūs brandos aromatai: skrudintų riešutų, svarainių džemo. Poskonis svarus, kompleksiškas su salsvomis džiovintų abrikosų ir obuolių natomis, tačiau rūgštis vis dar juntama. (LK)
Subtilus jazminų, alyvinių obuolių aromatas. Juntama itin elegantiška, švelni puta. Dominuoja minerališkas, ilgai išliekantis jaunatviškas poskonis, primenantis žaliąsias citrinas, geltonus greipfrutus. Puikus brandos potencialas. (LK)
Švelnūs kepinių, kvietinės duonos, citrusinių vaisių aromatai. Burnoje sirpus, puikios, gaivios rūgšties. Justi skrebučio, žalių obuolių, mielinių kepinių poskonio natos. (LK)
Gaivūs žalių obuolių, baltų gėlių aromatai. Itin kremiškas putojimas, gaivi, energinga rūgštis. Ilgai išliekantis poskonis, kuriame dominuoja žaliųjų citrinų tonai su stipriu minerališkumo pojūčiu. (LK)
Philipponnat Blanc de Noirs Vintage Extra-Brut 2018 Baltų persikų spalva. Sodo vaisių aromatas: juntami žali ir raudoni obuoliai, švelnus, mieliškas jogurto aromatas. Burnoje – sultinga rūgštis ir minkšta puta. (IS)
Aromatai ekspresyvūs, primena džiovintus vaisius, svarainių cukatus su lengva prieskoniškumo nata. Koncentruotas, ilgai išliekantis poskonis. Burnoje dominuoja geltoni persikai, abrikosai, šiek tiek juntamas raudonų uogų poskonis. (LK)
TRIDENS
Piper-Heidsieck Vintage 2018
Nokus, tvirtas šampanas. Kvepia keptais obuoliais, šviežiais ananasais, marcipanais, kepyklėle. Burnoje švelniai salsteli, puikaus balanso, gaivios rūgšties, kremiškos putos. Ilgai išliekančio kompleksiško poskonio. (KB)
LIVIKO
AMBER DISTRIBUTION LITHUANIA
VYNO KLUBAS
HEDONIST
MV GROUP DISTRIBUTION LT
VYNAS (A–>Z)

Brimoncourt Regence Brut Ay

Chassenay D’Arce

Charles-Heidsieck Brut Reserve. Geriausias kategorijoje


Paul Chambois 1er Cru, Brut Blanc

Pertois Moriset Les Quatre Terroirs Grand Cru NV

Philipponnat Royale Reserve Rose Brut
APRAŠYMAS
Citrinų spalva. Dominuoja citusinių vaisių aromatas: citrinų, greipfrutų, juntamos skrebučio ir baltos duonos natos. Burnoje – gaivi rūgštis ir sodo vaisiai. Ilgai išliekantis, elegantiškas poskonis. (IS)
Citrinų spalva. Citrusinių ir sodo vaisių aromatas. Grakščiai mieliškas: skrebutis, lydytas sviestas, kvietinė duona. Itin kremiškas burbuliukų pojūtis. (IS ir LK)
Kvepia nokių citrinų žievelėmis, raudonais obuoliais, subtiliais kepiniais, skrebučiu, džiovintais vaisiais ir kedrų riešutais. Juntama subtili rūgštis, skonis minerališkas ir ryškus. Ilgai išliekantis poskonis. (IS ir LK)
Sirpių geltonų egzotinių vaisių kvapai, burnoje puikaus balanso, nuosaikios rūgšties. Ilgai išliekantis poskonis su žaliųjų citrinų, greipfrutų natomis rodo brandinimo potencialą. (LK)
Geltonųjų ir žaliųjų citrinų aromatą keičia nokių kaulavaisių – abrikosų, persikų, baltos duonos skrebučių kvapai. Burnoje subtilus, minkštos putos, švelnios rūgšties, juntamas sodo vaisių skonis –raudonų obuolių, geltonų kriaušių. (IS) IKI
Nokių citrusinių vaisių, keptų obuolių, obuolio žievelių, svarainių, kepinių aromatas. Vaisišką aromatą papildo kreida. Burnoje nokus, puikiai subalansuotas, malonios rūgšties, švelnios, elegantiškos putos. Ilgai išliekančio poskonio. (KB)
Blyški lašišos spalva. Dominuoja aviečių, trešnių, baltų persikų aromatas. Burnoje vidutinio intensyvumo, maloniai gaivus, elegantiško raudonų sodo uogų poskonio. (LK)
HEDONIST
MV GROUP DISTRIBUTION LT
TRADICINIU BŪDU
PAGAMINTAS PUTOJANTIS. Aukso medalių laimėtojai



Didžioji Britanija Wiston Estate Brut NV Sussex
Ca’Del Bosco Cuvee Prestige
Edizione Franciacorta DOCG
Desom Brut Millésimé Crémant De Luxembourg 2020
Intensyvus skrebučio, šlapio akmens, jūros dumblių, lengvo dūmo aromatas. Lengvas, bet intensyvaus skonio, gausios rūgšties ir ilgo poskonio. (DM) HEDONIST
Vidutinio intensyvumo kreidos, citrinų, brijošės ir šviežios tešlos aromatai. Labai energingas, gaivus bet elegantiškas. Ilgai išliekančio citrinų, kepinių poskonio. (DM)
Labai intensyvus pasiflorų, morengų, citrinų šerbeto aromatas. Vidutinė svarumo ir skonio koncentracija, minkšta rūgštis, smulkūs burbuliukai ir kremiška tekstūra. (DM)
ŠALIS (A–>Z) PAVADINIMAS

Portugalija

Prancūzija

Prancūzija
Vertice Gouveio Douro 2015. Geriausias kategorijoje
Domaine Verret Crémant de Bourgogne Pinot Noir Brut
Veuve Ambal Grande Cuvee
Brut Cremant de Bourgogne AOC
APRAŠYMAS PLATINTOJAS
Žalių obuolių, šviežios tešlos, citrinų ledinukų aromatas. Intensyvaus skonio, plieninės rūgšties, citrinų pyrago ir kreidos poskonio. (DM)
Noki citrina ir baltas persikas, pasifloros, ananasai, duonos ir skrebučio aromatai. Maloniai šviežias ir nokus. Ilgas poskonis. (IS)
(A–>Z)

Australija Penfolds Bin 311 Chardonnay 2019

Austrija Markowitsch Ried Schuttenberg Chardonnay 2022

Ispanija Arinzano Gran Vino Blanco 2019

Italija Weingut Tenuta Alois Lageder Löwengang Chardonnay 2020

JAV Lynx Chardonnay California 2022

JAV Marimar Estate Acero Chardonnay 2021

Prancūzija

Domaine Bader Mimeur
“Les Houillères” Chassagne Montrachet AOC 2015
Prancūzija La Croisade Reserve
Chardonnay 2023
MV GROUP DISTRIBUTION LT
SOMMELIER PARTNERS
Elegantiškas obuolių, citrinų, baltų gėlių aromatas. Lengvas, kremiškas, gaivios rūgšties. (DM) HEDONIST
Šviežių vaisių – citrinų, baltų persikų ir žalių obuolių aromatų puokštė. Burnoje sausas, gausios rūgšties, maloniai vaisiškas. Ilgai išliekančio poskonio ir gero brandinimo potencialo. Subalansuotas. (IS)
Šviežių citrinų, baltų persikų ir baltos duonos skrebučio aromatai. Burnoje sausas ir maloniai gaivus, juntami cirtusiniais vaisiai, vanilė. Ilgai išliekantis poskonis. (IS)
Ryškūs citrusų žievelių, greipfrutų minkštimo ir persikų aromatai. Šiek tiek juntamas jogurto ir baltos duonos skrebučio kvapas. Burnoje sausas, gaivios rūgšties, juntama ąžuolo įtaka. (IS)
Nokus citrinos žievelių, geltonųjų persikų, grietinėlės, skrebučio ir vanilės aromatas. Burnoje šviežių vaisių ir gaivios rūgšies duetas. (IS)
Ryškios auksinių obuolių, persikų ir citrinų cukatų aromatų natos. Baltos duonos skrebučio su vanilės ir apelsinų uogiene kvapas. Burnoje subtilios rūgšies, alkoholis puikiai subalanuotas, kaip ir brandinimas ąžuolo statinėje. (IS)
Sodrus vaisių ir gėlių, medaus, prieskonių aromatas. Burnoje juntama gaivi rūgštis, svarus. (NM)
Prieskoniais, vanile ir tropiniais vaisiais kvepiantis vynas. Burnoje tvirtas, svarus, gaivios rūgšties. Dominuoja citrusų žievelių, obuolių poskonis. (NM)
AMBER DISTRIBUTION LITHUANIA
Citrinų ir baltų persikų aromatas, ryški vanilė ir skrebutis. Burnoje ryški ąžuolo įtaka, minkšta rūgštis, citrinų ir vanilės skonis. (IS) RIMI
ŠALIS (A–>Z) VYNAS

Prancūzija La Grand Noir Chardonnay Pays d’Oc IGP 2022

Vokietija



Weingut Knipser Chardonnay Réserve 2020. Geriausias kategorijoje
Žalių obuolių aromatą pratęsia citrinų žievėlių ir baltų gėlių aromatai. Skonis sausas, gaivi rūgštis primena citrinų, žalių obuolių skonį. Kiek šildantis. (IS)
Intensyvus, išraiškingas vaisių ir gėlių aromatas. Burnoje pilnas, kompleksiškas, sviestiškas. Puikus švelnumo ir jėgos balansas. Itin sodrus ir nugludintas, intensyvus poskonis. (NM) SOMM
Craggy Range Te Muna Road Vineyard Sauvignon Blanc 2023
Greywacke Sauvignon Blanc 2023. Geriausias kategorijoje
NAUJOJI ZELANDIJA Te Mata Cape Crest Sauvignon Blanc Hawkes Bay 2022
Aukso medalių laimėtojai
ŠALIS (A–>Z) VYNAS

AUSTRIJA Weingut Hirsch Zobinger Gaisberg Riesling 2015. Geriausias kategorijoje

AUSTRIJA Weingut Knoll Riesling Ried Loibenberg Smaragd 2022

LIUKSEM-BURGAS

Desom Riesling Remich Primerberg Grand Premier Cru 2022
Bischöflichen Weingüter Trier Eitelsbacher Riesling Trocken 2020
Juodųjų serbentų, agrastų, prinokusių kivių aromatas. Gaivi rūgštis, minerališkas, ilgai išliekantis persikų kauliukų poskonis. (AD)
Šeivamedžių, jūros, baltų kaulavaisių, serbentų aromatas. Burnoje gan koncentruotas, nokus, lengvai salstelintis, su minerališkomis natomis pabaigoje. Gan ilgai išliekantis poskonis. Kremiška, noki rūgštis. (IB)
Vanilės, grietinėlės, sviesto natos. Prasiskverbia nokių melionų, mangų, antaninių obuolių bei agrastų kvapai. Svarus, kremiškas, sultingas. (MP)
HEDONIST
Cirtusų, gėlių aromatas. Burnoje juntamos medaus, prieskoninių žolelių natos. Gaivaus, minerališko stiliaus. Ilgai išliekančio, gerai subalansuoto skonio. Sukuria tvirto, bet jaunatviško vyno įspūdį. (NM) SOMM
Intensyvus, galingas kaulavaisių ir gėlių aromatas. Svarus, kompleksiškas, tvirtas ir galingas, ryškiai minerališkas. Ilgai išliekančio poskonio. (NM)
Dominuoja dūmų, šlapio akmens ir citrusų aromatai. Svarus, sodrus, kompleksiškas kaulavaisių, sunokusių obuolių ir kriaušių skonis. Ilgai išliekantis, gerai subalansuotas poskonis. (NM)
Žalsvai gelsvo atspalvio, žalių obuolių aromato vynas. Dominuoja gaivios, minerališkos natos, vynas svarus, gerai integruota rūgštis. (NM) RIMI
ŠALIS (A–>Z) VYNAS

VOKIETIJA Dr. Loosen Ürziger Würzgarten Riesling Dry GG 2021

VOKIETIJA Heymann-Löwenstein Kirchberg GG Riesling 2022
BALTASIS.








Citrusų, kaulavaisių, dūmų ir mineralų aromatai. Pilnas, puikiai sukomplektuotas, minerališkas ir gaivus skonis. Svarus obuolių, persikų, abrikosų aromatas. Puiki kokybė. (NM)
Sodrus citrusų ir sodo vaisių aromatas, kurį papildo svarainių ir baltų gėlių natos. Burnoje puikios rūgšties su aiškiais vaisių aromatais. Minerališkas, ilgai išliekantis. (IS) TERUA
ISPANIJA Baron De Ley 3 Vinas Blanco Reserva Rioja 2020
ITALIJA Amorale Tre Uva Bianco
ITALIJA Cantina Tobilno Pinot Grigio DOC BIO 2023
ITALIJA Ruffino Lumina Pinot Grigio Delle Venezie DOC 2023
Zibomare Zibibbo Terre Siciliane IGT 2023
NAUJOJI ZELANDIJA Mount Riley Marlborough Pinot Gris 2023. Geriausias kategorijoje
PRANCŪZIJA Marie Maria Novel 2020
VOKIETIJA Knipser Grauburgunder Pfalz 2023
Koncentruotas ąžuolo statinės aromatas: vanilės, kokosų, riešutų, lydyto sviesto ir jį lydinčios ananasų, citrinų kremo bei baltų persikų natos. Burnoje ąžuolo saldumą atsveria veržli rūgštis bei ilgai išliekantis citrinų gaivos kupinas poskonis. (MP)
Intensyvūs aromatai: kaulavaisių su egzotinių vaisių tonais bei prieskoniškomis natomis. Burnoje tęsiasi grietinėlės bei karamelės skonis, subtiliai minerališkas su ilga bei gaivia pabaiga. (ZZ)
Svarainių, ananasų, greipfrutų, nokių citrinų aromatas. Ilgai išliekantis minerališkas poskonis su puikiai išreikšta vaisiška nokių citrinų rūgštimi. (ZZ)
Vidutinio svarumo, kremiškos tekstūros vynas kvepia geltonais obuoliais, kriaušėmis, grietinėle bei skrebučiu. Burnoje sultingas, vos juntamų taninų, malonaus sūrstelėjusio poskonio. (MP)
Agrastų, svarainių, ananasų natos subtiliai dera su grietinėlės bei vanilės užuominomis. Saldus sviesto bei vanilės poskonis išduoda brandinimą ąžuolo statinėse ir kiek dominuoja. (MP)
MV GROUP DISTRIBUTION LT
Vidutinio intensyvumo gelsvos spalvos vynas kvepia geltonais obuoliais, persikais, greipfrutais, agrastais, baltaisiais serbentais su subtilia žoliška nata. Burnoje koncentruotas, galingas, ilgai išliekančio prieskoniško poskonio. (MP) IKI
Puikios koncentracijos, sultingas ir nokus. Persikų, ananasų, svarainių aromatus papildo vanilės, grietinėlės sviesto natos, išduodančios brandinimą ąžuolo statinėse. Burnoje puikios dermės, ilgai išliekančio poskonio. (MP)
SOMMELIER PARTNERS
Baltų kaulavaisių, titnago, parako, geltonų obuolių aromatas. Burnoje vos gazuotas, puikios vaisiškos rūgšties, titnago, žalio obuolio skonio. (ZZ) SOMM

Château Eugenie Haute Collection Cahors AOC 2008

Château Faizeau Selection Vieilles Vignes Montagne-Saint-Émilion AOP 2020. Geriausias kategorijoje

Château Magence Graves AOC 2011

Château Quintus Saint-Emilion Grand Cru AOC 2020

Château Sabazan Saint-Mont AOC 1998

Château Laroque St. Emilion Grand Cru 2014. Geriausias kategorijoje





Delas Chante Perdrix Cornas AOC 2019. Geriausias kategorijoje
Dominuoja prieskonių ir skrudinimo aromatų natos. Burnoje juntami gausūs taninai, prieskoniai, veriasi raudonos uogos. Prieskoninių žolelių poskonis. (NM) HEDONIST
Instensyvi rubino spalva. Kompleksiškas aromatas: nokių trešnių, vanilės, kardamono, skrebučio. Burnoje nokus, sausas, su gausiais taninais, šildantis, bet subalansuotas. Ilgai išliekančio poskonio. (IS)
Intensyvios rubino spalvos ir tamsių uogų niuansų vynas. Burnoje dominuoja serbentų natos, gervuogės ir sunokusios vyšnios. Vynas su gausiais taninais, gaivios rūgšties. (NM)
HEDONIST
Tamsių atspalvių ir nokaus aromato vynas. Burnoje pirma ataka salsvoka, dominuoja trešnių, gervuogių natos. Vėliau juos užgožia didelis taninų kiekis. (NM) LIVIKO
Dominuoja tamsių uogų, prieskonių, nukritusių lapų aromato natos. Itin gausu taninų ir rūgšties. Galingas, gastronominis vynas. (NM)
SOMMELIER PARTNERS
Didelė raudonų ir juodų uogų, prieskonių aromato puokštė. Burnoje gaivus, pilnas sunokusių taninų. Sodrus prieskonių, raudonų uogų poskonis. (NM) IKI
Melsva rubino spalva. Mėlynių, gervuogių, figų aromatas. Burnoje justi sodrus, nokus skonis, pilnas tamsių uogų. Gausus švelnių taninų. Intensyvus, sodrus vynas. (NM) LIVIKO
Delas Les Launes Crozes-Hermitage AOC 2021 Rubino atspalvis. Raudonų uogų aromatai. Burnoje gaivus, su raudonų uogų ir prieskoninių žolelių natomis. (NM) LIVIKO
Famille Perrin Chateau de Baucastel
Chāteauneuf du Pape AOC 2021
Gerard Bertrand Heritage Kosmos Bio 2020
Maison Castel Series Limitees Bio Gigondas Rouge AOC 2020
Tamsių uogų aromatas. Gervuogių ir trešnių uogienės skonį keičia kavos, šokolado pupelės. Sodrus poskonis, juntami taninai, puikiai integruotas ąžuolas. Galingas, tvirtas, bet subtilus vynas. (NM)
Intensyvi violetinė rubino spalva. Intensyvūs nokių vaisių aromatai: vyšnių, trešnių, gervuogių. Burnoje vaisiškas, tvirtų taninų ir šviežios rūgšties. (IS)
MV GROUP DISTRIBUTION LT
Sodrios spalvos, intensyvaus mėlynių ir figų aromato. Burnoje salsteli kaip uogų džemas, vėliau pereina į šokolado plytelės kartumą. Gera rūgšties, taninų ir nokumo dermė. Ilgai išlieka tamsių uogų poskonis. (NM) AMBER DISTRIBUTION

90 Ceppi Primitivo Appassimento Puglia IGP 2023

Barone Ricasoli Castello di Brolio Chianti Classico Gran Selezione Gaiole DOCG 2020

Cesari Amarone della Valpolicella Classico DOCG 2019

Collezione Privata Cosimo Varvaglione Primitivo di Manduria DOP 2019

Cottini Monte Zovo Sa’Solin Amarone della Valpolicella 2021

Doppio Passo Primitivo di Manduria Riserva D.O.C. 2020

Emporium Appassimento Rosso Salento IGT 2021

Fantini Edizione 22 Cinque Autoctoni 2020

Grimaldi Barbaresco DOCG Manzola 2020



Lucente Toscana IGT 2021
Džiovintų slyvų, mėlynių uogienės, naujos odos, rozmarinų bei vanilės aromato raudonasis. Burnoje salsvas, sultingas, švelnių taninų. Malonus gerti. (MP)
Jaunatviškas, taniniškas klasikinės struktūros raudonasis. Kvepia vyšniomis, gervuogėmis, bruknėmis, oda bei balzaminiu actu. Puiki koncentracija burnoje. Ilgai išliekantis poskonis. (MP) LIVIKO
Tvirtos struktūros sultingas vynas kvepia kakava, kava, gvazdikėliais, kurie pridengia vyšnias, bruknes, slyvas. Puiki dermė, ilgai išliekantis poskonis.(MP)
Sodri spalva. Pomidorų šakelių, tamsių uogų, slyvų aromatas. Burnoje puikiai sunokęs, uogieniškai salsteli. Gausių taninų, ilgai išliekančio gervuogių, mėlynių poskonio. (NM)
Tvirtas, galingas, sultingas raudonasis, kvepiantis vyšniomis, slyvomis, gvazdikėliais, oda, tabaku. Ilgai išliekančio poskonio, kompleksiškas. (MP) RIMI
Vyšnių spalvos, raudonų ir tamsių uogų, prieskonių, vanilės aromato vynas. Burnoje pirma ataka saldi, vėliau juntami sunokę ir švelnūs taninai. Subtilus, puikiai subalansuotas, vaisiškas ir elegantiškas. (NM)
Figų, džiovintų slyvų, juodų vyšnių bei kavos aromatai kuria saldumo įspūdį. Tačiau burnoje sausas, sultingas, tvirtų taninų, prieskoniškas. Gera dermė, ilgai išliekantis poskonis. (MP)
Kompleksiškas, sodrus, galingas. Daug sunokusių tamsių uogų, uogienės, figų, šokolado aromato ir skonio natų. Kompleksiškas, puikiai subalansuotas. (NM)
Vyšnių, bruknių, gervuogių, odos aromatai persipina su miško paklotės bei džiovintų rožių žiedlapių natomis. Burnoje galingų taninų, sultingos rūgšties, ilgai išliekančio poskonio vynas. (MP)
Sodrios purpuro spalvos vynas kvepia gervuogėmis, juodomis slyvomis, grietinėle bei vanile. Burnoje sultingas, sausokų taninų, šildančio prieskoniško poskonio. (MP)
Švarus, sultingas, puikios koncentracijos vynas kvepia juodomis vyšniomis, slyvomis, gvazdikėliais, rozmarinu, tabaku bei nauja oda. Ilgai išliekančio, elegantiško poskonio vynas. (MP)
Koncentruotas, kompaktiškas, kvepiantis gervuogėmis, juodomis vyšniomis bei juodomis slyvomis, kurias papildo grietinėlės, tušo, naujos odos, vanilės natos. Burnoje vynas galingas, tvirtų taninų, bet ir puikios dermės. (MP)
MV GROUP DISTRIBUTION LT
TRIDENS
AMBER DISTRIBUTION LITHUANIA

Menhir Albanegra Rosso IGT 2022

Paolo Leo Taccorosso Negroamaro IGP 2017

Pietra Pura Mandus Primitivo di Manduria



Querciabella Chianti Classico DOCG 2020

Ruffino Riserva Ducale Oro Chianti
Classico Gran Selecione 2020

San Marzano Susco IGP 2020

Sensi Vegante Chianti 2021

Tedeschi Capitel San Rocco Valpolicella Ripasso Superiore 2020




Vynas kvepia avietėmis, vyšniomis ir prieskoniais. Burnoje minkštas, subtilus, elegantiškų taninų. Švelnaus, vaisiško vyno pojūtis. (NM) TURLEKSA
Sultingas, tvirtas bei veržlus raudonasis kvepia šviežiomis gervuogėmis, juodaisiais serbentais, serbentų šakelėmis. Vėliau ima skleistis vanilė, kedras. Puiki dermė ir ilgai išliekantis poskonis. Gero brandos potencialo vynas. (MP)
Gervuogių uogienės, mėlynių, slyvų, juodųjų serbentų aromatas bei skonis su subtiliomis gvazdikėlių, kedrų natomis. Vynas tvirtas, sultingas, kiek uždaras, tačiau puikios koncentracijos ir ilgai išliekančio poskonio. (MP)
Mėlynų slyvų, trešnių, figų aromatas. Burnoje galingas, sodraus tamsių uogų ir šokolado skonio. Nokus, bet gaivus. Daug švelnių taninų, labai geras vaisiškumo ir gaivos balansas. Kompleksiškas ir elegantiškas. (NM)
Blyški rubino spalva su plačiu granato krašteliu. Vynas skleidžia šviežių vyšnių, aviečių, sausų miško lapų bei įkaitusio smėlio aromato natas. Burnoje sultingas, tvirtų taninų. Struktūrą puikiai užpildo aviečių, žemuogių, grietinėlės natos. Ilgai išliekantis elegantiškas poskonis. (MP)
Raudonų vyšnių, bruknių, slyvų aromatas su subtilia prieskonių nata. Burnoje juntami tvirti taninai, veržli rūgštis. Ilgai išlieka raudonų vyšnių poskonis. (MP)
BALTAS DOBILAS
Puikios dermės, koncentracijos bei ilgai išliekančio poskonio vynas kvepia juodomis vyšniomis, slyvomis, nauja oda, saldymedžiu. Kiek šildančio poskonio. (MP) TRIDENS
Intensyvus gervuogių ir trešnių aromatas. Burnoje pirma ataka saldi, vėliau ją keičia gausių taninų pojūtis. Poskonis salsvokas, juntamos džiovintų uogų natos. (NM)
Elegantiškas raudonų uogų, vyšnių ir žemuogių aromatas. Burnoje veriasi vyšnių kauliukų, priekoninių žolelių skonis. Poskonis su juntamais minkštais, gausiais ir sunokusiais taninais. Subtilus vynas. (NM)
RIMI
Persipinantys žolelių, balzaminio acto, vyšnių, pomidorų lapų bei saldymedžio aromatai. Burnoje tvirtas, sultingas, raudonų vyšnių skonio bei aromato. (MP)
Raudonų uogų ir prieskoninių žolelių aromatų dermė. Vyšnių skonį burnoje keičia gausūs taninai, juntama daug gaivios rūgšties. Vynas puikaus balanso, ilgo, intensyvaus uogų poskonio.(NM)
Tamsių vyšnių, gervuogių, odos bei vanilės ankšties aromatas. Burnoje vynas tvirtas, sultingas, ilgai išliekančio poskonio. (MP)
Džiovintų slyvų, figų, razinų aromatas persipina su vyšnių, žolelių, gvazdikėlių natomis. Burnoje sultingas, tvirtokų taninų. (MP)
Džiovintų slyvų, juodų vyšnių, figų aromatą subtiliai papildo ąžuolo natos – vanilė bei gvazdikėliai. Burnoje tvirtas, kompaktiškas, sultingas. Puikios kokybės, galingas vynas. (MP)
LIVIKO

Aalto Ribera del Duero DO 2021





Alejandro Fernández Tinto Pesquera
Reserva Ribera del Duero DOP 2018. Geriausias kategorijoje
Gran Vino Tinto 2018
Descendientes de J.Palacios Corullon Bierzo DO 2006
Marques de Grinon Petit Verdot
Ramon Bilbao Crianza Rioja DOC 2020
Intensyvus juodų uogų, vanilės, pipirų aromatas. Ilgai išliekantis vanilės, pipirų, uogų poskonis, Gausių taninų ir gaivios rūgšties vynas. (AD)
Skrudinimo, prieskonių, šokolado, tabako, slyvų, gervuogių, juodųjų serbentų aromatas. Išraiškingas, elegantiškas, labai ilgai išliekantis prieskonių, šokolado, gervuogių poskonis. Puikaus balanso, gaivios rūgšties, švelnių taninų vynas. (AD)
Taniniškas, koncentruotas vynas, kvepiantis tamsiomis uogomis, amaretu, vanile. Gausu taninų bei rūgšties. (MP)
Brandaus kompleksiško aromato bei tvirtos struktūros raudonasis. Skleidžiasi vyšnių, slyvų, tabako, odos, vanilės, kokosų aromatai. Burnoje sultingas, ilgai išliekančio poskonio. (MP)
Prieskonių, slyvų, vanilės aromatas. Vaisiškas prieskonių poskonis. Gaivi rūgštis. (AD)
Taurėje skleidžiasi vanilės, naujos odos, mėlynių, gervuogių bei juodų vyšnių aromatai. Burnoje vynas tvirtų, smulkių taninų bei veržlios rūgšties. Sultingas, ilgai išliekančio poskonio. (MP)
PORTUGALIJOS RAUDONASIS. Aukso medalių laimėtojai

Lacrau Reserva Douro Tinto DOC 2018

Quinta do Crasto Reserva Vinhas Velhas 2021

Secret Spot Douro Tinto DOC 2019. Geriausias kategorijoje

TRIDENS
Labai intensyvus juodųjų serbentų, eukaliptų, šokolado, saldymedžių, grietinėlės, gvazdikėlių aromatas. Kompleksiškas, tvirto kūno ir taninų. Koncentruotas, bet labai gerai subalansuotas. Ilgai išliekančio poskonio. (DM) HEDONIST
Nepermatomos spalvos vynas saldžiai kvepia mėlynėmis, gervuogėmis, vanile, nauja oda, migdolais. Burnoje tvirtas, veržlus ir sultingas. Ilgai išliekančio saldžių prieskonių poskonio. (MP)
Sodri tamsiai raudona spalva. Kompleksiškas, intensyvus prieskonių, vanilės, slyvų šokolado, juodųjų serbentų aromatas. Gausūs, tvirti taninai, galinga, gaivi rūgštis. Ilgas prieskonių, vanilės, juodų uogų poskonis. (AD)
Koncentruotas, elegantiškas, puikios dermės vynas. Kvepia vanile, nauja oda, saldymedis puikiai dera su koncentruotomis tamsių uogų natomis. Burnoje gausūs, tačiau švelnūs taninai sukuria malonią struktūrą, kurią užpildo nuosaikus vaisiškumas. (MP)

ARGENTINA Mascota Viney Unanime Malbec 2020

ARGENTINA Achaval-Ferrer Quimera 2019



ARGENTINA Trapiche Terroir Series Finca Laborde 2021
De Martino Familia Cabernet Sauvignon Maipo Valley 2010
Errazuriz Don Maximiano 2017. Geriausias kategorijoje
Vidutinio intensyvumo juodųjų serbentų, trešnių, prieskonių aromatas. Daug švelnių taninų, gaivi rūgštis. Vaisiškas vynas su prieskonių, vanilės poskoniu. (AD)
Intensyvus, kompleksiškas trešnių, slyvų, šokolado, vanilės aromatas. Gaivi rūgštis, gausūs švelnūs taninai. Ilgai išliekantis elegantiškas slyvų, vanilės, prieskonių poskonis. (AD)
Koncentruotas, tvirtos struktūros vynas kvepia nokiomis ugomis: vyšniomis, mėlynėmis, juodaisiais serbentais, gvazdikėliais, saldymedžiu. Puiki dermė ir itin ilgai išliekantis poskonis. (MP)
Sultingas, tvirtas juodaisiais serbentais, vanile, nauja oda kvepiantis raudonasis. Tvirtą struktūrą burnoje puikiai užpildo sultingi, nokūs vaisiai, kurie vis dar ilgai juntami poskonyje. (MP)
Sodrios spalvos vynas kvepia kakava, kava, vanile, juodomis vyšniomis bei slyvomis, išnyra gaivios kedro, mėtų užuominos. Burnoje vynas veržlus, sultingas, puikios struktūros. (MP)
PINOT NOIR. Aukso medalių laimėtojai

AUSTRIJA




Markowitsch Pinot Noir Reserve 2020
Cono Sur Ocio Pinot Noir 2020
JAV Joseph Drouhin
RoseRock Pinot Noir
Oregon Eola-Amity Hills 2021
Prosper Maufoux Les Gravieres Premier Cru Santenay Rouge 2019
Knipser Spatburgunder Kirschgarden 2019. Geriausias kategorijoje
Elegantiškas, kvapnus, struktūriškas. Saldžių braškių, vyšnių, bruknių aromatus nuostabiai papildo kakavos, vanilės, kepinių prieskonių aromatai. Sultingas, ilgai išliekantis ir kvapnus poskonis. (MP)
Intensyvaus, nokaus juodųjų uogų aromato, juntamos džiovintos slyvos, kakava, grietinėlė. Svarus ir tvirtų taninų, juntama naujo ąžuolo įtaka. Nokus, vaisiškas. Ilgai išliekančio poskonio. (DM)
Sodrūs gervuogių, slyvų džemo, dūmų, šokolado aromatai. Lengvo kūno ir šilkinių taninų. Harmoningas, vidutinio ilgumo poskonio. (DM)
Intensyvios rubino spalvos. Vidutinio intensyvumo prieskonių, uogų, gėlių aromatas. Burnoje ilgai išlieka švelnios rūgšties, kompleksiškas skrudinimo, prinokusių vyšnių poskonis. (AD)
Rubino spalvos. Vidutinio intensyvumo elegantiškas vyšnių, raudonų serbentų, žolelių, prieskonių aromatas. Burnoje ilgai išliekantis gaivios, švelnios rūgšties, prieskonių ir raudonų uogų poskonis. (AD)

ŠALIS (A–>Z) VYNAS
ITALIJA San Donatino Chianti Classico Riserva 2016. Geriausias kategorijoje
ŠALIS (A–>Z) VYNAS

ITALIJA



Tormaresca Calafuria
Rosato Salento IGT 2023
ITALIJA Leone de Castris Five Roses Salento IGT 2023. Geriausias kategorijoje
NAUJOJI ZELANDIJA Marlborough Sun Sauvignon Rosé 2022
NAUJOJI ZELANDIJA Picton Bay Marlborough Blanc Blush 2021
APRAŠYMAS (NM) PLATINTOJAS
Vidutinio intensyvumo spalva su granito atspalviu. Raudonų aviečių, prieskonių ir švelnus džiovintų spanguolių aromatas. Taniniškas vynas. (IS)
SOMMELIER PARTNERS
Kvepia laukinėmis žemuogėmis, avietėmis, grietinėle. Burnoje žaismingas, malonios rūgšties, uogiško poskonio. (IS) BALMERK
Ryški rožinė spalva. Aviečių, braškių, prinokusių persikų, rožių žiedlapių aromatas. Gaivus, vaisiškas, intensyvus vynas. (IS) VYNO KLUBAS
Blyški persikų spalva. Nektarinų, baltųjų persikų, žaliųjų paprikų, smidrų, raudonųjų serbentų lapų aromatas. Burnoje žaismingas, gaivus ir sultingas vynas. (KB)
Blyški spalva. Baltųjų serbentų, agrastų, nesunokusių braškių aromatas. Burnoje sultinga rūgštis, vaisiškas vynas. (IS) IKI
NATŪRALIAI SALDUS VYNAS. Aukso medalių laimėtojai

PRANCŪZIJA Thomas Barton Sauternes 2016

AUSTRIJA Zantho Beerenauslese Burgenland 2020. Geriausias kategorijoje
Tankus, galingas, prieskoniškas. Kompleksiško aromato, skleidžiasi skrebutis, medus, cukruotos citrinų žievelės, persikai, prieskoniai. Burnoje ilgai išliekančio koncentruoto skonio bei minerališko poskonio. (MP)
Nuostabios dermės, koncentruoto aromato bei skonio saldusis vynas kvepia medumi, konservuotais persikais, ananasais bei citrinų žievelėmis. Ilgai išlieka elegantiškas poskonis. (MP)




Graham’s Quinta dos Malvedos Vintage Port 2018
Nepermatomos rubino spalvos portas kvepia mėlynėmis, slyvomis, gervuogėmis, šokoladu. Burnoje puiki dermė tarp saldumo bei rūgšties ir taninų. Maloniai šildančio poskonio. (MP) MV GROUP DISTRIBUTION LT
Andresen Porto Century Tawny 10 Year Old Kiek uždaro, koncentruoto aromato portas, kvepiantis slyvomis, oda, vanile. Burnoje gana taniniškas. (MP)
Andresen Porto Vintage 2011
Quinta do Crasto Tawny 10 YO. Geriausias kategorijoje
Gilios nepermatomos spalvos portas kvepia juodomis uogomis, tušu, oda, vanile. Burnoje koncentruotas, vaisiškas, tačiau puikios dermės ir ilgai išliekančio poskonio. (MP)
Blyškios granatų spalvos vynas kvepia džiovintomis bruknėmis, apelsinų cukatais, oda, vanile, prieskoniais. Burnoje elegantiškas, puikiai subalansuotas bei puikiai integruoto alkoholio. (MP) PRIKĖ

ŠALIS
ISPANIJA Lustau Pedro Ximénez San Emilio. Geriausias kategorijoje
Gintaro spalvos vynas kvepia figomis, džiovintomis slyvomis, apelsinų marmeladu, kavos bei kakavos milteliais. Burnoje tirštas, kremiškos tekstūros bei itin saldus. Visa tai subalansuoja sultinga rūgštis. (MP)
ŠALIS PAVADINIMAS
VOKIETIJA Weingut Knipser
PORTUGALIJA Quinta do Crasto
VYNAS
Moutard Cuvée 6 Cépages Vintage Brut Nature 2012
PLATINTOJAS
Sidabro MV GROUP DISTRIBUTION LT
Sidabro ir bronzos medalių laimėtojai
Brimoncourt Rose Brut Ay
Charles-Heidsieck Blanc De Blancs
Paul Chambois Brut blanc
Deutz Brut Classic
Prince Laurent Rose brut
ŠALIS (A–>Z) VYNAS
PLATINTOJAS
Sidabro TURLEKSA
Sidabro MV GROUP DISTRIBUTION LT
Sidabro IKI
Bronzos LIVIKO
Bronzos IKI
Sidabro ir bronzos medalių laimėtojai
ISPANIJA Aula Cava Brut Nature
ISPANIJA DV Cava N°11 Rose Brut Organic DO 2023
ISPANIJA Llopart Integral Brutl Nature Corpinnat
ITALIJA Castello Bonomi Cruperdu Grande Annata Franciacorta Extra Brut DOCG 2016
LIUKSEMBURGAS Poll Fabaire Crémant de Luxembourg Brut
PIETŲ AFRIKA Stone Pine Cap classic Brut
PRANCŪZIJA Gerard Bertrand Heritage AOP Crémant de Limoux 2021
PRANCŪZIJA Lacheteau Tete de Cuvee Cremant de Loire brut
PRANCŪZIJA Le Grand Noir Crémant de Limoux AOC
PRANCŪZIJA Maison Castel Cremant de Bourgogne AOC Brut
Sidabro AMBER DISTRIBUTION LITHUANIA 4 4 4 4 4
PLATINTOJAS
Sidabro KALNAPILIS
Sidabro TURLEKSA
Sidabro BALTAS DOBILAS
Sidabro HEDONIST
Sidabro RIMI
Sidabro IKI (LGCF)
Sidabro PRIKĖ LIETUVA
Sidabro MV GROUP DISTRIBUTION LT
Sidabro LIVIKO
ŠALIS (A–>Z) VYNAS
PRANCŪZIJA Moingeon Prestige, Cremant de Bourgogne, Brut blanc
PRANCŪZIJA Phillipe Viallet Cremant de Savoie AOP
PRANCŪZIJA To Die For, Carod, Cremant de Die, Brut blanc
VOKIETIJA HXM Royal Cremant Mittelrhein, Riesling Brut blanc
VOKIETIJA Ruppertsberger Deutscher Sekt Riesling Extra Dry NV
AUSTRIJA Zantho Grüner Veltliner Brut NV
ISPANIJA DV Cava Expression Brut Reserve DO 2021
ISPANIJA Mar De Frades Albariño Atlántico Brut Nature Rias Baixas DO 2022
ISPANIJA Mas Olive Gran Sativa Cava Reserva Nostra Brut Nature NV
ISPANIJA Masia Cava Gran Cuvee Brut Organic
PRANCŪZIJA 1895 Domaine de La Ville de Colmar, Cremant d’Alsace
PRANCŪZIJA Calvet Cremant de Bordeaux Brut 2022
PRANCŪZIJA Louis Eschenauer, Cremant de Bordeaux, Brut
PRANCŪZIJA Timberlay, Cremant de Bordeaux, Brut rose
MEDALIS PLATINTOJAS
Sidabro IKI
Sidabro BALTAS DOBILAS
Sidabro IKI
Sidabro IKI
Sidabro RIMI
Bronzos RIMI
Bronzos TURLEKSA
Bronzos TRIDENS
Bronzos RIMI
Bronzos AMBER DISTRIBUTION LITHUANIA
Bronzos IKI
Bronzos AMBER DISTRIBUTION LITHUANIA
Bronzos RIMI LIETUVA (LGCF)
Bronzos IKI
Sidabro ir bronzos medalių laimėtojai
ŠALIS (A–>Z) VYNAS
ITALIJA Proverbio Prosecco
ITALIJA Sensi Prosecco Collezione Extra Dry NV
ITALIJA Bottega Gold Brut Prosecco DOC
ITALIJA Casa Canevel Sètage Brut Valdobbiadene Prosecco Superiore DOCG
ITALIJA Bottega Il Vino Dei Poeti Prosecco DOC 2023
ITALIJA Sensi 18K Prosecco Spumante Brut 2023
ITALIJA Sensi 18K Prosecco Rose Spumante Brut 2023
ITALIJA Bottega Rose Gold Spumante Brut 2023
MEDALIS PLATINTOJAS
Sidabro (geriausias kategorijoje) KALNAPILIS
Sidabro (geriausias kategorijoje) RIMI
Sidabro (geriausias kategorijoje) TRIDENS
Sidabro LIVIKO
Sidabro TRIDENS
Sidabro RIMI
Sidabro RIMI
Sidabro TRIDENS 4 4
ŠALIS (A–>Z) VYNAS
ITALIJA Pirani Prosecco Extra Dry DOC
NAUJOJI ZELANDIJA Vicarage Lane Bubbly Sauvignon Blanc
VOKIETIJA Hans Baer Riesling Sekt
ITALIJA Escanza Prosecco Spumante DOC Brut
ITALIJA Pirani Prosecco Millesimato Rose Extra Dry DOC
PRANCŪZIJA Domaine Terrebone IGP Provencal Method
MEDALIS PLATINTOJAS
Sidabro TURLEKSA
Sidabro KALNAPILIS
Sidabro AIBĖ (LGCF)
Bronzos KALNAPILIS
Bronzos TURLEKSA
Bronzos NORFA (LGCF)
Sidabro medalio laimėtojas
ŠALIS VYNAS
NAUJOJI ZELANDIJA Vicarage Lane Bubbly Sauvignon Blanc
PET NAT PUTOJANTIS. Sidabro ir bronzos medalių laimėtojai
MEDALIS PLATINTOJAS
Sidabro KALNAPILIS
ŠALIS VYNAS (A–>Z)
PRANCŪZIJA Gerard Bertrand Papilou Pet-Nat Rose BIO 2021
PRANCŪZIJA La Grange Tiphaine Rosé Rosa Rosam 2023, Prancūzija
PRANCŪZIJA Domaine Ampelhus Le Pet Nat
MEDALIS PLATINTOJAS
Sidabro PRIKĖ LIETUVA
Sidabro (geriausias kategorijoje) SOMMELIER PARTNERS
Bronzos VYNO KLUBAS
CHARDONNAY. Sidabro ir bronzos medalių laimėtojai
ŠALIS (A–>Z) VYNAS
ČILĖ Casa Bollen, Casablanca Valey, Chardonnay 2023
ISPANIJA Torres Gran Vina Sol Chardonnay Catalunya Organic 2022
MEDALIS PLATINTOJAS
Sidabro IKI
Sidabro AMBER DISTRIBUTION LITHUANIA
ŠALIS (A–>Z) VYNAS MEDALIS PLATINTOJAS
PRANCŪZIJA Phillippe Bouchard Bourgogne Chardonnay 2022
PRANCŪZIJA Pellehaut Chardonnay IGP 2023
PRANCŪZIJA Domaine Jean-Marc Brocard Vau de Vey Chablis Premier Cru AOC 2022
VOKIETIJA Ihringer Winklerberg Chardonnay Kabinett 2023
PRANCŪZIJA M. Vigneron Chardonnay 2021
ŠALIS (A–>Z) VYNAS
ČILĖ Leyda Reserva Sauvignon Blanc Leyda Valley 2022
ČILĖ Cono Sur Bicicleta Reserva Sauvignon Blanc 2022
ISPANIJA Torres Fransola Penedes Organic 2022
ITALIJA Cantina Toblino Sauvignon DOC BIO 2022
NAUJOJI ZELANDIJA Kim Crawford Small Parcels Marlborough Sauvignon Blanc 2022
NAUJOJI ZELANDIJA Leefield Station Sauvignon Blanc 2022
NAUJOJI ZELANDIJA Villa Maria Reserve Marlborough Sauvignon Blanc Wairau Valley 2022
NAUJOJI ZELANDIJA Vicarage Lane Sauvignon Blanc 2023
PRANCŪZIJA Lacheteau Les Closiers Pouilly-Fume 2021
VOKIETIJA Ruppertsberger Sauvignon Blanc Pfalz 2023
ČILĖ Casa Bollen, Leyda Valey, Sauvignon blanc 2023
ČILĖ Aetos Reserva Privada Sauvignon blanc 2023
PRANCŪZIJA Petite Fontaine Sancerre AOC 2023
PRANCŪZIJA Domaine Gitton Galinot Silex Sancerre Blanc AOC 2022
Sidabro IKI
Sidabro TURLEKSA
Sidabro LIVIKO
Sidabro RIMI
Bronzos BALTAS DOBILAS
Sidabro BALMERK
Sidabro LIVIKO
Sidabro AMBER DISTRIBUTION LITHUANIA
Sidabro PRIKĖ LIETUVA
Sidabro MV GROUP DISTRIBUTION LT
Sidabro SOMMELIER PARTNERS
Sidabro AMBER DISTRIBUTION LITHUANIA
Sidabro KALNAPILIS
Sidabro MV GROUP DISTRIBUTION LT
Sidabro RIMI
Bronzos IKI
Bronzos AIBĖ (LGCF)
Bronzos HEDONIST 4 4
Bronzos PRIKĖ LIETUVA
ŠALIS (A–>Z) VYNAS MEDALIS PLATINTOJAS
AUSTRALIJA Penfolds Koonunga Hill Riesling 2018
AUSTRIJA Mayer Riesling 2021
VOKIETIJA Petri Riesling Trocken Pfalz 2023
VOKIETIJA Weinhaus Gebrüder Steffen Riesling Steillage 2023
AUSTRIJA Pfaffl Vom HausRiesling Niederosterreich
Sidabro PRIKĖ LIETUVA
Sidabro KALNAPILIS
Sidabro TURLEKSA
Sidabro RIMI
Bronzos BALMERK
VOKIETIJA Markus Molitor Ürziger Würzgarten Riesling Kabinet Spatlese White Capsule 2018 Bronzos HEDONIST
ŠALIS (A–>Z) VYNAS MEDALIS PLATINTOJAS
AUSTRIJA Vom Haus Gruner Veltliner Niederosterreich 2023
AUSTRIJA Mayer Grüner Veltliner 2021
AUSTRIJA Allram Renner 1er GrünerVeltliner 2022
ISPANIJA Mar De Frades Albariño Atlántico Rias Baixas DO 2023
ISPANIJA Bodegas Naia K-naia Verdejo Rueda DO 2023
ITALIA Casa Charlize Cuvee Alba Vino Bianco
ITALIJA Sensi Collezione 1860 Pinot Grigio 2023
ITALIJA Marco Polo Pinot Grigio 2023
ITALIJA Bossi Fedrigotti Pinot Grigio Valdadige DOC 2023
ITALIJA Santa Sofia Soave Classico Montefoscarino 2022
ITALIJA Terredora Greco di Tufo DOCG 2022
ITALIJA Feudi di San Gregorio Greco di Tufo DOCG 2023
ITALIJA Tommasi Le Rosse Pinot Grigio Veneto IGT
ITALIJA Sella&Mosca Terre Bianche Cuvee 161 Alghero Torbato DOC 2020
Sidabro LIVIKO 4 4 4 4
Sidabro BALMERK
Sidabro KALNAPILIS
Sidabro PRIKĖ LIETUVA
Sidabro TRIDENS
Sidabro HEDONIST
Sidabro BALMERK
Sidabro RIMI
Sidabro IKI
Sidabro LIVIKO
Sidabro RIMI
Sidabro TURLEKSA
Sidabro MV GROUP DISTRIBUTION LT
Sidabro BALMERK
ŠALIS (A–>Z)
ITALIJA iL Rocchin Gavi del Comune di Gavi DOCG 2023
ITALIJA Paolo Leo Triade Bianco Fiano-Falanghina-Greco IGP 2022
PAR Reyneke Biodynamic Chenin Blanc 2021
PORTUGALIJA Mendes & Symington Contacto 2023
PRANCŪZIJA Domaine du Touja, Cotes de Gascogne blanc 2022
PRANCŪZIJA Maison Castel Series Limitees Condrieu Blanc 2021
VOKIETIJA Ihringer Fohrenberg Weißer Burgunder Kabinett trocken 2023
AUSTRIJA Nikolaihof Ried Im Weingebirge Grüner Veltliner Smaragd 2019
ISPANIJA Ramon Bilbao Verdejo Rueda DO 2022
PRANCŪZIJA Côtes du Rhône Clef de l’Enclave 2022
SAKARTVELAS Teliani Valley Winery 97 Tsolikouri 2023
Sidabro ir bronzos medalių laimėtojai
Sidabro TURLEKSA
Sidabro TURLEKSA
Sidabro PRIKĖ LIETUVA
Sidabro MV GROUP DISTRIBUTION LT
Sidabro IKI
Sidabro AMBER DISTRIBUTION LITHUANIA
Sidabro RIMI
Bronzos SOMM
Bronzos TRIDENS
Bronzos KALNAPILIS
Bronzos BALMERK
ŠALIS (A–>Z) VYNAS MEDALIS PLATINTOJAS
PRANCŪZIJA Domaine Aimé Blouzard Les As 2022
VENGRIJA Kristinus Oliver Furmint 2021
PORTUGALIJA Nossa Calcário Bical 2023
SAKARTVELAS Dakishvili Family Selection Rkatsiteli Amber Dry 2020, Sakartvelas
AUSTRIJA Weingut Heinrich Naked white 2021
Sidabro SOMMELIER PARTNERS
Sidabro TRIDENS
Sidabro VINO DIVINO
Sidabro (geriausas kategorijoje) DAKTARO VYNAS
Bronzos BALTAS DOBILAS
ŠALIS (A–>Z) VYNAS MEDALIS PLATINTOJAS
ITALIJA Frescobaldi Alie Ammiraglia Rosato Toscana 2023
PRANCŪZIJA Pellehaut Harmonie de Gascogne Rose IGP 2023
Sidabro TURLEKSA 4 4 4 4
Sidabro AMBER DISTRIBUTION LITHUANIA
ŠALIS (A–>Z)
PRANCŪZIJA Chateau Gassier Le Pas Du Moine ECO 2023
PRANCŪZIJA Marcel Martin La Jaglerie Rose d’Anjou 2023
ITALIJA Ruffino Rosatello Toscana IGT
ITALIJA Menhir N`Zero Rosato Negroamaro/Susumaniello IGT 2023
PRANCŪZIJA Domaine Terrebone IGP Mediterranee 2023
PRANCŪZIJA Plaisir’ose, IGP Mediterranee rose 2023
PRANCŪZIJA Château de Saint Martin Eternelle Favorite Rosé 2022
PRANCŪZIJA Aula Bobal Rosé 2022
PLATINTOJAS
Sidabro PRIKĖ LIETUVA
Sidabro RIMI LIETUVA (LGCF)
Bronzos TRIDENS
Bronzos TURLEKSA
Bronzos NORFA (LGCF)
Bronzos AIBĖ (LGCF)
Bronzos BALTAS DOBILAS
Bronzos KALNAPILIS
4 4 4
VYNAS (A–>Z)
Château Bois Pertuis, Bordeaux 2021
Château de Tholomies Eclipse, AOP Minervois 2019
Côtes du Rhône Clef de l’Enclave Vieilles Vignes 2022
Côtes du Rhône Villages Réserve de L’Enclave 2021
Domaine Tour Trencavel Minervois AOP Bio 2021
Ogier L’orientale Crozes-Hermitage 2022
Pellehaut Les Marcottes IGP 2022
Rothschild Mouton Cadet Heritage Bordeaux AOC 2019
PLATINTOJAS
Sidabro IKI
Sidabro IKI
Sidabro KALNAPILIS
Sidabro KALNAPILIS
Sidabro AIBĖ (LGCF)
Sidabro PRIKĖ LIETUVA
Sidabro TURLEKSA
Sidabro BALMERK
ITALIJOS RAUDONASIS. Sidabro ir bronzos medalių laimėtojai
VYNAS (A–>Z) MEDALIS PLATINTOJAS
Amorale Rosso Puglia IGT
Emporium Primitivo Di Manduria DOC 2022
Sidabro BALMERK
Sidabro TRIDENS
VYNAS (A–>Z)
Maxale Primitivo Appassimento Puglia IGT 2022
Pietra Pura Cotis Primitivo di Manduria DOC 2019
Sensi Collezione 1860 Primitivo 2023
Sensi Dal Campo Chianti Riserva 2020
Marco Polo Appassimento 2023
Preciso Primitivo Apassimento 2022
MEDALIS PLATINTOJAS
Sidabro LIVIKO
Sidabro LIVIKO
Sidabro RIMI
Sidabro RIMI
Bronzos IKI
Bronzos KALNAPILIS
VYNAS (A–>Z) MEDALIS PLATINTOJAS
Aula Crianza 2020
Gran Mirador Reserva Valencia DO 2019
Legaris Reserva Ribera Del Duero DO 2019
Marques de Murrieta Rioja Gran Reserva DOCa 2016
Matsu el Picaro Toro DO 2022
Terramagna Ciro Black Edition Coupage Crianza 2022
Torres Perpetual Priorat DOC 2018
Sidabro KALNAPILIS
Sidabro BALMERK
Sidabro PRIKĖ LIETUVA
Sidabro HEDONIST
Sidabro BALMERK
Sidabro TURLEKSA
Sidabro AMBER DISTRIBUTION LITHUANIA
VYNAS MEDALIS PLATINTOJAS
Lago Sagrado Vinho Regional Lisboa 2021
Bronzos BALMERK
Sidabro ir bronzos medalių laimėtojai
ŠALIS (A–>Z) VYNAS APRAŠYMAS PLATINTOJAS
AUSTRALIJA Peter Lehmann Portrait Shiraz 2021
ČILĖ Marques de Casa Concha Cabernet Sauvignon 2020
JAV Lynx Petit Sirah Zinfandel California 2023
PAR The Chocolate Block 2022
PIETŲ AFRIKA Stone Pine, Stellenbosch, Pinotage 2021
ČILĖ Conde Jose Reserva Carmenere 2022
Sidabro TRIDENS
Sidabro AMBER DISTRIBUTION LITHUANIA
Sidabro LIVIKO
Sidabro PRIKĖ LIETUVA
Sidabro IKI
Bronzos AIBĖ (LGCF)
Sidabro ir bronzos medalių laimėtojai
ŠALIS (A–>Z)
AUSTRIJA Markowitsch Ried Rosenberg 1QTW 2021, Austrija
AUSTRIJA Zantho Blaufränkisch Burgenland 2022
LIBANAS Chateau Musar Hochar Pere et Fils Rouge Bekaa Valley 2020
VENGRIJA Tuzko Birtok 7Frankos 2020
Sidabro (geriausias kategorijoje) VYNO KLUBAS
Sidabro RIMI
Sidabro HEDONIST
Sidabro MV GROUP DISTRIBUTION LT
SAKARTVELAS Corporation Georgian Wine Umano Mukuzani 2020 Bronzos RIMI
UKRAINA Biologist Intriga Red 2020
Bronzos VYNO KLUBAS
PINOT NOIR. Sidabro ir bronzos medalių laimėtojai
ŠALIS (A–>Z) VYNAS
AUSTRALIJA Penfolds Bin 23 Pinot Noir 2020
ČILĖ Leyda Single Vineyard Las Brisas Pinot Noir Leyda Valley 2020
PLATINTOJAS
Sidabro PRIKĖ LIETUVA
Sidabro BALMERK
JAV Abbott Claim Abbott Claim Vineyard Pinot Noir Yamhill - Carlton AVA Oregon 2018 Sidabro VYNO KLUBAS
N. ZELANDIJA Craggy Range Te Muna Road Vineyard Pinot Noir
BALTAS DOBILAS 4 4 4 4 4 4
ŠALIS (A–>Z) VYNAS
NAUJOJI ZELANDIJA Villa Maria Reserve Marlborough Pinot Noir 2020
PRANCŪZIJA Phillippe Bouchard Bourgogne Pinot Noir
PRANCŪZIJA Maison Champy Beaune Vieilles Vigne 2018
ČILĖ Casa Bollen, Leyda Valey, Pinot Noir
PRANCŪZIJA Louis Dubois 1885 Pinot noir 2023
VOKIETIJA Ihringer Winklerberg Spätburgunder Rotwein Kabinett trocken 2022
ŠALIS (A–>Z) VYNAS
PORTUGALIJA Nossa Calcário Baga 2022
PRANCŪZIJA M.C. Lapierre Morgon AOC 2023
SAKARTVELAS Dakishvili Family Selection Saperavi Dry 2021
SAKARTVELAS Napheri Elegance Saperavi Dry 2022
AUSTRIJA W. Haider Attila Vintage Cuvée
ŠALIS (A–>Z) VYNAS
VOKIETIJA Anselmann Riesling Eiswein 2018
VOKIETIJA Jacob Faber Minheimer Güntersley Riesling Spätlese 2022
Sidabro medalių laimėtojai VYNAS
Valdouro Tawny 10y
PLATINTOJAS
Sidabro AMBER DISTRIBUTION LITHUANIA
Sidabro IKI
Sidabro PRIKĖ LIETUVA
Bronzos IKI
Bronzos NORFA (LGCF)
Bronzos RIMI
Sidabro VINO DIVINO
Sidabro VYNO KLUBAS
Sidabro DAKTARO VYNAS
Sidabro DAKTARO VYNAS
Bronzos LIVIKO
PLATINTOJAS
Sidabro PRIKĖ LIETUVA
Sidabro RIMI
PLATINTOJAS
Sidabro NORFA (LGCF)
Sidabro VYNO KLUBAS 4 4 4 4
Ramos Pinto Porto Quinta Bom Retiro 20 years
ANDRIUS DILIAUTAS
Vynmedžių auginimas Europoje turi ilgą istoriją. Daugelis vyno mėgėjų ir gamintojų vynuogininkystę laiko ypatinga meno forma. Tačiau yra ir tamsioji šios idilės pusė – kova su grybinėmis ligomis, kiekvienais metais keliančiomis iššūkių vyno gamintojams. 45-ajame „Vyno žurnalo“ numeryje apžvelgėme grybinių ligų plitimo Europoje istoriją ir tikrosios bei netikrosios miltligės simptomus, kovos ir prevencines priemones. Šiame straipsnyje tęsiame apžvalgą: pilkasis puvinys, antraknozė, juodasis puvinys. Pilkasis puvinys (lot. Botrytis cinerea). Ši grybinė liga gali atsirasti bet kuriuo vegetacijos sezono metu, tačiau vynuogės greičiausiai bus pažeistos artėjant derliaus nuėmimui, o sukėlėjas gali labai greitai įveikti visą kekę. Paukščių pažeidimai, krušos ir kitos grybelinės infekcijos taip pat gali paskatinti grybelio užkrėtimą. Dėl šios ligos gali sumažėti derlius ir pablogėti kokybė. Simptomai. Ryškiausias pilkojo (kekerinio) puvinio požymis – užkrėstų uogų paviršiuje atsiradęs pilkai rudas sporuliuojantis grybelis. Ant lapų Botrytis infekcijos simptomai pasireiškia žaliomis dėmėmis, kurios tampa rausvai rudos ir nekrozinės (negyvos). Žiedlapių simptomai atsiranda kaip rudos dėmės, kurios pajuoduoja ir dėl to gali susitraukti ir dalis nukristi. Kai subrendusios uogos yra užkrėstos, baltųjų veislių vynuogės paruduoja, o mėlynos spalvos uogos tampa violetinės spalvos.

Pilkasis puvinys, pažeidęs ‘Riesling’ veislės vynuogių kekę.
Garetho Hillo nuotrauka iš https://www.researchgate.net/figure/Typicalbotrytis-bunch-rot-symptoms-on-white-varieties-of-wine-grapes-seenhere-on_fig8_266022492

Pilkojo puvinio pažeistos mėlynos spalvos uogos.
Drew Hortono nuotrauka iš https://blog-fruit-vegetable-ipm.extension. umn.edu/2022/09/which-grape-bunch-rot-is-this.html
Kovos priemonės Kadangi pagrindinis naujų ligos sporų šaltinis yra senos vynmedžių dalys, labai svarbu gerinti sanitarines sąlygas. Tinkamas genėjimas vegetacijai pasibaigus ir pažeistų ūglių, kekių ir kitų augalo dalių sunaikinimas gali žymiai sumažinti pirminio inokuliato (sporų) kiekį. Be to, lapijos tvarkymas sezono metu gali pagerinti vėdinimą, o tai sumažina drėgmę. Tokios praktikos, kaip tvarkingas ūglių išdėstymas ir laiku sumažintas lapų kiekis aplink kekes padės gerai gerai cirkuliuoti oriui ir neleis kauptis drėgmei. Taip pat gali būti naudojami fungicidai. Jei fungicidą reikia naudoti artėjant derliaus nuėmimui, nepamirškite patikrinti, kiek laiko likus iki derliaus nuėmimo jis leidžiamas naudoti.
Renkantis veisles, svarbu atkreipti dėmesį į jų kekių aprašymą, nes veislės tankiomis kekėmis yra daug jautresnės šiai ligai nei veislės retesnėmis kekėmis. Odelės storumas taip pat turi įtakos.
Šios priemonės kartu su griežta orų stebėsena ir tinkama vynuogių priežiūra gali sumažinti grybinių ligų poveikį ir užtikrinti kokybišką vyną daugelį metų iš eilės.
Retesnės, bet taip pat pavojingos grybinės ligos, kurios gali greitai pasiekti (o gal jau ir pasiekė) ir Lietuvą
Antraknozė (lot. Elsinoe ampelina, angl. Anthracnose)
Vynuogių antraknozė, kurią sukelia grybas Elsinoe ampelina, yra rimta namuose auginamų vynuogių liga. Jis taip pat dažnai vadinamas paukščio akies puviniu dėl išskirtinių dėmių ant uogų. Liga pražūtingiausia drėgnu šiltuoju metų laiku.

Antraknozė ant žalio vynmedžio ūglio.
Nuotrauka iš https://ohioline.osu.edu/factsheet/plpath-fru-15)

Antraknozės pažeistas vynmedžio lapas.
Nuotrauka iš https://ohioline.osu.edu/factsheet/plpath-fru-15)

Antraknozės pažeistos vynuogės.
Nuotrauka iš https://ohioline.osu.edu/factsheet/plpath-fru-15)
Be įprastų, jau paminėtų profilaktinių priemonių, kovai su antraknoze rekomenduojama - anksti pavasarį, dar neišsprogus pumpurams, nupurkšti vynmedžius skystu kalkių sieros tirpalu, o vegetacijos periodu naudoti fungicidus lapams.
Juodasis puvinys (lot. Guignardia bidwellii, angl. Black Rot)
2023 m. ši liga gana smarkiai išplito PIWI veisles auginančiuose Vokietijos ir Lenkijos vynuogynuose, nustebindama vietos vynuogininkus. Tad mūsų vynuogininkams reiktų būti budriems ir stebėti, ar šios grybinės ligos simptomų neatsiras ir Lietuvos vynuogynuose.














VYNO IR KITŲ GĖRIMŲ PROFESIONALAMS
www.vynozurnalas.lt
Nr. 46. Leidžiamas nuo 2005 m. gegužės mėn. Kitas numeris bus išleistas 2025 m. gegužės mėn. Kasdien apie vyną skaitykite www.vynozurnalas.lt
El. paštas: info@vynozurnalas.lt
Adresas: Stumbrų g. 15 Vilnius, LT-08101
VYR. REDAKTORIUS
Arūnas Starkus tel. 8 698 34 297 starkus@vynozurnalas.lt
DIZAINERIS IR MAKETUOTOJAS
Tadas Šaučiulis
AUTORIAI
Agnė Dovydaitytė, Arūnas Starkus, Paulius Kovas, Andrius Diliautas, Ieva Elvyra Kazakevičiūtė, Vladas Liepuonius, Vaidotas Puklevičius, Karolina Buivydaitė, Linas Vaitulevičius
KALBOS REDAKTORĖ Asta Žūkaitė asta@vynozurnalas.lt
VIRŠELIO AUTORIAI
Tadas Šaučiulis
FOTOGRAFIJOS, ŽEMĖLAPIAI, PIEŠINIAI
Ann C., Agnė Dovydaitytė, Vygintas Skaraitis, Robertas Daskevičius, Arūnas Starkus, Urtė Budnikaitė, Asta Žūkaitė, Andrius Diliautas, Vytautas Kratulis, Modestas Vitkauskas, 30 geriausių restoranų, Baltic Wine & Drinks Awards, Lietuvos someljė asociacija, ASI – Tarptautinė someljė asociacija, Karolina Buivydaitė, Domas Burnickis, Arūnė Verbickaitė, Loïc Terrier, Vladas Liepuonius, Vidas Dovydaitis
LEIDĖJA
VšĮ „Vyno dienos“ ISSN 1822-2153
PLATINIMAS IR NE ALKOHOLIO REKLAMA info@vynozurnalas.lt , tel. (8 5) 215 94 39
SPAUDA
UAB „StepArc”
TIRAŽAS
1500 egz.
Redakcija už reklamos turinį neatsako. Perspausdinti kurį nors straipsnį, paveikslą ar nuotrauką galima tik gavus rašytinį redakcijos sutikimą.

